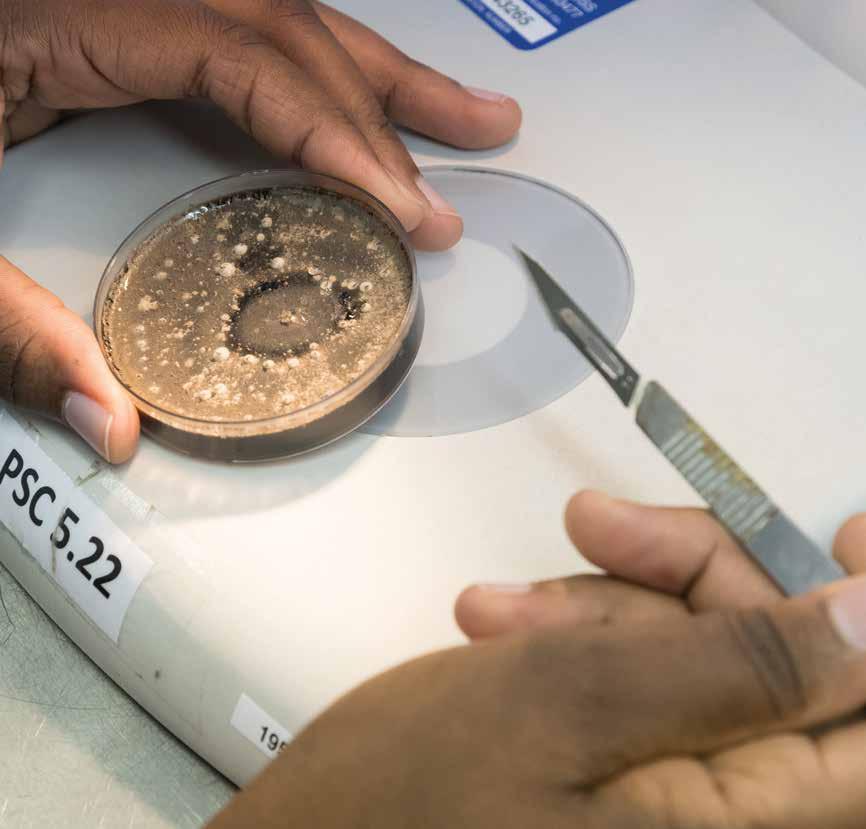

The University of Pretoria congratulates our academics on exceptional academic achievement in 2016.





![]()













The University of Pretoria congratulates our academics on exceptional academic achievement in 2016.





Professor Ulrike Kistner
Professor Kobus Maree
Dr William McCluskey
Professor Anita Michel
Professor Charles Ngwena
Professor Fransjohan Pretorius
Professor Vasu Reddy
Professor Linda Theron
C-rated researchers | C-gegradeerde navorsers | Banyakišiši bao ba lekaneditšwego go C
Professor Joe Amadi-Echendu
Professor Mohammad Arashi
Professor Christiaan Bezuidenhout
Professor Paulette Bloomer
Dr Ida Breed
Professor Molly Brown
Professor Evans Chirwa
Professor Paxie Chirwa
Professor Margaret Chitiga-Mabugu
Professor Ignacy Cukrowski
Professor Carina de Villiers
Dr Gerrie du Rand
Professor Elsa du Toit
Professor Johann Engelbrecht
Professor Andrie Garbers-Craig
Dr Marnus Gouse
Professor Ansie Harding
Professor Chaya Herman
Professor Sarah Howie
Dr Schalk Human
Dr Nazir Ismail
Professor André Jordaan
Professor Johan W Joubert
Professor Kerstin Krüger
Dr Wubetu Legesse
Professor Jurie le Roux
Professor Goedele Louwagie
Dr Heike Lutermann
Professor Jan Malherbe
Professor Ncholu Manyala
Professor David Maree
Professor Zitha Mokomane
Professor
Professor Marinda Oosthuizen
Professor
Professor
Y-rated researchers | Y-gegradeerde navorsers | Banyakišiši bao ba lekaneditšwego go Y



The UP Academic Achievers Awards has become an annual gala event to pay tribute to our staff who have excelled in their contribution to the University’s academic mission. This year’s awards have a special significance as 2016 was a particularly challenging year for South African universities. Student protests across the higher education sector meant that academics had to show exceptional resilience and innovation to ensure that students could complete their academic year whilst continuity in research and community service was maintained.
The issues brought to the fore in the national student protests have a uniquely SA manifestation but universities in many parts of the world are grappling with major issues such as dwindling public funding, political challenges and the growth of institutions of dubious quality. In what many describe as a “post-truth” society characterized by fake news, intolerance and anti-intellectualism, it is imperative that universities are strong beacons of rational thought, scientific rigour and academic excellence.
Within this complex and challenging context, UP has developed a new strategic plan to guide the implementation of the University’s vision, UP 2025, for the next five years from 2017 to 2021. The new strategic plan adheres to the University’s long-term vision but recognises that the key drivers that will underpin the University’s success in navigating the current landscape are responsiveness and agility, entrepreneurship and innovation, partnerships, and most important of all committed, dedicated high quality staff. Each academic featured in this year’s Awards has made a sterling contribution to taking us closer to realising our vision.
On behalf of the University community, I wish to congratulate all our Academic Achievers and I wish to express my heartfelt appreciation for your significant contribution to the University of Pretoria’s reputation for academic excellence.
Die UP Akademiese Presteerderstoekennings het ’n jaarlikse galageleentheid geword om hulde te bring aan ons personeel wat uitmunt in hul bydrae tot die Universiteit se akademiese missie. Vanjaar se toekennings het spesiale betekenis aangesien 2016 ’n besonder uitdagende jaar vir Suid-Afrikaanse universiteite was. Studenteproteste dwarsdeur die hoëronderwyssektor het beteken dat akademici uitsonderlike veerkrag en innovasie aan die dag moes lê om te verseker dat studente hul akademiese jaar kon voltooi terwyl deurlopendheid in navorsing en gemeenskapsdiens gehandhaaf is.
Die kwessies wat in die landswye studenteproteste na vore gebring is, het ’n uniek SA manifestasie, maar universiteite in baie dele van die wêreld worstel met knellende kwessies soos dalende staatsbefondsing, politieke uitdagings en die groei van instellings van twyfelagtige kwaliteit. In wat beskryf kan word as ’n “nawaarheidsamelewing” wat deur vals nuus, onverdraagsaamheid en anti-intellektualisme gekenmerk word, is dit gebiedend dat universiteite sterk bakens van rasionele denke, wetenskaplike nougesetheid en akademiese uitnemendheid moet wees.
In hierdie komplekse en uitdagende konteks het UP ’n nuwe strategiese plan ontwikkel om die implementering van die Universiteit se visie, UP 2025, vir die volgende vyf jaar vanaf 2017 tot 2021 te rig. Die nuwe strategiese plan hou by die Universiteit se langtermynvisie maar erken dat responsiwiteit en aanpasbaarheid, entrepreneurskap en innovasie, vennootskappe en, die belangrikste van alles, vasberade en toegewyde hoëkwaliteitpersoneel die kerndrywers is wat die Universiteit se sukses op sy pad deur die huidige landskap sal bepaal. Elke akademikus wat in vanjaar se Toekennings vereer word, het ‘n skitterende bydrae gelewer om ons nader aan die verwesenliking van ons visie te bring.
Namens die Universiteitsgemeenskap wens ek al ons Akademiese Presteerders geluk en betuig ek my diepe waardering vir u beduidende bydrae tot die Universiteit van Pretoria se reputasie vir akademiese uitnemendheid.
Difoka tša Bakgoni ba Thuto di fetogile moletlo wa gala wa ngwaga le ngwaga go hlompha badirišani ba rena bao ba šomilego gabotse kudu ka go kgatha tema ga bona go maikemišetšo a thuto a UP. Difoka tša ngwaga wo di na le bohlokwa bja go ikgetha ka ge 2016 e be e le ngwaga wa ditlhohlo go diyunibesithi tša Afrika Borwa. Boipelaetšo bja baithuti go phatlalala le lekala la thuto ya godimo bo ra gore dirutegi di swanetše go bontšha bokgoni bja go ikgetha le kaonafatšo go kgonthiša gore baithuti ba fetša ngwaga wa bona wa dithuto mola go tšwetšopele ya dinyakišišo le ditirelo tša setšhaba le tšona di tšwela pele.
Dilo tšeo di tšweleditšwego mo boipelaetšong bja baithuti bja setšhaba di tšweletša ditiragalo tša go ikgetha tša Afrika Borwa eupša diyunibesithi mo dikarolong tše dintši tša lefase di šogana le dilo tše dikgolo go swana le go fokotšwa ga thekgo ya mašeleng a setšhaba, ditlhohlo tša dipolotiki le kgolo ya diinstitušene tša boleng bja go gonontšha. Go seo ba bantši ba se hlalošago bjalo ka setšhaba sa “ka morago ga nnete” seo se laetšwago ke ditaba tšeo e sego tša nnete, go se kgotlelelane le twantšho ya bohlalefi, go bohlokwa gore diyunibesithi di be mehlala ye maatla ya kgopolo, tlhokomelo ya godimo ya saense le bokgoni bja thuto.
Ka gare ga maemo a mathata a ditlhohlo, UP e dirile thulaganyo ya peakanyo ye mpsha go hlahla tirišo ya pono ya Yunibesithi, UP 2025, mo mengwageng ye mehlano go tloga ka 2017 go fihla ka 2021. Thulaganyo ya peakanyo ye mpsha e latela pono ya nako ye telele eupša e lemoga gore dikhuetšo tše dikgolo di tla thekga katlego ya Yunibesithi ka go laetša ponagalo ya naga ya gonabjale di lemogwa le go ba le bokgoni bja go nagana le go kwešiša ka lebelo, botsebakgwebo le kaonafatšo, ditirišano, le se bohlokwa kudu go tše ka moka badirišani ba go ikgafa, ba maikemišetšo gape ba boleng bja godimo. Serutegi se sengwe le se sengwe seo se lego gona Difokeng tša ngwaga wo se kgathile tema ye kgolo kudu go re batametša go pono ya rena.
Legatong la setšhaba sa Yunibesithi, Ke rata go lebogiša Bakgoni ba Thuto ka moka gomme ke rata go leboga go tšwa boteng bja pelo ya ka tema ye bohlokwa ye le ikgathilego go tsebegeng ga Yunibesithi ya Pretoria ka bokgoni bja thuto.

Current service: Special Advisor to the South African Minister of Science and Technology, Chancellor of the University of the Free State, Chairman of the Boards of Directors of Tiger Brands Limited and AECI Limited, non-executive director on boards of Afrox Limited and Hans Merensky Holdings (Pty) Ltd, as well as President of the Hans Merensky Foundation.
Previous service: President/CEO of the Foundation of Research Development (1992-1999), President/CEO of the successor National Research Foundation (1999-2006) and Founding President of the Academy of Science of South Africa. He served on numerous structures advising various South African ministers on research, science, higher education and skills development. Notable among these were Chairman of the National Skills Authority, Convener of the Council on Higher Education (CHE) Task Force on Academic Freedom, Institutional Autonomy and Public Accountability in South African Higher Education and Deputy Convener of CHE Task Force on a New Shape and Size of the Higher Education System in South Africa. He represented South Africa on the executive board of UNESCO (1997-2001). In these capacities he was a key player in setting the strategic direction for the emerging democratic South Africa. International roles include Vice-President: Scientific Planning and Review of the International Council for Science (ICSU) (2005-2008) and service to UNESCO to assist the Caribbean Community with structuring their research, science, technology and innovation systems. He currently facilitates merger discussions between ICSU and the International Social Sciences Council as they deliberate on the best global institutional arrangements to ensure that all domains of science contribute maximally to finding solutions to the serious challenges that currently confront humanity in order to ensure a sustainable future. In addition, Dr Mokhele is currently co-chairperson of an Organisation for Economic Co-operation and Development Expert Group on Science Advice during Trans-National Crises.
His recognition awards include the Legion of Honour (Chevalier) awarded by the President of France, honorary doctorates from eight South African institutions as well Rutgers University, USA, a Science Diplomacy Award presented by the Minister of Science and Technology, a Technology Top 100 Lifetime Achievers Award and a National Science and Technology Forum Award.
Huidige diens: Spesiale Adviseur vir die Suid-Afrikaanse Minister van Wetenskap en Tegnologie, Kanselier van die Universiteit van die Vrystaat, Voorsitter van die Direksies van Tiger Brands Beperk en AECI Beperk, nie-uitvoerende direkteur op die direksies van Afrox Beperk en Hans Merensky Holdings (Edms) Bpk, asook die President van die Hans Merensky-stigting.
Vorige diens: President/HUB van die Stigting vir Navorsingsontwikkeling (1992-1999), President/HUB van die opvolger Nasionale Navorsingstigting (1999-2006) en Stigterspresident van die Wetenskapakademie van Suid-Afrika. Hy het op verskeie strukture gedien wat ʼn aantal Suid-Afrikaanse ministers geadviseer het oor navorsing, wetenskap, hoër onderwys en vaardigheidsontwikkeling. Die bekendste hiervan was Voorsitter van die Nasionale Vaardigheidsgesag, Sameroeper van die Raad op Hoër Onderwys (RHO) Taakmag oor Akademiese Vryheid, Institusionele Outonomiteit en Openbare Aanspreeklikheid in Suid-Afrikaanse Hoër Onderwys en vise-sameroeper van die RHO Taakmag oor ʼn Nuwe Vorm en Grootte van die Hoëronderwysstelsel in Suid-Afrika. Hy het Suid-Afrika op die uitvoerende raad van UNESCO verteenwoordig (1997-2001). In hierdie hoedanighede was hy ʼn sleutelrolspeler om die strategiese rigting vir die ontluikende demokratiese Suid-Afrika te bepaal. Internasionale rolle sluit in Vise-President: Wetenskaplike Beplanning en Hersiening van die Internasionale Wetenskapraad (ICSU) (2005-2008) en diens aan UNESCO om hulp aan die Karibiese Gemeenskap te verleen met die strukturering van hulle navorsing, wetenskap, tegnologie en innovasiestelsels. Hy fasiliteer tans samesmeltingsgesprekke tussen ICSU en die Internasionale Raad vir Sosiale Wetenskappe wat beraadslaag oor die voordeligste wêreldwye institusionele reëlings wat sal verseker dat alle wetenskapvelde maksimaal bydra tot die vind van oplossings vir ernstige uitdagings wat die mensdom tans in die gesig staar ten einde ʼn volhoubare toekoms te verseker. Dr Mokhele is voorts ook die medevoorsitter van ʼn Ekspertwerkgroep van die Organisasie vir Ekonomiese Samewerking en Ontwikkeling oor Wetenskapadvies tydens Transnasionale Krisisse.
Toekennings wat erkenning verleen aan dr Mokhele se diens sluit in die Erelegioen (Ridder) van die President van Frankryk, eredoktorsgrade van agt Suid-Afrikaanse instansies en Rutgers Universiteit, VSA, ʼn Wetenskapdiplomasietoekenning van die Minister van Wetenskap en Tegnologie, ʼn Tegnologie Top 100 Leeftydpresteerder-toekenning en ʼn Nasionale Wetenskap en Tegnologieforum-toekenning.
Mošomo wa gonabjale: Moeletši wa Go ikgetha wa Tona ya Saense le Theknolotši, Mokhanseliri wa Yunibesithi ya Free State, Modulasetulo wa Diboto tša Balaodibagolo ba Tiger Brands Limited le AECI Limited, molaodimogolo yo a sego taolong mo botong ya Afrox Limited le Hans Merensky Holdings (Pty) Ltd, gammogo le Mopresidente wa Motheo wa Hans Merensky.
Mešomo ya maloba: Mopresidente/Mohlankedimogolophethiši wa Motheo wa Tšweletšopele ya Dinyakišišo (1992-1999), Mopresidente wa mohlatlami wa Motheo wa Dinyakišišo wa Setšhaba (1999-2006) le Mopresidente yo a Thomilego Akademi ya Saense ya Afrika Borwa. O šomile dibopegong tše mmalwa a eletša ditona tša go fapana tša Afrika Borwa ka ga dinyakišišo, saense, thuto ya godimo le tšweletšopele ya mabokgoni. Se bohlokwa gare ga tše ke gore e bile modulasetulo wa Taolo ya Mabokgoni ya Setšhaba, Mmitšapitšo wa Sehlophatšhomo sa Tokologo ya Thuto sa Khansele ya Thuto ya Godimo (Council on Higher Education (CHE)), Go ikema ga Diinstitušene le Go ikarebela ga Setšhaba mo Thutong ya Godimo ka Afrika Borwa le Motlatšammitšapitšo wa Sehlophatšhomo sa CHE ka ga Sebopego se Sefsa le Bogolo bja Mokgwa wa Thuto ya Godimo ka Afrika Borwa. O emetše Afrika Borwa mo botong ya taolo ya UNESCO (1997-2001). Mo mešomong ye e be e le ketapele ka go beakanya taetšo ye e rulagantšwego ya Afrika Borwa ya temokrasi ye e sa golago.Mešomo ya ditšhabatšhaba e akaretša Motlatšamopresidente: Peakanyo ya Saense le Tshekatsheko ya Khansele ya Saense ya Ditšhabatšhaba (2005-2008) gomme a thuša UNESCO go thuša Setšhaba sa Caibbean ka go beakanya mekgwa ya dinyakišišo, saense, theknolotši le kaonafatšo. Gonabjale o sepediša dipoledišano tša kopano gare ga ICSU le Khansele ya Disaense tša Leago tša Ditšhabatšhaba ka ge di dirwa ka tlhokomelo ka dipeakanyo tše dibotse go feta ka moka tša diinstitušene tša lefase go kgonthiša go swarelela ga nako ye e tlago. Go tlaleletša, gonabjale Ngaka Mokhele ke modulasetulommogo wa Mokgatlo wa Tirišano ya Ekonomi le Sehlopha sa Ditsebi tša Tšweletšopele ka ga Maele a Saense nakong ya Dikhuduego tša Ditšhabantši.
Difoka tša gagwe tša temogo di akaretša Sefoka se segolo go feta ka moka sa Mašole le sa Selegae sa Tlhompho (Legion of Honour) (Chevalier) seo se abilwego ke Mopresidente wa France, bongaka bja tlhompho go tšwa diinstituteng tše seswai tša Afrika Borwa gammogo le Yunibesithi ya Rutgers, USA, Sefoka sa Botseta bja Saense seo se abilwego ke Tona ya Saense le Theknolotši, Sefoka sa Bakgoni ba Theknolotši ba Godimo ba 100 sa Bophelo ka Moka le Sefoka sa Foramo ya Theknolotši le Saense tša Setšhaba.

PhD in Microbiology | University of California Davis
PhD in Mikrobiologie | Universiteit van Kalifornië, Davis
PhD in Microbiology | Yunibesithi ya California Davis
The Chancellor’s Award is made in recognition of exceptional achievement in teaching and learning and excellence in education innovation at the University of Pretoria.
Die Kanseliersmedalje word toegeken as erkenning vir buitengewone prestasie in onderrig en leer en uitnemendheid in leerinnovasie aan die Universiteit van Pretoria.
Sefoka sa Motlatšamokhanseliri se dirilwe go lemoga bokgoni bja go ikgetha ka Go ruta le Go ithuta, le bokgoni bja tšwelotšopele ya thuto mo Yunibesithing ya Pretoria.

Chancellor | University of Pretoria
Kanselier | Universiteit van Pretoria
Mokanseliri | Yunibesithi ya Pretoria


Chancellor’s Award | Teaching and Learning
Kanseliersmedalje | Onderrig en Leer Sefoka sa Mokhanseliri | Go ruta le Go ithuta
Professor Hanekom is a full professor in the Department of Electrical, Electronic and Computer Engineering in the Faculty of Engineering, Built Environment and Information Technology. She is recognised for her contribution to the development and practice of excellence and innovation in engineering teaching and learning.
Her journey in teaching and learning started when she was appointed at UP in 1999. In 2005 she was put in charge of the third year microcontrollers module. With the explosive growth in embedded technology over the past decades, she recognized the need to equip students with more than just a theoretical knowledge of microcontroller systems. She developed a teaching and learning strategy that cultivates a hands-on practical knowledge of microcontroller systems supported by a firm theoretical foundation. Innovations include, among others, the development of a unique programmatic electronic grading system to support teaching and learning of assembly language, a computerized tutoring system based on this e-grading system, the introduction, development and presentation of the annual robot car race day which is both an academic extension of the microcontrollers teaching and learning strategy and a widely published marketing event that promotes engineering as a career option to male and female candidates alike. The event is strongly supported by local and international industry partners. Her efforts in teaching and learning culminated in several awards in 2015, such as a laureate in the UP Excellence and Innovation in Teaching Awards, the EBIT Faculty Teaching Award and the Council on Higher Education (CHE)/Higher Education Learning and Teaching Association of South Africa (Heltasa) National Teaching Award. She was appointed as the function head for undergraduate studies in the Department EECE in February 2015. She is a member of the Faculty’s teaching and learning committee and served on the UP2025 task team for teaching and learning. Professor Hanekom is also an internationally recognized researcher in biomedical engineering, specifically computational physiology of peripheral auditory neural excitation in cochlear implants. Her work focuses on translation of computational models of cochlear implants to clinical tools, eg model-based diagnostics to address complications such as facial nerve stimulation, and high-resolution model-based visualization of the cochleae of specific users based on low-resolution clinical computed tomography images.
She is married to Professor Johan Hanekom, and together they form one of the husband and wife research teams at the University of Pretoria. The couple has three children: Natalie, Johan and Chantal. Professor Hanekom holds provincial colours in masters athletics for the 100 m sprint and long jump events.
Professor Hanekom is ʼn professor in die Departement van Elektriese, Elektroniese en Rekenaar-ingenieurswese in die Fakulteit Ingenieurswese, Bou-omgewing en Inligtingstegnologie. Sy ontvang erkenning vir haar bydrae tot die ontwikkeling en beoefening van uitnemendheid en innovasie in die onderrig en leer van ingenieurswese.
Haar bemoeienis met onderrig en leer het begin toe sy in 1999 by die Universiteit van Pretoria aangestel is. In 2005 is sy in beheer van die derdejaar mikrobeheerdermodule geplaas. Met die eksponensiële groei van ingebedde tegnologie oor die afgelope paar dekades het sy besef dat daar ʼn behoefte is om student toe te rus met meer as net teoretiese kennis van mikrobeheerderstelsels. Sy het ʼn onderrig- en leerstrategie vir die bevordering van praktiese kennis van mikrobeheerderstelsels, ondersteun deur ʼn stewige teoretiese begronding, ontwikkel. Innoverings sluit onder andere die ontwikkeling in van ʼn unieke programmatiese elektroniese merkstelsel om die onderrig en leer van saamsteltaal te ondersteun, ʼn gerekenariseerde tutorstelsel gebaseer op hierdie e-merkstelsel, en die bekendstelling, ontwikkeling en aanbieding van die jaarlikse mikrobeheerde karretjieresies wat beide ʼn akademiese verlengstuk van die mikrobeheerder onderrig- en leerstrategie en ʼn wydgepubliseerde bemarkingsgeleentheid is wat ingenieurswese as ʼn beroepsopsie vir mans- sowel as vroue- studente bevorder. Hierdie geleentheid word sterk ondersteun deur plaaslike en internasionale industrievennote. Haar werk in onderrig en leer het in 2015 tot verskeie toekennings, soos ʼn UP Uitnemendheid en Innovering in Onderwys-toekenning, die EBIT-Fakulteitsonderrigtoekenning en ‘n Council on Higher Education (CHE)/Higher Education Learning and Teaching Association of South Africa (Heltasa) National Teachingtoekenning gelei. Sy is in Februarie 2015 aangestel as die funksiehoof vir voorgraadse studies in die Departement Elektriese, Elektroniese en Rekenaar-ingenieurswese. Sy is ʼn lid van die Fakulteit se onderrig- en leerkomitee en het op die UP2025 taakspan vir onderrig en leer gedien. Prof Hanekom geniet ook internasionale erkenning as navorser in die veld van biomediese ingenieurswese, spesifiek rekenaarfisiologie van die periferale-ouditiewe neurale prikkeling in kogleêre inplantings. Haar werk fokus op die omskakeling van rekenaarmodelle van kogleêre inplantings na kliniese hulpmiddele, bv modelgebaseerde diagnostiek om komplikasies soos gesigsenuweestimulasie aan te spreek, en hoë-resolusie modelgebaseerde visualisering van die kogleas van spesifieke gebruikers gebaseer op lae resolusie kliniese rekenaartomografiebeelde.
Sy is getroud met prof Johan Hanekom, en saam is hulle een van die man-en-vrounavorsingspanne by die Universiteit van Pretoria. Hulle het drie kinders: Natalie, Johan en Chantal. Prof Hanekom het provinsiale kleure in meestersatletiek vir die 100 m-naelloopen verspringitems.
Profesa Hanelom ke profesa ka Kgorong ya Boentšenere bja Khomphutha, Mohlagase le Elektroniki ka Lefapheng la Boentšenere, Tikologo ya Kago le Theknolotši ya Tshedimošo. O lemogwa go tema ye a e kgathilego ka kaonafatšong le tirišong ya bokgoni le tšweletšopele ka go ruteng le go ithuteng boentšenere.Leeto la gagwe ka go ruteng le go ithuteng le thomile ge a thwalwa mo UP ka 1999. Ka 2005 o filwe maikarabelo a thutwana ya dimaekrokhontrola ya ngwaga wa boraro. Ka baka la go gola ka lebelo ga theknolotši ye e agilwego mo dipakeng tša go feta, o lemogile tlhokego ya go matlafatša baithuti ka tsebo ya go feta ya molomo fela ya mekgwa ya dimaekrokhontrola. O kaonafaditše mokgwa wa go ruta le go ithuta woo o hlohleletšago tsebo ya tirišo ya go kgatha tema ya mekgwa ya dimaekrokhontrola yeo e thekgwago ke motheo wa molomo wo o tiilego. Ditšweletšopele di akaretša, gare ga tše dingwe, tšweletšopele ya mokgwa wa tekanyo ya elektroniki wa lenaneo la moswananoši go thekga go ruta le go ithuta la polelo ya khomphutha, mokgwa wa go ruta wo o theilwego go mokgwa wo wa e-grading, matseno le kabo ya letšatši la go šiišana ga difatanaga tša diroboto la ngwaga le ngwaga yeo e lego bobedi katološo ya thuto ya mekgwa ya go ruta le go ithuta tiragalo ya papatšo ye e phatlaladitšwego ka bophara yeo e godišago boentšenere bjalo ka kgetho ya mošomo go balekwa ba basadi le ba banna go swana. Tiragalo e thekgwa kudu ke badirišani ba intasteri ba gae le ba ditšhabatšhaba.
Maitapišo a gagwe mo go ruteng le go ithuteng go dirile gore a hwetše difoka tše mmalwa ka 2015, go swana le laureate ka go Difoka tša Bokgoni le Tšweletšopele ka Go ruteng tša UP, Sefoka sa Go ruta sa Lefapha sa EBIT le Sefoka sa Go ruta sa Setšhaba sa Khansele ya Thuto ya Godimo (CHE)/Mokgatlo wa Go ruta le Go ithuta wa Thuto ya Godimo wa Afrika Borwa (Heltasa). O thwetšwe bjalo ka hlogo ya mošomo wa dithuto tša boithutelatikrii ka Kgorong ya EECE ka Dibokwane 2015. Ke leloko la komiti ya go ruta le go ithuta ya Lefapha gomme o thušitše ka go sehlophatšhomo sa UP2025 sa go ruta le go ithuta. Profesa Hanekom ke gape monyakišiši yo a lemogwago ditšhabatšhabeng ka boentšenere bja kalafo ya thutaphedi, kudu fisiolotši ya khomphutha ya tirišo ya maatla mo megalatšhikeng ya ka ntle ga tsebe ka go sedirišwa sa go kwa. Mošomo wa gagwe o nepiša phetolelo ya memotlolo ya khomphutha ya sedirišwa sa go kwa go sedirišwa sa kalafo, mohlala, phekolo ye e theilwego go mmotlolo go šogana le ditharagano tša go swana le tlhohleletšo ya megalatšhika ya sefahlego, le pono ya mmotlolo wo o theilwego go pontšho ye kgolo ya kgopanatsebe ye e theilwego go mošomiši yo a itšego go diswantšho tša mmele tša kalafo tšeo di dirwago ke khomphutha tša pontšho ye nnyane.
O nyalane le Profesa Hanekom, gomme bobedi ba dira yengwe ya dihlopha tša dinyakišišo tša mohuta tša monna le mosadi mo Yunibesithing ya Pretoria. Balekane ba ba na le bana ba bararo, Natalie, Johan le Chantal. Profesa Hanekom o na le mebala ya profense ka diatletiki ya ditiragalo tša go kitima tša 100 m le ditabo.

The University of Pretoria introduced the Vice-Chancellor’s Book Awards to recognise and reward authors of scholarly books, monographs and collections. The prizes are awarded once a year in two categories, namely humanities and social sciences (broadly defined) and natural and applied sciences. In 2016 only one award, in the humanities and social sciences, was made. A book is considered to be scholarly if it presents the findings of an original, systematic investigation undertaken to gain new knowledge and insight, advances knowledge in a particular discipline and brings credit to the University. Scholarly books may be written in any of South Africa’s official languages and translations of major works originally published in other languages are also considered. In order to qualify for nomination, books should bring credit to the University on account of their contribution to the advancement of the humanities, the social sciences or the natural and applied sciences.
Die Universiteit van Pretoria het die Visekanselier se Boektoekennings ingestel om skrywers van vakkundige boeke, monografieë en versamelings te beloon. Die pryse word een keer per jaar in twee kategorieë toegeken, naamlik die geestes- en sosiale wetenskappe (breed gedefinieer) en die natuuren toegepaste wetenskappe. In 2016 is net een toekenning, in die geestes- en sosiale wetenskappe, gemaak. ʼn Boek word as vakkundig beskou as dit die bevindings van ʼn oorspronklike, stelselmatige ondersoek aanbied wat gedoen is om nuwe kennis en insig te bekom, kennis op ʼn bepaalde vakgebied uitbrei en die Universiteit eer besorg. Vakkundige boeke kan in enige van Suid-Afrika se amptelike tale geskryf wees en vertalings van belangrike werke wat oorspronklik in ander tale uitgegee is, word ook oorweeg. Om vir benoeming in aanmerking te kom, moet boeke die Universiteit tot eer strek op grond van hul bydrae tot die vooruitgang van die geestes- en sosiale wetenskappe of die natuur- en toegepaste wetenskappe.
Yunibesithi ya Pretoria e tsebagaditši Difoka tša Dipuku tša Motlatšamokhanseliri go lemoga le go leboga bangwadi ba dipuku tša thuto, ditaodišo le dikgoboketšo. Difoka di abja gatee mo ngwageng ka magoro a mabedi, e lego, la bomotho le disaense tša leago (le hlalošwa ka bophara) le disaense tša tlhago le tirišo. Ka 2016 go abilwe sefoka se tee, ka bomothong le disaense tša leago. Puku e tšewa go ba ya thuto ge e tšweletša dikutollo tša mathomong, dinyakišišo tša peakanyo di dirilwe go hwetša tsebo ye mpsha le kwešišo, tsebo ye e tšweletšego mo karolong ye e itšego gomme ya tumiša Yunibesithi. Dipuku tša thuto di ka ngwalwa ka dipolelo tša semmušo tša Afrika Borwa gomme diphetolelo tša mošomo wo mogolo woo mathomong o phatlaladitšwego ka dipolelo tše dingwe le tšona di a lebeledišišwa. Gore o be le maswanedi a go kgethwa, dipuku di swanetše go tumiša Yunibesithi mo go tšeeng karolo ga yona go tšweletšopele ya bomotho, disaense tša leago goba disaense tša tlhago le tirišo.



Vice-Chancellor’s Book Award 2016 Visiekanselier se Boektoekenning 2016
Difoka tša Puku tša Motlatšamokhanseliri tša 2016
The award for the Humanities and Social Sciences is made to Professor Charles van Onselen for his book titled: Showdown at the Red Lion: the Life and Times of Jack McLoughlin
Citation:
As is true for a number of his books, Charles van Onselen manages to find titles that suggest that the reader is about to enjoy a novel. This is entirely appropriate, as his meticulous research and deep historical knowledge are matched by an elegance and fluidity of style and writing that turn serious historical issues into compelling reading. Although he is central to the book, Showdown at the Red Lion is much more than the life story of Jack McLoughlin. It is a history of a critical period in nineteenth century Johannesburg and an exhaustive investigation that covers the length and breadth of Britain’s imperialist adventures, from William Blake’s “dark Satanic Mills” of the 1850s industrial Manchester to the Australian outback via the goldfields of the Witwatersrand. This is a history which foregrounds uncanny, if not disquieting, parallels between the past and the present. Johannesburg remains a frontier town: McLoughlin’s act of murder was as characteristic of South Africa in the late 19th century as it is now in the early 21st century. Showdown is a brilliant and deeply revealing history whose story and implications change the way we understand our own histories.
Die toekenning vir Geestes- en Sosiale Wetenskappe gaan aan professor Charles van Onselen vir sy boek getiteld: Showdown at the Red Lion: the Life and Times of Jack McLoughlin
Sitaat:
Dit kan van ʼn aantal van Charles van Onselen se boeke gesê word dat hy daarin slaag om titels te kies wat dit laat klink of die leser op die punt staan om ʼn roman te lees. Dit is heeltemal gepas, aangesien sy noukeurige navorsing en diep historiese kennis geëwenaar word deur ʼn elegante en vloeiende skryfstyl wat ernstige historiese kwessies in boeiende leesmateriaal verander. Alhoewel die hoofkarakter sentraal tot die boek staan, is Showdown at the Red Lion baie meer as die lewensverhaal van Jack McLoughlin. Dit is ʼn geskiedenis van ʼn kritieke tydperk in negentiende-eeuse Johannesburg en ʼn diepgaande ondersoek wat die lengte en breedte van Brittanje se imperialistiese avonture, van William Blake se ‘dark Satanic Mills’ van die industriële Manchester van die 1850’s tot die Australiese gramadoelas via die Witwatersrand se goudvelde. Dit is ʼn geskiedenis wat buitengewone en selfs onrusbarende parallelle tussen die verlede en die hede uitlig. Johannesburg bly ʼn grensdorp: McLoughlin se moorddaad was so eie aan Suid-Afrika van die laat 19de eeu as wat dit nou in die vroeg 21ste eeu is. Showdown is ʼn briljante en hoogs onthullende geskiedenis waarvan die storie en implikasies die manier waarop ons ons eie geskiedenisse verstaan, verander.
Sefoka sa Bomotho le Disaense tša Leago se abetšwe Profesa Charles van Onselen ka puku ya gagwe yeo thaetlele ya yona e lego: Showdown at the Red Lion: the Life and Times of Jack McLoughlin
Temana:
Bjalo ka ge e le nnete mo dipukung tša gagwe tše mmalwa, Charles van Onselen o kgonne go hwetša dithaetlele tšeo di akanyago gore mmadi o kgauswi le go ipshina ka padi. Se se tloga se le maleba, ka ge dinyakišišo tša gagwe tše di nepagetšego le tsebo ya histori ye e tseneletšego di nyalantšhwa le mokgwa wa maemo gape wa go fetoga le mongwalo wo o fetolelago ditaba tša histori tše bohlokwa go baleng moo go gogago šedi. Le ge a le bohlokwa mo pukung, Showdown at the Red Lion e feta kudu kanegelo ya bophelo bja Jack McLoughlin. Ke histori ya nako ye bohlokwa ya Johannesburg ya ngwagakgolo wa bo 19 le dinyakišišo tša botlalo tše di akaretšago botelele le bophara tša go kgahliša tša boimperiale bja Britain, go tšwa go “dark Satanic Mills” ya William Blake ya intasteri ya Manchaster ya 1850 go naga ya Australia a šomiša selete sa Witwatersrand. Ye ke histori yeo e nepišago ya go makatša, ge e sa belaetše, dipapetšo gare ga tše di fetilego le tša gonabjale. Johannesburg e dula e le toropo ya ketapele: Tiragatšo ya polao ya McLoughin e bile bjalo ka phapantšho ya Afrika Borwa morago ngwagakgolong wa bo 19 bjalo ka ge go le bjalo ka pele ka bo 21. Showdown ke histori ye botse ya go utolla ka go tsenelela yeo kanegelo le dikakanyo tša yona di fetogago ka mokgwa wo re kwešišago dihistori tša rena.


This award is made annually to senior academics who have already achieved the status of professor, are regarded highly by their peers and have consistently excelled in the areas of under- and postgraduate teaching and learning, research, community service and administration over a period of time. Any academic who has been awarded an A rating by the NRF in the year under consideration automatically qualifies as an Exceptional Achiever for as long as he or she remains an A-rated researcher.
Dié toekenning word jaarliks aan senior akademici gemaak wat reeds professorale status verwerf het, besonder hoë statuur onder hulle eweknieë geniet en oor ‘n geruime tydperk volgehoue uitnemende prestasies op die gebied van voor-en nagraadse onderrig en leer, navorsing, gemeenskapsdiens en administrasie behaal het. Enige akademikus wat deur die NNS as ‘n A-gegradeerde navorser geëvalueer is, in die jaar onder oorweging, word outomaties ‘n Uitnemende Presteerder vir so lank as wat hy of sy die status van ‘n A-gegradeerde navorser behou.
Sefoka se se abelwa bafahloši bao ba lego maemong a godimo a seakatemiki ebile ba šetše ba fihleletše maemo a boprofesa gomme ba hlompšha ke ba mephato ya bona gape ba tšwelapele go šoma ka bothakga ka magorong a go ruta le go ithuta go baithuti ba maphoskratšuweiti le go bao e sego maphoskratšuweiti, dinyakišišong, tirelong ya setšhaba le tshepedišong godimo ga nako ya go bonala. Mofahloši o mongwe le o mongwe yo a fihleletšego maemo a NRF a (A) o kgotsofatša dinyakwa tša go tsenela legoro la Moatlegi wa go Tšwelela ka Magetla ka dinako ka moka ge a ntše a le monyakišiši wa maemo a (A).

Exceptional Academic Achievers
Uitnemende Akademiese Presteerders Bašomedi bao ba Atlegilego Kudu: Diakatemiki
Professor Anguelov is professor in and Head of the Department of Mathematics and Applied Mathematics. His research is in the area of mathematical modelling, dynamical systems and the associated numerical analysis. His recent work is focused mainly on biomathematics, an interdisciplinary area comprising applications of mathematical methods and models to biological sciences, as well as new mathematical constructs and theory which are motivated by such applications.
Prof Anguelov, together with his students and collaborators, has in the past investigated dynamical system models in various areas of interest like the interdependence of population and epidemiological dynamics, pattern formation mechanisms, spread and control of fruit flies, the mating disruption method for pest insect control, and diseases at the interface with wildlife. The analysis of these models elucidates the underlying biological processes and provides threshold parameter values for bifurcations in the respective systems, which is essential for designing successful interventions. Prof Anguelov is a co-founder and editor in chief of the journal Biomath and also a main organiser of the Biomath series of conferences. He currently holds a B3 rating from NRF.
Professor Anguelov is professor in en Departementshoof van die Departement Wiskunde en Toegepaste Wiskunde. Sy navorsing is op die gebied van wiskundige modellering, dinamiese stelsels en die gepaardgaande numeriese analise. Sy huidige werk fokus hoofsaaklik op biowiskunde, ʼn interdissiplinêre studieveld wat die toepassings van wiskundige metodes en modelle op biologiese wetenskappe behels, sowel as nuwe wiskundige konstrukte en teorie wat deur sodanige toepassings gemotiveer word.
Prof Anguelov het in die verlede, in samewerking met sy studente en medewerkers, dinamiese stelselmodelle in verskeie belangstellingsvelde, soos die interafhanklikheid van bevolkings- en epidemiologiese dinamika, patroonformasiemeganismes, die verspreiding en beheer van vrugtevlieë, die paringontwrigtingsmetode vir plaaginsekbeheer en siektes op die raakvlak met wildlewe, ondersoek. Die analise van hierdie modelle verklaar die onderliggende biologiese prosesse en verskaf drumpelparameterwaardes vir bifurkasies in die onderskeie stelsels, wat onontbeerlik is vir die beplanning van suksesvolle intervensies. Prof Anguelov is ʼn medestigter en hoofredakteur van die tydskrif Biomath en ʼn hooforganiseerder van die Biomath-reeks konferensies. Hy het tans ʼn B3-gradering van die NNS.
Profesa Anguelov ke profesa le Hlogo ya Kgoro ya Mmetse le Mmetse wa Tirišo. Nyakišišo ya gagwe e ka karolong ya mmotlolo wa mmetse, mekgwa ya taenamiki le ditshekatsheko tše di amanago le dinomoro. Mošomo wa gagwe wa kgauswanyana o nepiša kudu payommetse, le dikarolo tša ditsebo tše dintši tšeo di nago le ditirišo tša mekgwa ya mmetse le mebotlolo ya go ya disaenseng tša payolotši, gammogo le dikgopolo tše difsa tša mmetse le teori tšeo di hlohleletšwago ke ditirišo tšeo.
Prof Anguelov, gammogo le baithuti ba gagwe le badirišani, mo nakong ya go feta ba nyakišišitše mebotlolo ya mekgwa ya taenamiki ka dikarolong tša go fapana tša kgahlego go swana le go tshephana gare ga batho le ditaenamiki tša epidemolotši, mekgwa ya go dira dipatrone, phatlalatšo le taolo ya dintši tša dienywa, go tshwenyana le mokgwa wa tswadišo wa taolo ya dikhunkwane tša disenyi, le malwetši mo mellwaneng ya dimedi le diphedi. Tshekatsheko ya mebotlolo ye e hlaloša ditshepetšo tša motheo gomme e fa mehola ya magomo a dikarolo mo mekgweng ye e itšego, yeo e lego bohlokwa go akanyetša ditsenogare tša katlego. Prof Anguelov ke mothomimmogo le morulaganyimogolo wa jenale ya Biomath gape ke mmeakanyimogolo wa mohlwaela wa dikhonferense tša Biomath. Gonabjale o na le tekanyetšo ya B3 go tšwa NRF.

Professor Craig is professor and Section Head: Control Systems in the Department of Electrical, Electronic and Computer Engineering, a position that he has held since 1995.
His research interests include modelling and control of process systems, with a particular focus on mineral and metal processing and utilities in the petrochemical industry, the economic performance assessment of process control and automation, and the modelling and control of disease networks.
Professor Craig was editor-in-chief of Control Engineering Practice from 2005 to 2010 and president of the International Federation of Automatic Control (IFAC) from 2011 to 2014. In 2008 he received the IFAC outstanding service award. He is a Fellow of the South African Academy of Engineering and a registered Professional Engineer in South Africa. He has thrice received an exceptional academic achiever award from the University of Pretoria, and in 2014 he was the recipient of the President’s Award from the South African Institute of Electrical Engineers. He received a B2 rating from the NRF.
Professor Craig is professor en Afdelingshoof: Beheerstelsels in die Departement Elektriese, Elektroniese en Rekenaaringenieurswese, ’n posisie wat hy sedert 1995 beklee.
Sy navorsingsbelangstellings sluit in modellering en beheer van prosesstelsels, met ’n besondere fokus op mineraal- en metaalprosessering en utiliteite in die petrochemiese bedryf, die assessering van ekonomiese prestasie van prosesbeheer en outomatisasie, en die modellering en beheer van die verspreiding van aansteeklike siektes.
Professor Craig was van 2005 tot 2010 hoofredakteur van Control Engineering Practice en van 2011 tot 2014 president van die International Federation of Automatic Control (IFAC). In 2008 het hy die IFAC se toekenning vir uitstaande diens ontvang. Hy is ’n genoot van die Suid-Afrikaanse Akademie vir Ingenieurswese en is ’n geregistreerde professionele ingenieur in Suid-Afrika. Hy het drie keer ’n toekenning as uitsonderlike akademiese presteerder van die Universiteit van Pretoria ontvang, en in 2014 was hy die ontvanger van die Presidentstoekenning van die Suid-Afrikaanse Instituut van Elektriese Ingenieurs. Hy het ’n B2-gradering van die NNS ontvang.
Profesa Craig ke profesa le Hlogo ya Karolo: Mekgwa ya Taolo ka Kgorong ya Boentšenere bja Khomphutha, Mohlagase le Elektroniki, maemo ao a a swerego go tloga ka 1995.
Kgahlego ya gagwe ya dinyakišišo e akaretša go bontšha le go laola ditšhepetšo tša mekgwa, ka nepišo ye e itšego go sepetša diminerale le dimetale le dikholo ka intastering ya dikhemikhale tša petrole, kelo ya mošomo wa ekonomi ya taolo ya tshepetšo le go itiriša, le go bontšha le go laola dinetweke tša malwetši.
Profesa Graig e bile morulaganyimogolo wa Control Engineering Practice go tloga ka 2005 go fihla ka 2010 le mopresidente wa Taolo ya Go itiriša ya Federeišene ya Ditšhabatšhaba (IFAC) go tloga ka 2011 go fihla ka 2014. Ka 2008 o amogetše sefoka sa IFAC sa tirelo ya bokgoni. Ke Modirišani wa Akademi ya Boentšenere ya Afrika Borwa le Moentšenere yo a ngwadišitšwego ka Afrika Borwa. O amogetše sefoka sa mošomedi wa akademiki yo a atlegilego kudu gararo go tšwa Yunibesithing ya Pretoria, gomme ka 2014 e bile moamogedi wa Sefoka sa Mopresidente go tšwa Institušeneng ya Boentšenere bja Mohlagase. O amogetše tekanyetšo ya B2 go tšwa NRF.

Professor Greeff is a professor in the Department of Genetics in the Faculty of Natural and Agricultural Sciences.
He is an evolutionary biologist who enjoys working out why evolution took place in the way it did. He focuses on combining the evolution of reproductive strategies and interactions among relatives. For instance, these fields are combined when researchers try to understand why certain organisms have evolved to mate with relatives. In this realm of overlap, his favourite study topic is explaining why certain organisms have evolved to have more daughters than sons. Recently, he has started work on the evolution of the virulence of parasites because this also depends simultaneously on mating strategies and genetic similarities among parasites. Apart from trying to solve these combined puzzles he has investigated problems concerning mating strategies only. One example has been to work out how frequently Afrikaner women cheated on their husbands over the past 300 years. Professor Greeff was acknowledged as an exceptional achiever in 2014 and received a B2 rating from the NRF.
Professor Greeff is ’n professor in die Departement Genetika in die Fakulteit Natuur- en Landbouwetenskappe.
Hy is ’n evolusiebioloog wat daarvan hou om uit te vind hoekom evolusie op ’n bepaalde manier plaasgevind het. Sy navorsing fokus op die kombinering van die evolusie van voortplantingstrategieë en die wisselwerking tussen bloedverwante. Hierdie terreine word byvoorbeeld gekombineer wanneer navorsers probeer verstaan hoekom sekere organismes ontwikkel het om met bloedverwante te paar. Op hierdie oorvleuelingsgebied is sy gunstelingonderwerp vir bestudering om te verduidelik hoekom sekere organismes meer dogters as seuns het. Hy het onlangs begin werk aan die evolusie van die virulensie van parasiete omdat dit ook terselfdertyd afhang van paringstrategieë en genetiese ooreenkomste tussen parasiete. Afgesien van pogings om hierdie gekombineerde raaisels op te los, ondersoek hy ook probleme rakende paringstrategieë. Een voorbeeld is om uit te werk hoe dikwels Afrikanervroue hul eggenotes oor die laaste 300 jaar verkul het. Professor Greeff is in 2014 as ’n uitsonderlike navorser erken en het ’n B2-gradering van die NNS ontvang.
Profesa Greeff ke profesa ka Kgorong ya Leabela ka Lefapheng la Disaense tša Tlhago le Temo.
Ke Mopayolotši wa ebolušene yo a ratago go šomana le ka moo ebolušene e diragetšego ka tsela ye e diragetšego ka gona. Nepo ya gagwe ya go kopanya ebolušene ya mekgwa ya tswalo le tsenelano gare ga diphedi tše di amanago. Mohlala, dikarolo tše di kopantšwe ge banyakišiši ba leka go kwešiša gore ke ka lebaka la eng diphedi di fetogile go tswadiša tše di amanago le tšona. Mo karolong ye e katološitšwego, sererwa sa gagwe sa thuto seo a se ratago kudu se hlaloša gore ke ka lebaka la eng diphedi tše dingwe di fetogile go ba le barwedi ba bantši go feta barwa. Kgauswanyana, o thomile mošomo ka ebolušene ya bošoro bja dipharasaete ka gore se se ithekgile mmogo go mekgwa ya tswadišo le ditshwano tša leabela mo go dipharasaete. Ntle le go leka go rarolla mararankodi ao a kopantšwego o nyakišišitše mathata ao a amago mekgwa ya tswadišo fela. Mohlala wo mongwe e be e le go lebelela gore ke gantši bokaakang moo basadi ba Maafrikanere ba se a tshepagalelago banna ba bona. Profesa Greeff o amogetšwe bjalo ka mošomedi yo a atlegilego kudu ka 2014 gomme o amogetše tekanyetšo ya B2 go tšwa go NRF.

Professor Meyer is professor, Head of the Department of Mechanical and Aeronautical Engineering in the Faculty of Engineering, Built Environment and Information Technology and the chairperson of the School of Engineering.
He established and leads the Clean Energy Research Unit, which has a broad focus on thermal sciences and fluid flow and a narrower focus on heat exchangers. His heat exchanger research focuses on the fundamental work of flow in the transitional flow regime, nanofluids, and condensation. His work is applied to thermal-solar, wind and nuclear energy. The Unit has approximately 50 full-time graduate students and ten staff members. Professor Meyer has established various laboratories with state-of-the-art instrumentation and designed and constructed more than 12 unique experimental set-ups in collaboration with members of his research group.
Professor Meyer has received five different national teaching awards from three universities, as well as an international teaching award. He has won more than 20 awards for best article of the year or best conference paper and numerous national and international research awards. He is a member or Fellow of various professional institutes and societies such as the American Society of Mechanical Engineers (ASME), the American Society of Heating, Refrigerating and Air-Conditioning Engineers (better known as ASHRAE), the American Institute of Aeronautics and Astronautics (AIAA), and the Royal Aeronautical Society.
He holds a B1 rating from the NRF and is a ‘highly cited researcher’ (top 1%) in engineering. He serves on the editorial board of 13 journals and as editor of seven journals. He recently served on the selection committee of the Franklin Institute Awards Program (which has been in existence since 1824 and is one of the oldest in the world) for the Benjamin Franklin Medal.
He has authored or co-authored more than 600 articles, conference papers and book chapters, and has supervised or co-supervised more than 100 research master’s and PhD students. In 2016, he won the University of Pretoria Exceptional Supervisor Award. This is the fifth time that he receives a UP exceptional achiever award.
Professor Meyer is professor en Hoof van die Departement Meganiese en Lugvaartkundige Ingenieurswese in die Fakulteit Ingenieurswese, Bou-omgewing en Inligtingtegnologie. Hy is ook die voorsitter van die Skool vir Ingenieurswese.
Hy is stigter en hoof van die Navorsingseenheid vir Skoon Energie, wat ’n breë fokus op termiese wetenskappe en vloeimeganika en ’n enger fokus op hitteruilers het. Sy hitteruilernavorsing fokus op die fundamentele werk van vloei in die oorgangsvloeiregime, nanovloeiers en kondensasie. Sy werk word op termiese-son-, wind- en kernenergie toegepas. Die Eenheid het nagenoeg 50 voltydse nagraadse studente en tien personeellede. Professor Meyer het verskeie laboratoriums met die mees gevorderde instrumentasie gevestig en meer as 12 unieke eksperimentele opsette in samewerking met lede van sy navorsingsgroep ontwerp en gebou.
Professor Meyer het vyf verskillende nasionale onderrigtoekennings van drie universiteite ontvang, asook ’n internasionale toekenning. Hy het meer as 20 toekennings vir beste artikel van die jaar of beste konferensiereferaat ontvang, asook talle nasionale en internasionale navorsingstoekennings. Hy is ’n lid of genoot van verskeie professionele institute en verenigings, soos die American Society of Mechanical Engineers (ASME), die American Society of Heating, Refrigerating and Air-Conditioning Engineers (beter bekend as ASHRAE), die American Institute of Aeronautics and Astronautics (AIAA) en die Royal Aeronautical Society.
Hy het ’n B1-gradering van die NNS en is ’n ‘hoogs aangehaalde navorser’ (boonste 1%) in ingenieurswese. Hy dien in die redaksies van 13 joernale en is of was redakteur van sewe joernale. Hy het onlangs in die keurkomitee van die Franklin Institute Awards-program (wat sedert 1824 bestaan en een van die oudstes ter wêreld is) vir die Benjamin Franklin-medalje gedien.
Hy is skrywer of medeskrywer van meer as 600 artikels, konferensiereferate en boekhoofstukke, en was studieleier of medestudieleier vir meer as 100 navorsingsmeestersgraad- en PhD-studente. In 2016 is die Universiteit van Pretoria se Toekenning vir Uitsonderlike Studieleier aan hom toegeken. Dit is die vyfde keer dat hy ’n toekenning as uitsonderlike presteerder van UP ontvang.
Profesa Meyer ke profesa le Hlogo ya Kgoro ya Boentšenere bja Semotšhene le Aeronathikhale ka Lefapheng la Boentšenere, Tikologo ya Kago le Theknolotši ya Tshedimošo. E bile Modulasetulo wa Sekolo sa Boentšenere go tloga ka 2004 gomme gonabjale ke ngwaga wa bone wa paka ya gagwe.
O hlomile le go etapele Lekala la Dinyakišišo la Enetši ya Go hlweka, leo le nago le nepišo ye e nabilego ya disaense tša moya wa go fiša le go elela ga seela le nepišo ye e pitlaganego mo go diphetišetšo tša phišo. Nyakišišo ya gagwe ya phetišetšo ya phišo e nepišitše mošomo wa motheo wa go kelelo ka taolong ya kelelo ya nakwana, diela tša nano, le phokafalo. Mošomo wa gagwe o dirišitšwe go sola ya moya wa go fiša, phefo le enetši ya nyuklea. Lekala le na le tekanyetšo ya baithuti ba dialogadigolwane ba nako ka moka le maloko a badirišani a lesome. Profesa Meyer o hlomile dilaporotori tša go fapana tša didirišwa tša maemo a bokgabo gomme o akanyeditše le go aga dihlopha tša diteko tša moswananoši tša go feta tše 12 ka tirišano le maloko a sehlopha sa gagwe sa dinyakišišo.
Profesa Meyer o amogetše difoka tše hlano tša go ruta tša setšhaba tša go fapana go tšwa diyunibesithing tše tharo, gammogo le difoka tša ditšhabatšhaba, ka 2013, tša Profesa ya Bokgoni go feta ka moka ka Boentšenere bja Semotšhene le Aeronathikale. O thopile difoka tša go feta 20 tša athekele ya bokgoni go feta ka moka goba sengwalwa sa khonferense sa bokgoni go feta ka moka le difoka tše mmalwa tša dinyakišišo tša gae le tša ditšhabatšhaba. Ke leloko goba Modirišani wa mekgatlo le diinstitušene tša go fapana tša profešene go swana le Lekgotla la Amerika la Boraentšenere ba Semotšhene (ASME), Lekgotla la Amerika la Boraentšenere ba Diruthufatši, Ditšidifatši le Ditekanyomoya (e tsebega gabotse bjalo ka ASHRAE), Institute ya Amerika ya Diaeronathiki le Diastronathiki (AIAA), le Lekgotla la Aeronathiki la Royal.
O na le tekanyetšo ya B1 go tšwa NRF gomme ke ‘monyakišiši yo a tsopotšwego kudu’, seo se ra gore ISI e mmeya maemong a banyakišiši ba maemo a godimo ba 1% ka boentšenere. O thuša botong ya barulaganyi ya dijenale tše 13 gomme ke goba e be e le morulaganyi wa dijenale tše šupa. Kgauswanyana o thušitše mo komiting ya tlhopo ya Lenaneo la Difoka la Institute ya Franklin (leo le bilego gona go tloga ka 1824 gomme ke le lengwe la kgale go feta ka moka lefaseng) la Metale wa Benjamin Franklin.
O ngwadile le go ngwala mmogo diathekele tša go feta 600, dingwalwa tša dikhonferense le dikgaolo tša dipuku, gomme o lekotše le go lekola mmogo baithuti ba dinyakišišo ba go feta 100 ba mastase le PhD. Ka 2016, o thopile Sefoka sa Molekodi yo a atlegilego kudu sa Yunibesithi ya Pretoria. Le ke lekga la bohlano ge a amogela sefoka sa mošomedi yo a atlegilego kudu wa UP.

Professor Myburg is professor in genetics in the Faculty of Natural and Agricultural Sciences. He holds the Chair in Forest Genomics and Biotechnology at UP and is the Director of the Forest Molecular Genetics (FMG) Programme. The FMG Programme in the Forestry and Agricultural Biotechnology Institute (FABI) and Genomics Research Institute (GRI) comprises four academic staff, five postdoctoral fellows, 24 MSc and PhD students, six BSc honours students and 17 research and administrative support staff. Professor Myburg’s research focuses on the genetic control and genomics of woody biomass production in fast-growing forest trees and, in particular, the genetic regulation of biopolymer synthesis in wood fibre cells. The FMG Programme is a joint research venture of UP and South African forestry industry partners with support from the Technology and Human Resources for Industry Programme (THRIP), the National Research Foundation (NRF) and the Department of Science and Technology (DST). Professor Myburg’s research team has pioneered the use of population genomics and systems genetics approaches to unravel the genetic control of growth and wood formation in Eucalyptus trees.
He also was the lead investigator of the US Department of Energy (DOE) funded international Eucalyptus Genome Project which generated the reference genome sequence for the genus and resulted in more than ten companion papers expanding on the genome biology, evolution, reproduction, cell wall biosynthesis and secondary metabolism of Eucalyptus trees, most of which were published in a special issue of the journal New Phytologist in 2015. This information is being used to develop biotechnology applications for tree improvement in South Africa, including DNA fingerprinting, genome-assisted breeding approaches such as genomic selection (GS) and genetic engineering to enhance tree growth and development for pulp, paper, timber and other bioeconomy applications. He has supervised 43 postgraduate (MSc and PhD) students and is author of 82 ISI peer-reviewed papers and book chapters in the field of plant molecular genetics and genomics. He currently holds a B3 rating from the NRF and is awaiting rereview. In 2015 he was awarded an NSTF-BHP Billiton TW Kambule Award for his contribution to research and its outcomes in South Africa over the last five to ten years.
Professor Myburg is professor in die Departement Genetika in die Fakulteit Natuur- en Landbouwetenskappe. Hy beklee die Leerstoel in Boomgenomika en Biotegnologie aan UP en is die Direkteur van die Bosbou Molekulêre Genetikaprogram (FMG). Hierdie program in die Instituut vir Bosbou- en Landboubiotegnologie (FABI) en die Genomikanavorsingsinstituut (GRI) bestaan uit vier akademiese personeellede, vyf nadoktorale genote, 24 MSc- en PhD-studente, ses BSc Honneursstudente en 17 administratiewe en navorsingsteunpersoneellede. Professor Myburg se navorsing fokus op die genetiese beheer en genomika van houtbiomassaproduksie in vinnig groeiende bosboubome en in die besonder die genetiese regulering van biopolimeersintese in houtveselselle. Die FMG-program is ’n gesamentlike navorsingsonderneming van UP en Suid-Afrikaanse bosboubedryfsvennote met steun van die Program vir Tegnologie en Mensehulpbronne in die Nywerheid (THRIP), die Nasionale Navorsingstigting (NNS) en die Departement van Wetenskap en Tegnologie (DWT). Professor Myburg se navorsingspan doen baanbrekerswerk oor die gebruik van bevolkingsgenomika en stelselgenetikabenaderings om die genetiese beheer van groei en houtvorming in Eucalyptus-bome te ontrafel.
Hy was ook die hoofondersoeker van die internasionale Eucalyptus-genoomprojek wat deur die Amerikaanse Departement van Energie befonds was en die verwysingsgenoomvolgorde vir die genus opgelewer het. Die navorsing het aanleiding gegee tot meer as tien aanvullende artikels oor die genoombiologie, evolusie, reproduksie, selwandbiosintese en sekondêre metabolisme van Eucalyptus-bome, waarvan die meeste in 2015 in ’n spesiale uitgawe van die joernaal New Phytologist gepubliseer is. Hierdie inligting word gebruik om biotegnologietoepassings vir boomveredeling in Suid-Afrika te ontwikkel, insluitende DNS-vingerafdrukke, genoomgesteunde teelbenaderings soos genomiese seleksie (GS) en genetiese manipulering met die oog op die verbetering van boomgroei en -ontwikkeling vir pulp-, papier-, timmerhout- en ander bio-ekonomiese toepassings. Hy was reeds studieleier van 43 nagraadse (MSc en PhD) studente en is skrywer van 82 ISI portuurbeoordeelde navorsingsartikels en boekhoofstukke op die gebied van molekulêre plantgenetika en genomika. Hy het tans ’n B3-gradering van die NNS en wag vir hersiening. In 2015 het hy die NWTF-BHP Billiton TW Kambule-toekenning vir sy bydrae tot navorsing en die uitkomste daarvan oor die afgelope vyf tot tien jaar in Suid-Afrika ontvang.
Profesa Myburg ke profesa ya leabela ka Lefapheng la Disaense tša Tlhago le Temo. Ke Modulasetulo wa Ditšenomiki tša Dikgwa le Payotheknolotši mo UP gomme ke molaodimogolo wa Lenaneo la Leabela la Molekhula wa Dikgwa (FMG). Lenaneo la FMG ka Instituting ya Payotheknolotši ya Temo le Kagodikgwa (FABI) le Institute ya Dinyakišišo tša Ditšenomiki (GRI) le na le badirišani ba akademiki ba bane, badirišani ba ka morago ga bongaka ba bahlano, baithuti ba MSc le PhD ba 24, baithuti ba honase ya BSc ba tshela le badirišani ba dinyakišišo le thekgo ya taolo ka. Dinyakišišo tša Profesa Myburg di nepiša taolo ya leabela le tšweletšo ya ditšenomiki tša sebolwa sa go dirwa ka kota mo mehlareng ya dithokgweng ye e golago ka lebelo le legolo, kudu, taolo ya leabela la tšweletšo ya payopholima ka diseleng tša ditlhale tša kota. Lenaneo la FMG ke tirigalo ya dinyakišišo tša mohlakanelwa tša UP le badirišani ba intasteri ya kagodikgwa ya Afrika Borwa ka thekgo go tšwa Lenaneong la Intasteri ya Theknolotši le Methopo ya Batho (THRIP), Motheo wa Dinyakišišo wa Setšhaba (NRF) le Kgoro ya Saense le Theknolotši (DST). Sehlopha sa dinyakišišo sa Profesa Myburg se hlomile tšhomišo ya ditšenomiki tša batho le ditlhakego tša mekgwa ya leabela go rarolla taolo ya leabela la kgolo le popego ya mehlare ya Eucalyptus
E bile gape monyakišišomogolo wa Kgoro ya Enetši (DOE) ya Amerika wa Protšeke ya Tšenome ya Eucalyptus yeo e thekgwago ditšhabatšhabeng yeo e hlotšego tatelano ya tšenome ya dikakanyo tša sehlopha gomme ya hlola dingwala tša tirišano tša go feta tše lesome tše di katološago payolotši ya tšenome, ebolušene, tswalo, payosentese le go robega ga nyenyane ga mehlare ya Eucalyptus, tše dintši tša tšona di phatlaladitšwe ka kgatišong ya go ikgetha ya jenale ya New Phytologist ka 2015. Tshedimošo ye e šomišitšwe go tšwetšapele ditirišo tša payotheknolotši tša kaonafatšo ya mehlare ka Afrika Borwa, go akaretša go kgatišo ya menwana ya DNA, mekgwa ya tswadišo ye e thušwago ke tšenome go swana le kgetho ya tšenomiki (GS) le boentšenere bja leabela go kaonafatša kgolo ya mehlare le tšweletšopele ya sesohlo, pampiri, legong le ditirišo tše dingwe tša payoekonomi. O lekotše baithuti ba dialogadigolwane ba 43 tša (MSc le PhD) gomme ke mongwadi wa dingwalwa tše 82 tša ISI tšeo di sekasekilwego ke badirišani le dikgaolo tša dipuku ka karolong ya leabela la molekhula wa dimela le tšenomiki. Gonabjale o na le tekanyetšo ya B3 go tšwa NRF gomme o emetšwe go lekolwa gape. Ka 2015 o abetšwe Sefoka sa BHP Billiton-TW Kambule ka tema yeo a ikgathilego mo dinyakišišong le dipoelong tša tšona mo Afrika Borwa mo mengwageng ye mehlano go iša go ye lesome ya go feta.

Professor Pattinson is the director of the South African Medical Research Council (SAMRC)/University of Pretoria Maternal and Infant Health Care Strategies Research Unit and clinical head of the Department of Obstetrics and Gynaecology in the Faculty of Health Sciences.
He is also co-director to the University of Pretoria’s Research Centre for Maternal, Fetal, Newborn and Child Health. He serves on the National Committee for the Confidential Enquiries into Maternal Deaths and the National Perinatal Morbidity and Mortality Committee in South Africa. He is responsible for the perinatal care and child health care surveys in South Africa and developed the databases for the qualities of care surveys in maternal, newborn and child health. These have now been adopted by the National Department of Health as the national standard and incorporated in their data systems.
Professor Pattinson’s main research interests are in obstetrics, medical audits, health systems, effective methods of outreach and developing innovative methods of preventing stillbirths. His main research foci are on determining the most effective means of implementing new health care strategies such as emergency obstetric care, improving current programmes, eg improving basic antenatal care and developing a continuous wave Doppler apparatus to screen for foetuses at risk of stillbirth. He was awarded the Havenga Medal for original research in the natural sciences by the Suid Afrikaanse Akademie for Wetenskap en Kuns in 2016.
Professor Pattinson is die direkteur van die Suid-Afrikaanse Mediese Navorsingsraad (SAMNR)/Universiteit van Pretoria se Navorsingseenheid vir Moeder- en Kind-gesondheidsorgstrategieë en kliniese hoof van die Departement Verloskunde en Ginekologie in die Fakulteit Gesondheidswetenskappe.
Hy is ook mededirekteur van die Universiteit van Pretoria se Navorsingsentrum vir Moeder-, Fetus-, Pasgeborene- en Kindergesondheid. Hy dien in die Nasionale Komitee vir Vertroulike Navrae oor Moedersterftes en die Nasionale Komitee vir Perinatale Morbiditeit en Mortaliteit in Suid-Afrika. Hy is verantwoordelik vir die opnames van perinatale sorg en kindergesondheidsorg in Suid-Afrika en het die databasisse vir die kwaliteitsorgopnames in moeder-, pasgeborene- en kindergesondheid ontwikkel. Dit is nou deur die nasionale Departement van Gesondheid as die nasionale standaard aanvaar en in sy datastelsels opgeneem.
Professor Pattinson se vernaamste navorsingsbelangstellings is in verloskunde, mediese oudits, gesondheidstelsels, doeltreffende uitreikmetodes en die ontwikkeling van innoverende metodes om stilgeboortes te voorkom. Sy vernaamste navorsingsfokusse is die bepaling van die doeltreffendste maniere om nuwe gesondheidsorgstrategieë soos noodverloskundige sorg te implementeer, huidige programme te verbeter, bv verbetering van basiese voorgeboortelike sorg en die ontwikkeling van ’n kontinuegolf-Doppler-apparaat om sifting vir fetusse met risiko van doodgeboorte te doen. Hy het in 2016 die Suid-Afrikaanse Akademie vir Wetenskap en Kuns se Havenga-medalje vir oorspronklike navorsing in die natuurwetenskappe ontvang.
Profesa Pattinson ke molaodimogolo wa South African Medical Research Council (SAMRC)/ Lekala la Dinyakišišo tša Mekgwa ya Tlhokomelo ya Maphelo a Masea le Bomma ge ba le mmeleng goba ka morago ga pelego la Yunibesithi ya Pretoria le hlogo ya kalafo ya Kgoro ya Pelegišo le Kalafo ya Malwetši a Basadi le Basetsana ka Kgorong ya Disaense tša Maphelo.
Ke gape molaodimmogo wa Senthara ya Dinyakišišo tša Maphelo a Bana, Masea ao a sa tšwago go belegwa, Masea ao a se a hlwago a belegwa le Bomma ge ba le mmeleng goba ka morago ga pelego ya Yunibesithi ya Pretoria. O thuša mo Komiting ya Setšhaba ya Dipotšišo tša Sephiri ka ga Mahu a Bomma pele le morago ga pelego le Komiti ya Setšhaba ya Mahu le Malwetši a Nako ya Pele le Morago ga Pelego ka Afrika Borwa. O na le maikarabelo a dinyakišišo tša tlhokomelo ya nako ya pele le morago ga pelego le tlhokomelo ya maphelo a ngwana ka Afrika Borwa gomme o hlomile datapeisi ya mabokgoni a dinyakišišo tša tlhokomelo ya maphelo a Bomma ge ba le mmeleng goba ka morago ga pelego, masea ao a sa tšwago go belegwa le bana. Tše di amogetšwe ke Kgoro ya Maphelo ya Setšhaba bjalo ka maemo a setšhaba gomme tša kopanywa mekgweng ya yona ya data.
Dikgahlego tša dinyakišišo tše dikgolo tša Profesa Pattinson di go pelegišo, tlhakišo ya kalafo, mekgwa ya maphelo, mekgwa ya go šoma ya go fihlelela palo ye kgolo le go hlabolla mekgwa ya tšweletšopele ya go thibela masea ao a belegwago a hlokofetše. Nepišo ya gagwe ya dinyakišišo ke go hlaloša mokgwa wa go šoma gabotse wa go diriša mekgwa ya tlhokomelo ya maphelo ye mefsa go swana le tlhokomelo ya pelegišo ya tšhoganetšo, go kaonafatša mananeo a gonabjale, mohlala, go kaonafatša tlhokomelo ya boimana ya motheo le go hlabolla sedirišwa sa Doppler seo se tla tšwelago pele go atlega go lekola ngwana yo a se a hlwago a belegwa yo a lego kotsing ya go belegwa a hlokafetše. O abetšwe Metale wa Havenga wa dinyakišišo tša mathomong ka disaenseng tša tlhago ke Suid Afrikaanse Akademie ya Wetenskap le Kuns ka 2016.

Professor Roux is a professor in the Forestry and Agricultural Biotechnology Institute (FABI), Department of Plant and Soil Sciences in the Faculty of Natural and Agricultural Sciences.
She is a tree/forest health specialist and conducts research on micro-organisms, especially fungi and their insect associates that cause diseases of trees. South African natural forest ecosystems and commercial forestry plantations are under increasing threat due to the growing number of non-native pathogens and pests entering the country. As research leader in the Tree Pathology Co-operative Programme (TPCP) and DST-NRF Centre of Excellence in Tree Health Biotechnology (CTHB), Professor Roux’s research involves the early detection and identification of tree diseases, the characterisation of the causal agents of tree disease and the elucidation of the epidemiology of the pathogens and the diseases they cause. This is done in the broader context of establishing a knowledge base for fungal biodiversity of plantation and forest ecosystems to improve understanding of the origin and potential impact of changes in the fungal species and genetic diversity in these systems. She works locally, in various other African countries and internationally and has supervised more than 70 MSc and PhD students from Africa, Asia and South America, as well as from South Africa and the USA.
Professor Roux has published more than 180 articles in ISI rated journals and published several book chapters on tree health issues. She serves on the editorial boards of three ISI journals. She is also the research co-ordinator of the research group on forest pathology of the International Union of Forestry Research Organizations (IUFRO), honorary guest professor of the Chinese Academy of Forestry and past vice-president of the Southern African Society of Plant Pathology. She has received several past awards from the University of Pretoria, was a previous winner of the distinguished Young Women in Science Award of the DST, received the Queen’s Award in Forestry from the Commonwealth Forestry Association, and was awarded a National Science and Technology Forum (NSTF) of South Africa prize for capacity building. Most recently she also received an international scientific achievement award from the International Union of Forestry Research Organizations (IUFRO).
Professor Roux is ʼn professor in die Instituut vir Bosbou- en Landboubiotegnologie (FABI), Departement Plant- en Grondkunde in die Fakulteit Natuur- en Landbouwetenskappe.
Sy is ʼn boompatoloog en doen navorsing op mikro-organismes, veral swamme en hulle geassosieerde insekte, wat boomsiektes veroorsaak. Natuurlike bos-ekosisteme sowel as kommersiële plantasies in Suid-Afrika word toenemend bedreig deur die groeiende aantal uitheemse patogene en peste wat die land binnekom. As navorsingsleier van die Koöperatiewe Program vir Boombeskerming (TPCP) en die DWT-NNS Sentrum vir Uitnemendheid in Boomgesondheidbiotegnologie (CTHB), het professor Roux se navorsing betrekking op die vroeë waarneming en identifisering van boomsiektes, die beskrywing van die oorsaaklike agente van boomsiektes en die verklaring van die patogeenepidemiologie. Dit word gedoen binne die breë raamwerk van die vestiging van ʼn kennisbasis vir swambiodiversiteit in plantasieen woud-ekosisteme om die oorsprong en potensiële impak van veranderinge in die swamspesies, en genetiese diversiteit in dié stelsels, beter te verstaan. Professor Roux werk plaaslik, in verskeie ander Afrika-lande en internasionaal en het studieleiding aan meer as 70 MScen PhD-studente van Afrika, Asië en Suid-Amerika, sowel as Suid-Afrika en die VSA, gegee.
Professor Roux het meer as 180 artikels in ISI-gelyste tydskrifte en verskeie boekhoofstukke oor boomgesondheidskwessies gepubliseer. Sy dien op die redaksie van drie ISI-tydskrifte. Sy is ook die navorsingskoördineerder van die navorsingsgroep oor woudpatologie van die International Union of Forestry Research Organizations (IUFRO), eregasprofessor van die Chinese Bosbou-akademie en voormalige visepresident van die Suider-Afrikaanse Vereniging vir Plantpatologie. Professor Roux het in die verlede verskeie toekennings van die Universiteit van Pretoria ontvang, is ʼn voormalige wenner van die vooraanstaande Young Women in Science-toekenning van die DWT, het die Queen’s Award in Forestry van die Statebondbosbouvereniging ontvang, asook ʼn prys vir kapasiteitsbou van die National Science and Technology Forum (NSTF) van Suid-Afrika. Meer onlangs het sy ʼn internasionale wetenskaplike prestasietoekenning van die International Union of Forestry Research Organizations (IUFRO) ontvang.
Profesa Roux ke profesa mo Institušeng ya Payotheknolotši ya Temo le Kagodikgwa (FABI), Kgorong ya Disaense tša Dimela le Mabu ka Lefapheng la Disaense tša Tlhago le Temo.
Ke setsebi sa maphelo a mehlare/dikgwa gomme o dira dinyakišišo ka diphedinyana, kudu mouta le dikhunkhwana tše di amanago le wona tšeo di hlolago malwetši a mehlare. Ditikologo tša mehlare ya tlhago ya Afrika Borwa gammogo le dikgwa tša mehlare ya kgwebo di ka fase ga tšhošetšo ye e oketšegago ka lebaka la palo ye e golago ya diphatotšene tše e sego tša setala le disenyi tše di tsenago ka nageng. Bjalo ka moetapele wa dinyakišišo mo Lenaneong la Tirišano ya Phatholotši ya Mehlare (TPCP) le Senthara ya Bokgoni ya ka Payotheknolotši ya Maphelo a Mehlare (CTHB) ya DST-NRF, Nyakišišo ya Profesa Roux e amana le go utolla ka pela le go hlatha malwetši a mehlare, tlhalošo ya seo se hlolago malwetši a mehlare le tlhalošo ya epidimolotši ya diphatotšene le malwetši ao di a hlolago. Se se dirwa ka bophara go hlola motheo wa tsebo ya phapano ya payolotši ya mouta ya ditikologo tša dikgwa tša mehlare go kaonafatša kwešišo ya botšo le kgonagalo ya khuetšo ya diphetogo mo dihlopheng tša mouta le phapano ya leabela mo mekgweng ye. O šoma mo gae, ka dinageng tše dingwe tša go fapana ka Afrika le ditšhabatšhabeng gomme o lekotše baithuti ba go feta 70 ba MSc le baithuti ba PhD go tšwa Afrika, Asia le South America, gammogo le Afrika Borwa le USA.
Profesa Roux o phatlaladitše diathekele tša go feta 180 ka dijenaleng tše di lekaneditšwego ke ISI gomme a phatlalatša dikgaolo tša dipuku tše mmalwa ka ga ditaba tša maphelo a mehlare. O thuša mo botong ya borulaganyi ya dijenale tše tharo tša ISI. Gape ke mokgokaganyi wa dinyakišišo wa sehlopha sa dinyakišišo ka ga phatholotši ya mehlare sa Kopano ya Ditšhabatšhaba ya Mekgatlo ya Dinyakišišo ya Kagodikgwa (IUFRO), profesa ya moeti ya tlhompho ya Akademi ya China ya Kagodikgwa le motlatšamopresidente wa Lekgotla la Phatholotši ya Dimela ya Borwa bja Afrika. O amogetše difoka tše mmalwa tša nako ya go feta go tšwa Yunibesithing ya Pretoria, e bile mofenyi wa maloba wa Sefoka sa go tuma sa Basadi ba Bafsa ka Saenseng sa DST, o amogetše Sefoka sa Kagodikgwa sa Queen go tšwa Mokgatlong wa Kagoditšhaba wa Kgweranoditšhaba, gomme o abetšwe sefoka sa Foramo ya Saense ya Setšhaba le Theknolotši (NSTF) ya Afrika Borwa sa kago ya bokgoni. Kgauswanyana o amogetše gape sefoka sa bokgoni bja saense sa ditšhabatšhaba go tšwa Mekgatlong ya Dinyakišišo ya Kagodikgwa ya Kopano ya Ditšhabatšhaba (IUFRO).

Professor Schoeman is a veterinarian who holds a PhD from the University of Cambridge. He is professor and Head of the Department of Companion Animal Clinical Studies since September 2009. Despite the demanding leadership role and concomitant administrative responsibilities as head of the largest department in the Faculty of Veterinary Science, Professor Schoeman has constantly maintained remarkable achievements in research, teaching, service delivery and community engagement and is esteemed as a clinician-scientist by his international peers.
In collaboration with his postgraduate students, he has authored 62 scientific papers over the past 16 years. In addition, he has published ten book chapters in leading international textbooks. His most recent contribution is a new chapter to the USA-based Textbook of veterinary internal medicine on endocrine responses to critical illness, which is the main thrust of his current research and was the topic of his PhD. He has delivered 26 keynote addresses at international conferences in the USA, France, Hungary, Canada, New Zealand and Korea, among others, and recently acquired a B2 rating from the NRF (2016–2021). Apart from Professor Schoeman’s own research outputs, the Department’s research performance, as well as the number of staff with PhD degrees and NRF ratings, has increased admirably under his leadership.
Besides his excellence in research, Professor Schoeman is a well-respected clinician and teacher, both locally and internationally. He holds specialist qualifications in veterinary internal medicine from three different institutions, namely the South Africa Veterinary Council, the Royal College of Veterinary Surgeons in the United Kingdom and the European College of Veterinary Internal Medicine.
Professor Schoeman has twice received the Faculty’s Clinician of the Year award, has been elected Lecturer of the Year and has been awarded the South African Veterinary Association’s Clinical Award. He has served on the examination board of the European College of Veterinary Internal Medicine for seven years, of which three years as chair. Most recently, Professor Schoeman served a term as executive board member of the International Society of Comparative Endocrinology and, in 2016, he was appointed by the Council on Higher Education (CHE) as a peer reviewer for the quality enhancement project of South African universities.
Professor Schoeman is ’n veearts met ’n PhD van die Universiteit van Cambridge. Hy is professor en sedert September 2009 Hoof van die Departement Geselskapsdier Kliniese Studies. Ten spyte van die veeleisende leiersrol en gepaardgaande administratiewe verantwoordelikhede as hoof van die grootste departement in die Fakulteit Veeartsenykunde, handhaaf professor Schoeman deurgaans merkwaardige prestasies in navorsing, onderrig, dienslewering en gemeenskapsbetrokkenheid en word hy deur sy internasionale eweknieë hoog geag as ’n klinikuswetenskaplike.
In samewerking met sy nagraadse studente het hy die afgelope 16 jaar 62 wetenskaplike artikels geskryf. Voorts het hy tien boekhoofstukke in toonaangewende internasionale handboeke gepubliseer. Sy jongste bydrae is ’n nuwe hoofstuk in die VSA-gebaseerde Textbook of veterinary internal medicine oor endokriene reaksies op kritieke siekte, wat die kern van sy huidige navorsing vorm en die onderwerp van sy PhD was. Hy het 26 hoofredes op internasionale konferensies in onder meer die VSA, Frankryk, Hongarye, Kanada, Nieu-Seeland en Korea gelewer, en hy het onlangs ’n B2-gradering van die NNS ontvang (2016-2021). Afgesien van professor Schoeman se eie navorsingsuitsette het die Departement se navorsingsprestasie, asook die aantal personeellede met doktorsgrade en NNS-graderings, onder sy leiding sterk toegeneem.
Afgesien van sy uitnemendheid in navorsing is professor Schoeman ’n hoogs gerekende klinikus en dosent, hier te lande en internasionaal. Hy het spesialiskwalifikasies in veterinêre interne geneeskunde van drie verskillende instellings, naamlik die Suid-Afrikaanse Veterinere Raad, die Royal College of Veterinary Surgeons in die Verenigde Koninkryk en die European College of Veterinary Internal Medicine.
Professor Schoeman het die Fakulteit se Klinikus van die Jaar-toekenning al twee keer ontvang, is voorheen as Dosent van die Jaar gekies en het ook die Klinikustoekenning van die Suid-Afrikaanse Veeartsenykundevereniging ontvang. Hy het vir sewe jaar op die eksamenraad van die European College of Veterinary Internal Medicine gedien en was die laaste drie jaar daarvan die voorsitter. Professor Schoeman het onlangs 'n termyn as uitvoerende raadslid van die International Society of Comparative Endocrinology gedien, en in 2016 is hy deur die Raad op Hoër Onderwys aangestel as ’n portuurevalueerder vir die kwaliteitverbeteringsprojek van Suid-Afrikaanse universiteite
Profesa Schoeman ke ngaka ya diphoofolo yo a nago le PhD go tšwa Yunibesithing ya Cambridge. E bile hlogo ya Kgoro ya Dithuto tša Kalafo ya Diphoofolo tša Tirišano go tloga ka Lewedi 2009. Le ge a swaragane le karolo ya boetapele ya mošomo wo montši le taolo ye boima magatleng a gagwe bjalo ka hlogo ya kgoro ye kgolo go feta ka moka ka Lefapheng la Disaense tša Bongakadiruiwa, Profesa Schoeman o swareletše ntle le go se fetoge bokgoning bja go makatša mo dinyakišišong, go ruteng, kabong ya ditirelo le go tšea karolo setšhabeng gomme o hlompšha kudu bjalo ka rasaense wa kalafo ke badiršani ba gagwe ba ditšhabatšhaba.
Ka tirišano le baithuti ba gagwe ba dialogadigolwane, o ngwadile dingwalwa tša saense tše 62 mo mengwageng ye 16 ya go feta. Go tlaleletša, o phatlaladitše dikgaolo tše 10 tša dipuku tša kgakollo. Tema ya gagwe ye a e kgathilego gonabjale ke kgaolo ye mpsha go Textbook of veterinary internal medicine ye e lego USA ka ga dikarabo tša endokrini go malwetši a šoro, yeo e lego maikemišetšo a motheo wa nyakišišo ya gonabjale ya sererwa sa PhD ya gagwe. O abile dipolelo tša motheo tše 26 mo dikhonferenseng tša ditšhabatšhaba ka USA, France, Hungry, Canada, New Zealand le Korea, gare ga tše dingwe, gomme kgauswanyana o hweditše tekanyetšo ya B2 go tšwa NRF (2016 – 2021). Ntle le ditšweletšwa tša dinyakišišo tša Prof Schoeman, mošomo wa dinyakišišo wa Kgoro, gammogo le palo ya badirišani bao ba nago le ditrikrii tša mafelelo le ditekanyetšo tša NRF, di oketšegile gabotse kudu ka fase ga boetapele bja gagwe.
Go tlaleletša bokgoni bja gagwe bja dinyakišišo, Profesa Schoeman ke ngaka ya kalafo le morutiši, bobedi mo gae le ditšhabatšhabeng. O na le dithuto tša bokgoni ka kalafo ya ka gare ya diphoofolo go tšwa diinstitušeneng tše tharo tša go fapafapana e lego Khansele ya Diphoofolo ya Afrika Borwa, Kholetšhe ya Royal ya Dingaka tša Diphoofolo ka United Kingdom le Kholetšhe ya Yuropa ya Kalafo ya Ka gare ya Diphoofolo.
Profesa Schoeman o amogetše sefoka sa Ngaka ya Ngwaga ka Lefapheng gabedi, o kgethilwe bjalo ka Mofahloši wa Ngwaga gomme o filwe Sefoka sa Kalafo sa Mokgatlo wa Diphoofolo wa Afrika Borwa. O thušitše botong ya ditlhahlobo ya Kholetšhe ya Yuropa ya Kalafo ya Ka gare ya Diphoofolo, gomme e bile modulasetulo wa boto mengwaga ye meraro ya go feta. Kgauswanyana, Profesa Schoeman o thušitše paka bjalo ka lelokophethiši la boto ya Lekgotla la Ditšhabatšhaba la Endokrinolotši ya Papetšo gomme, ka 2016, o kgethilwe ke Khansele ya Thuto ya Godimo (CHE) bjalo ka molekodi wa badirišani wa protšeke ya kaonafatšo ya boleng.

Professor J
Professor Venter is a professor in the Department of Microbiology and Plant Pathology and currently holds the Rand Water Chair in Water Microbiology. Through his research he is also affiliated with the Tree Protection Co-operative Programme and the Centre of Excellence in Tree Health Biotechnology at the Forestry and Agriculture Biotechnology Institute (FABI). In addition, he has several collaborations with researchers at universities in the United States of America.
The main focus of his research is bacterial evolution, systematics and diversity. Through the use of comparative genomics his research programme attempts to understand the functions, biology and evolution of bacteria associated with plants and aquatic environments. His main focus related to bacterial systematics is on the plant pathogenic Enterobacteriaceae including the genus Pantoea as well as nitrogen fixing Burkholderia and Bradyrhizobium species isolated from indigenous legumes in South Africa. His group has already described several new species belonging to these genera.
Professor Venter’s research for Rand Water focuses on the bacterial ecosystem present within drinking water distribution networks. With this research his group is able to monitor the presence and abundance of bacterial species within the network, and demonstrate how the bacterial community changes in response to external factors such as water treatment, temperature and seasonality.
In addition to his research programmes, Professor Venter serves on the Executive Board of the International Committee on Systematics of Prokaryotes and on the Council of the Southern African Society for Systematic Biology. He is a member of the editorial board of the journal Systematic and Applied Microbiology, a review editor for Frontiers in Microbiology and associate editor of the International Journal of Systematic and Evolutionary Microbiology.
Professor Venter is ’n professor in die Departement Mikrobiologie en Plantpatologie en beklee tans die Rand Water-leerstoel in Watermikrobiologie. Deur sy navorsing is hy ook geaffilieer by die Koöperatiewe Program vir Boombeskerming (TPCP) en die Sentrum vir Uitnemendheid in Boomgesondheidbiotegnologie (CTHB) in die Instituut vir Bosbou- en Landboutegnologie (FABI). Voorts het hy verskeie samewerkingsooreenkomste met navorsers aan universiteite in die Verenigde State van Amerika.
Die hooffokus van sy navorsing is bakteriese evolusie, sistematiek en diversiteit. Deur die gebruik van vergelykende genomika poog sy navorsingsprogram om die funksies, biologie en evolusie van bakterieë wat met plante en akwatiese omgewings geassosieer word, te verstaan. Sy hooffokus in verband met bakteriese sistematiek is op die plantpatogene Enterobacteriaceae, insluitende die genus Pantoea, asook stikstofbindende Burkholderia- en Bradyrhizobium-spesies wat uit inheemse peulplante in Suid-Afrika geïsoleer is. Sy groep het reeds verskeie nuwe spesies wat tot hierdie genera behoort, beskryf.
Professor Venter se navorsing vir Rand Water fokus op die bakteriese ekostelsel in drinkwaterverspreidingsnetwerke. Met hierdie navorsing kan sy groep die teenwoordigheid en omvang van bakteriespesies in die netwerk monitor en toon hoe die bakteriegemeenskap verander na aanleiding van eksterne faktore soos waterbehandeling, temperatuur en seisoenaliteit.
Benewens sy navorsingsprogramme dien professor Venter in die Uitvoerende Raad van die Internasionale Komitee oor Sistematiek van Prokariote en in die Raad van die Suider-Afrikaanse Vereniging vir Sistematiese Biologie. Hy is ’n lid van die redaksie van die joernaal Systematic and Applied Microbiology, ’n resensieredakteur vir Frontiers in Microbiology en mederedakteur van die International Journal of Systematic and Evolutionary Microbiology.
Profesa Venter ke profesa ka Kgorong ya Maekropayolotši le Phatholotši ya Dimela gomme gonabjale ke Modulasetulo wa Rand Water ka go Maekropayolotši ya Meetse. Ka dinyakišišo tša gagwe o tsenetše Lenaneo la Tirišano ya Tshireletšo ya Mehlare le Senthara ya Bokgoni ka Payotheknolotši ya Maphelo a Mehlare mo Instituting ya Payotheknolotši ya Temo le Kagodikgwa (FABI). Go tlaleletša, o na le ditirišano tše mmalwa le banyakišiši mo diyunibesithing ka Amerika.
Nepokgolo ya nyakišišo ya gagwe ke ebolušene ya pakteria, mekgwa le phapano. Ka tšhomišo ya ditšenomiki tša papetšo nyakišišo ya gagwe e leka go kwešiša mešomo, payolotši le ebolušene ya pakteria ye e amanago le dimela le tikologo ya ka meetseng. Nepokgolo ye e amanago le mekgwa ya pakteria e go phathotšeniki ya dimela Enterobacteriaceae go akaretša sehlopha sa Pantoea gammogo le naetrotšene ye e lokišaga diphedi tša Burkholderia le Bradyrhizobium ye e beetšwego thoko go merogodiphotlwa ya tlhago ka Afrika Borwa. Sehlopha sa gagwe se šetše se hlalošitše diphedi tše mmalwa tše difsa tša mehuta ye.
Nyakišišo ya Pofesa Venter ya Rand Water e nepiša tikologo ya pakteria ye e lego gona ka dihlopeng tša kabo ya meetse a go nwa. Ka nyakišišo ye sehlopha sa gagwe se kgona go lekola go ba gona le go se be gona ga diphedi tša pakteria mo sehlopheng, le go laetša ka moo setšhaba sa pakteria se fetogago go arabela mabaka a ka ntle go swana le go hlokomela meetse, themperetšha le dihla.
Go tlaleletša mananeo a dinyakišišo tša gagwe, Profesa Venter o thuša Botong ya Taolo ya Komiti ya Ditšhabatšhaba ka Mekgwa ya Prokaroyotese le mo Khanseleng ya Lekgotla la Borwa bja Afrika la Payolotši ya Mekgwa. Ke leloko la boto ya go rulaganya ya jenale ya Systematic and Applied Microbiology, morulaganyi wa tshekatsheko wa Frontiers in Microbiology le mothušamorulaganyi wa International Journal of Systematic and Evolutionary Microbiology.

Professor Zimper is a professor in the Department of Economics in the Faculty of Economic and Management Sciences. He obtained his PhD in Economics from the University of Mannheim and came to South Africa in 2006 as a senior lecturer in the School of Economics at the University of Cape Town. Since then he had been appointed as professor at the Universities of Johannesburg and the Witwatersrand, before he joined the University of Pretoria in 2011.
Professor Zimper specialises in economic theory with an emphasis on financial economics. His research encompasses topics in decision theory, game theory, general equilibrium theory under asymmetric information, asset pricing, financial markets, and banking regulation. A substantial part of his research can be considered as purely theoretical in that it investigates limitations and possibilities of decision theoretic models which are themselves just plug-ins into economic models. This theoretical research includes, for example, different models of Bayesian learning under ambiguity as well as models of preferences over large spaces of random variables (i.e. random variables without finite moments). Also of purely theoretical nature is his research on asset trade between highly rational agents where the agents may have different information about the value of these assets. Professor Zimper collaborates with more applied economists on models of savings behaviour over the life-cycle and on asset pricing models. These collaborations fall under the broad umbrella of behavioural economics as they are based on decision-theoretic alternatives to the standard rationality paradigm in economics. Contrary to common belief, the move away from rational models towards models with boundedly rational agents coincides with more rather than less mathematics. Professor Zimper’s task in these collaborations is to ensure the conceptual and mathematical soundness of the used decision-theoretic models. He has published in leading journals on economic theory such as Journal of Economic Theory, Economic Theory, Journal of Risk and Uncertainty, Journal of Economic Dynamics and Control, and Journal of Economic Behavior and Organization. He has also published in mathematical and psychological journals such as Fuzzy Sets and Systems and the Journal of Mathematical Psychology. Until 2015 Professor Zimper served as associate editor of the Economic Research Southern Africa (ERSA) working paper series and as the convenor for the ERSA Economic Theory node. He is an associate editor of the journal Mathematics and Financial Economics which was recently added to the ISI list. He has research affiliations with the Robust Finance Group at the University of Bielefeld (Germany) and the Institute for the World Economy (Kiel, Germany). Professor Zimper has a B3 rating from the NRF.
Professor Zimper is ʼn professor in die Departement Ekonomie in die Fakulteit Ekonomiese en Bestuurswetenskappe. Hy het sy PhD in Ekonomie aan die Universiteit van Mannheim verwerf en in 2006 na Suid-Afrika gekom as ʼn senior dosent in die Skool van Ekonomiese Wetenskappe by die Universiteit van Kaapstad. Sedertdien het hy aanstellings as professor by, onderskeidelik, die universiteite van Johannesburg en die Witwatersrand beklee, voor hy in 2011 by die universiteit van Pretoria aangesluit het.
Professor Zimper spesialiseer in ekonomiese teorie met die klem op finansiële ekonomie. Sy navorsing sluit onderwerpe in soos besluitteorie, spelteorie, algemene balansteorie onder asimmetriese informasie, bateprysbepaling, finansiële markte en bankregulering.
ʼn Aansienlike deel van sy navorsing kan beskou word as suiwer teoreties in die sin dat dit beperkings en moontlikhede van besluitteoretiese modelle, wat op sigself net by ekonomiese modelle ingeprop word, ondersoek. Hierdie teoretiese navorsing sluit, byvoorbeeld, verskillende modelle van Bayesiaanse leer in ʼn dubbelsinnige konteks sowel as voorkeurmodelle oor groot ruimtes van ewekansige veranderlikes (dit is ewekansige veranderlike sonder begrensde momente) in. Ook van ʼn suiwer teoretiese aard is sy navorsing oor bateverhandeling tussen hoogs rasionele agente waar die agente verskillende inligting oor die waarde van hierdie bates mag hê. Professor Zimper werk saam met meer toegepaste ekonome aan modelle vir besparingsgedrag oor die lewensiklus en modelle vir bateprysbepaling. Hierdie medewerking val onder die breë vaandel van gedragsekonomiesewetenskappe, aangesien hulle gebaseer is op besluitteorie alternatiewe vir die standaard rasionaliteitsparadigma in ekonomiese wetenskappe. Anders as wat algemeen aanvaar word, behels die beweging weg van rasionele modelle na gebonde rasionele modelle van besluitneming méér eerder as minder wiskunde. Professor Zimper se taak in hierdie medewerkings is om die konseptuele en wiskundige betroubaarheid van die besluitteoretiese modelle wat gebruik word, te verseker. Hy het in vooraanstaande vaktydskrifte oor ekonomiese teorie soos Journal of Economic Theory, Economic Theory, Journal of Risk and Uncertainty, Journal of Economic Dynamics and Control en Journal of Economic Behavior and Organization gepubliseer. Hy het ook in wiskundige en sielkundige vaktydskrifte soos Sets and Systems en die Journal of Mathematical Psychology gepubliseer. Professor Zimper het tot en met 2015 as mederedakteur van die Ekonomiese Navorsing Suider-Afrika (ERSA)-werksdokumentreeks gedien en is die sameroeper van die ERSA Ekonomiese Teorie nodus. Hy is ʼn mederedakteur van die wetenskaplike tydskrif Mathematics and Financial Economics wat onlangs tot die ISI-lys bygevoeg is. Hy het navorsingsbande met die Robust Finance Group by die Universiteit van Bielefeld (Duitsland) en die Instituut vir die Wêreldekonomie (Kiel, Duitsland). Professor Zimper het ʼn B3-gradering van die NNS.
Profesa Zimper ke profesa ka Kgorong ya Diekonomi ka Lefapheng la Disaense tša Taolo le Ekonomi. O hweditše PhD in Economics go tšwa Yunibesithing ya Mannheim gomme a tla ka Afrika Borwa ka 2006 bjalo ka mofahlošimogolo ka Sekolong sa Diekonomi mo Yunibesithing ya Kapa. Go tloga moo o thwetšwe bjalo ka profesa Yunibesithing ya Johannesburg le ya Witswatersrand, ka tatelano, pele a šomela Yunibesithi ya Pretoria ka 2011.
Profesa Zimper ke setsebi sa teori ya ekonomi go gatelelwa diekonomi tša matlotlo. Nyakišišo ya gagwe e akaretša direrwa ka teori ya diphetho, teori ya dipapadi, teori ya tekanyo ya kakaretšo ka fase ga tshedimošo ye e arogilego, go beo theko thotong, mebaraka ya matlotlo le taolo ya tša go panka.
Karolo ye kgolo ya dinyakišišo tša gagwe e ka tšewa bjalo ka ye e lego ya teori ka gore e nyakišiša dikiletšo le dikgonagalo tša dimmotlolo tša teori ya sephetho tšeo ka botšona e lego fela ditlaleletšo tše bonolo ka gare ga dimmotlolo tša ekonomi. Dinyakišišo tša teori di akaretša, mohlala, dimmotlolo tša go fapana tša go ithuta ka mokgwa wa Bayes ka fase ga dihlalošontši gammogo le dimmotlolo tša dikgetho tša dikgoba tše dikgolo tša diphetogo tša sewelo (diphetogo tša sewelo tše di se nago dinako tša kiletšo). Gape ya mohuta wa teori ya tlhago go felelela ke nyakišišo ya gagwe ka ga kgwebišano ya thoto gare ga bommaditsela ba dikgopolo tša go kwagala moo bommaditsela ba ka bago le tshedimošo ya go fapana ka ga boleng bja dithoto tše. Profesa Zimper o dirišana le boraekonomi ba bantši ba tirišo ka ga dimmotlolo tša mekgwa ya go boloka mo leboong le mo dimmotlong tša go bea theko ya thoto. Ditirišano tše di wela ka fase ga taolo ye kgolo ya diekonomi tša mekgwa ka ge di theilwe godimo ga dikgetho tša teori ya sephetho go ya go kgopolo ya go kwagala ya go tlwaelega ka diekonoming. Kgahlanong le tumelo ya tlwaelo, go tloga go dimmotlolo tša go tlwaelega go ya go dimmotlolo tša go kwagala tše di ileditšwego tša go tšea diphetho go nyalelana le mmetse wo montši go feta wo monyenyane. Mošomo wa Profesa Zimper mo ditirišanong tše ke go kgonthišiša potego ya kgopolo le ya mmetse ya dimmotlolo tša teori ya sephetho tše di šomišitšwego. O gatišitše ka dijenalnge tša diketapele ka ga teori ya ekonomi go swana le Journal of Economic Theory, Economic Theory, Journal of Risk and Uncertainty, Journal of Economic Dynamics and Control le Journal of Economic Behavior and Organization O gatišitše gape ka dijenaleng tša mmetse le tša saekolotši go swana le Fuzzy Sets and Systems and the Journal of Mathematical Psychology. Go fihla ka 2015, Profesa Zimper o šomile bjalo ka mothušamorulaganyi wa mohlwaela wa dingwalwa tša mošomo tša Dinyakišišo tša Ekonomi tša Borwa bja Afrika (ERSA) le bjalo ka moetapele wa lekala la Teori ya Ekonomi la ERSA. Ke mothušamorulaganyi wa jenale ye Mathematics and Financial Economics yeo kgauswanyana e tsentšwego lenaneong la ISI. O na le kwano ya dinyakišišo le Sehlopha sa Ditšhelete sa Robust (Robust Finance Group) mo Yunibesithing ya Bielefeld (Germany) le mo Instituteng ya Ekonomi ya Lefase (Kiel, Germany). Profesa Ziemper o na le tekanyetšo ya B3 go tšwa go NRF.

This award is given to exceptional young achievers in the field of research, as seen against the University’s strategic goals of achieving academic excellence, international competitiveness and local relevance. Any person who has been evaluated by the NRF as a P-rated researcher automatically enjoys Exceptional Young Researcher status.
Hierdie toekenning word op grond van uitnemende prestasie aan jong akademici op die gebied van navorsing gemaak, gesien in die lig van die Universiteit se strategiese doelwitte van akademiese uitnemendheid, internasionale mededingendheid en plaaslike relevansie. Enige persoon wat deur die NNS as ‘n P-gegradeerde navorser geëvalueer word, verkry outomaties die status van ‘n Uitnemende Jong Navorser.
Banyakišiši ba baswa ba go Atlegilego go fetiša Sefoka se se abelwa baatlegi ba go tšwelela ka magetla lekaleng la dinyakišišo, bjalo ka ge go laeditšwe ka lenaneong la maano a Yunibesithi a go fihlelela bothakga, phenkgišano ya boditšhabatšhaba le maswanedi a selegae. Motho mang le mang yo a lekotšwego ke NRF bjalo ka monyakišiši wa maemo P o kgotsofatša dinyakwa tša gotsenela legoro la Monyakišiši o Moswa wa go atlega go fetiša.



Exceptional Young Researchers
Uitnemende Jong Navorsers
Banyakišiši ba baswa bao ba Atleilego Kudu
Professor Coetzee is an associate professor in the Department of Accounting in the Faculty of Economic and Management Sciences. He teaches an intermediate level accounting course and has taken a leading role in the accounting education component of the Department’s staff development programme and the master’s and PhD programmes. Because of his passion for teaching, both his master’s and PhD (supervised by Professor Elizabeth Gammie from Aberdeen Business School, Robert Gordon University) were on Accounting Education. His evidence-based teaching is informed by research aimed at improving the teaching of accounting.
Professor Coetzee has co-authored the first paper published by South African-based authors in Issues in Accounting Education (A rated on the Australian Business Deans Council (ABDC) Journal Ranking List) and the Journal of Accounting Education (B rated). To date, he has published three co-authored papers in Issues in Accounting Education.
He is ranked joint 10th out of 598 scholars on the Brigham Young University Accounting Education Research rankings and is the highest ranked South African scholar. Both these rankings have contributed to the University of Pretoria’s excellent reputation in the teaching of Accounting. The University is ranked third out of 252 institutions on the rankings and the Department of Accounting is ranked in the 151 to 200 accounting departments on the QS World University Rankings by Subject 2016 - Accounting & Finance.
Professor Coetzee is a member of the editorial review boards of Issues of Accounting Education and Accounting Education. At present, he is guest associate editor for a special edition of Accounting Education that will contain papers of relevance to accounting education in Africa. In January 2017 he was appointed associate editor of Accounting Education. Locally, he has served as editor of Meditari Accountancy Research (DHET accredited) and has been an ad hoc reviewer for several local and international conferences and publications. He has received several local and international grants in support of research and teaching. He is a member of the teaching committees of the American Accounting Association’s Teaching, Learning and Curriculum Sections Research and the International Financial Reporting Standards (IFRS). On the basis of his evidence-based teaching he recently received institutional and national teaching awards, including a National Excellence in Teaching and Learning Award (2016) from the CHE and HELTASA (in conjunction with A Schmulian).
Professor Coetzee is ʼn medeprofessor in die Departement Rekeningkunde in die Fakulteit Ekonomiese en Bestuurswetenskappe. Hy gee klas in intermediêre vlak Rekeningkunde en speel ʼn belangrike rol in die rekeningkundige onderrigkomponent van die Departement se personeelontwikkelingsprogram en die meesters- en PhD-programme. Aangesien hy ʼn passie vir onderrig het, was beide sy meesters- en sy PhD-graad (onder leiding van professor Elizabeth Gammie van Aberdeen Business School, Robert Gordon Universiteit) oor rekeningkundeonderrig. Sy bewysgebaseerde onderrig berus op navorsing en is daarop gemik om die onderrig van rekeningkunde te verbeter.
Professor Coetzee was ʼn mede-outeur van die eerste artikel deur Suid-Afrikaanse outeurs in Issues in Accounting Education en die Journal of Accounting Education. Tot op hede was hy mede-outeur van drie artikels in Issues in Accounting Education.
He is tiende uit 598 akademici geplaas op die Brigham Young Universiteit Rekeningkundeonderrig navorsingsranglys en is die hoogste geplaaste Suid-Afrikaanse akademikus. Beide hierdie plasings dra by tot die Universiteit van Pretoria se uitstekende reputasie in rekeningkundeonderrig.
Professor Coetzee is ʼn redaksionele lid van Issues of Accounting Education en Accounting Education. Op die oomblik is hy medegasredakteur van ʼn spesiale uitgawe van Accounting Education wat artikels van belang vir rekeningkundeonderrig in Afrika sal bevat. In Januarie 2017 is hy aangestel as mederedakteur van Accounting Education. Plaaslik het hy as redakteur van Meditari Accountancy Research (DHET geakkrediteer) gedien en hy was ʼn ad hoc-keurder vir verskeie plaaslike en internasionale konferensies en publikasies. Hy het verskeie plaaslike en internasionale finansiële toekennings ontvang ter ondersteuning van sy navorsing en onderrig. Hy is ʼn lid van onderrigkomitees van die American Accounting Associations’ Teaching, Learning and Curriculum Sections Research en die International Financial Reporting Standards (IFRS). Op grond van sy bewysgebaseerde onderrig het hy onlangs institusionele en nasionale onderrigtoekennings, insluitend ʼn National Excellence in Teaching and Learning-toekenning (2016) CHE en ʼn HELTASA (in samewerking met A Schmulian), ontvang.
Profesa Coetzee ke mothuša profesa ka Kgorong ya Sešupatlotlo ka Lefapheng la Disaense tša Ekonomi le Taolo. O ruta legato la gare la thutwana ya sešupatlotlo gomme o tšere maemo a boetapele ka karolong ya thuto ya sešupatlotlo ya lenaneo la tšwelotšopele ya badirišani ba Kgoro le mananeo a mastase le PhD. Ka lebaka la lerato la gagwe mo go ruteng, bobedi mastase le PhD tša gagwe (tšeo a hlahlilwego ke Profesa Elizabeth Gammie go tšwa Sekolong sa Kgwebo sa Aberdeen, Yunibesithing ya Robert Gordon) di be di le ka Thuto ya Sešupatlotlo. Go ruta ga gagwe moo go theilwego godimo ga bohlatse go laetšwa ke dinyakišišo tše di ikemeišeditšego go kaonafatša go ruta sešupatlotlo.
Profesa Coetzee o ngwadile mmogo sengwalwa sa mathomo se se phatlaladitšwego ke bangwadi ba ba lego ka Afrika Borwa ka go Issues in Accounting Education le Journal of Accounting Education. Go fihla lehono, o phatlaladitše dingwalwa tše di ngwadilwego mmogo ka go Issues in Accounting Education.
O lekanyeditšwe maemong a bo 10 a kopanelo go tšwa go baithuti ba 598 mo go ditekanyetšo tša Dinyakišišo tša Thuto ya Sešupatlotlo ya Yunibesithi ya Brigham Young gomme o lekanyeditšwe godimo go feta ka moka go baithuti ba Afrika Borwa. Bobedi ditekanyetšo tše di kgathile tema go maemo a bokgoni a Yunibesithi a go ruta Sešupatlotlo.
Profesa Coetzee ke leloko la diboto tša ditshekatsheko tša go rulaganya tša Issues of Accounting Education and Accounting Education. Gonabjale, ke mothuša morulaganyi wa moeng wa kgatišo ya go ikgetha ya Accounting Education ye e tlo bago le dingwalwa tše di lebanego le thuto ya sešupatlotlo ka Afrika. Ka Pherokgong 2017 o thwetšwe bjalo ka mothuša morulaganyi wa Meditari Accountancy Research (e dumeletšwe ke DHET) gomme e be e le mosekaseki yo e sego wa semmušo wa dikhonferense le diphatlalatšo tše mmalwa tša gae le tša ditšhabatšhaba. O amogetše dithušo tša ditšhelete tše mmalwa tša gae le tša ditšhabatšhaba go thekga dinyakišišo le go ruta. Ke leloko la dikomiti tša Mekgatlo ya Sešupatlotlo ya Amerika tša Go ruta, Go ithuta le Dinyakišišo tša Dikarolo tša Lenaneothuto le Maemo a Go bega Ditšhelete tša Ditšhabatšhaba (IFRS). Ka motheo wa go ruta ga gagwe mo go theilwego godimo ga bohlatse kgauswanyana o amogetše difoka tša go ruta tša gae le tša ditšhabatšhaba, go akaretša le Sefoka sa Bokgoni bja Setšhaba bja Go ruta le Go ithuta (2016) tša CHE le HELTASA ( mmogo le A Schmulian).

Dr Coetzee is a senior lecturer in the Department of Genetics, the principal investigator of the Facial Morphology Research Group and an associate of the Institute for Food, Nutrition and Well-being (IFNuW).
Her work focuses on identifying affordable, non-invasive measures of health. More specifically, she studies what facial structure and colour can tell us about our health and genetic variability. Dr Coetzee’s group has, for instance, published various papers on the relationships between people’s facial appearance, nutrient intake, cardiovascular health and immunity. Current projects also aim to identify the genetic variability underlying facial appearance, especially health-related facial appearance in clinical and non-clinical populations. For instance, one study focuses on identifying the specific three-dimensional (3D) facial features associated with Down syndrome in African infants. These findings can be used to develop a facial screening tool to identify Down syndrome in young infants and will eventually be expanded to identify a variety of congenital conditions.
Dr Coetzee collaborates with various other researchers nationally and internationally. In 2015 she launched the African Longitudinal Facial Appearance and Health (ALFAH) study, which aims to collect 2D and 3D facial images, a variety of health measures and genotypic information on 4 000 young African adults over the next five to ten years. This work is done in collaboration with researchers from Penn State University in the United States and the University of Marburg, Germany.
In the past three years, Dr Coetzee was nominated as a member of the Royal Society of South Africa, received an Y1 rating from the NRF, and was a finalist in the National Science and Technology (NSTF) South 32 Emerging Researchers awards.
Dr Coetzee is ’n senior dosent in die Departement Genetika, die hoofondersoeker van die Gesigmorfologienavorsingsgroep en ’n genoot van die Instituut vir Voedsel, Voeding en Welstand (IVVW).
Haar werk fokus op die identifisering van bekostigbare, nie-indringende metings van gesondheid. Meer spesifiek bestudeer sy wat gesigstruktuur en -kleur vir ons kan sê oor gesondheid en genetiese veranderlikheid. Dr Coetzee se groep het byvoorbeeld verskeie referate gepubliseer oor die verhoudings tussen mense se gesigsvoorkoms, voedingstofinname, kardiovaskulêre gesondheid en immuniteit. Huidige projekte is ook daarop gemik om die genetiese veranderlikheid onderliggend aan gesigsvoorkoms te identifiseer, veral gesondheidsverwante gesigsvoorkoms in kliniese en niekliniese bevolkings. So fokus een studie op die identifisering van die spesifieke driedimensionele (3D) gesigseienskappe wat met Downsindroom by swart babas geassosieer word. Hierdie bevindings kan gebruik word om ’n gesigsiftingsinstrument te ontwikkel om Downsindroom by babas te identifiseer en sal later uitgebrei word om ’n verskeidenheid aangebore toestande te identifiseer.
Dr Coetzee werk saam met verskeie ander navorsers hier te lande en internasionaal. In 2015 het sy die African Longitudinal Facial Appearance and Health (ALFAH)-studie begin, wat beoog om oor die volgende vyf tot tien jaar 2D- en 3D-gesigsbeelde, ’n verskeidenheid gesondheidsmetings en genotipiese inligting van 4 000 jong swart volwassenes te versamel. Hierdie werk word gedoen in samewerking met navorsers van Penn State-universiteit in die Verenigde State en die Universiteit van Marburg, Duitsland.
Die afgelope drie jaar is dr Coetzee as ’n lid van die Royal Society of South Africa benoem, het sy ’n Y1-gradering van die NNS ontvang en was sy ’n finalis in die Nasionale Wetenskap en Tegnologie (NWT) Suid 32 Ontluikende Navorsers-toekennings.
Ngaka Coetzee ke mofahlošimogolo ka Kgorong ya Leabela, monyakišišimogolo wa Sehlopha sa Dinyakišišo sa Mofolotši wa Sefahlego le modirišani wa Institute ya Dijo, Phepo le Go phela gabotse (IFNuW).
Mošomo wa gagwe o nepiša go utolla mekgwa ya go phela yeo batho ba ka e kgonago, gape ya go se ame dilo tše kotsi mo mmeleng. Kudu, o ithutile seo sebopego sa sefahlego le mmala se ka re botšago ka maphelo a rena le go fetogafetoga ga leabela. Sehlopha sa Ngaka Coetzee se, mohlala, phatlaladitše dingwalwa tša go fapana ka ga dikamano gare ga ponagalo ya difahlego tša batho, go ja tša go fepa mmele, maphelo a pelo le tšhireletšo. Diprotšeke tša gonabjale le tšona di ikemišeditše go utolla go fetogafetoga ga leabela mo go sa utollwago ga ponagalo ya sefahlego, kudu ponagalo ya sefahlego yeo e amanago le maphelo mo bathong bao go dirwago diteko tša kalafo le bao go sa dirwego diteko tša kalafo. Mohlala, nyakišišo ye nngwe e ikemišeditše go utolla dibopego tše di itšego tša mahlakore a mararo (3D) a sebopego sa sefahlego se se amanago le maemo a go se itekanele mmeleng mo maseeng a Maafrika. Dikutollo tše di ka šomišwa go tšweletšapele setšweletšwa sa tekolo ya sefahlego go lemoga maemo a go se itekanele mmeleng mo maseeng a mafsa gomme mafelelong se tla katološetšwa go utolleng mehuta ya maemo ao motho a belegwago le wona.
Ngaka Coetzee o dirišana le banyakišiši ba bangwe mo gae le ditšhabatšhabeng. Ka 2015 o thakgotše nyakišišo ya Maphelo le Ponagalo ya Sefahlego ya Lesetafase ya Afrika (ALFAH), yeo e ikemišeditšego go kgobokanya mahlakore a mabedi (2D) le diswantšho tša sefahlego, mekgwa ya go fapana ya maphelo le tshedimošo ya leabela le le fetišetšwago go bafsa ba bagolo ba Maafrika ba 4 000 mo mengwageng ye mehlano go iša go ye lesome ye e latelago. Mošomo wo o dirwa ka tirišano le banyakišiši go tšwa Yunibesithing ya Penn State ka Amerika le Yunibesithi ya Marburg, Germany.
Mo mengwageng ye meraro ya go feta, Ngaka Coetzee o kgethilwe bjalo ka leloko la Lekgotla la Royal la Afrika Borwa, o amogetšetekanyetšo ya Y1 go tšwa go NRF, gomme o bile makgaolakganyeng mo go difoka tša Banyakišiši ba Bafsa ba 32 ba Borwa ka Theknolotši le Saense tša Setšhaba (NSTF).

Dr Crole is a veterinarian and senior lecturer in the Department of Anatomy and Physiology in the Faculty of Veterinary Science. She teaches Veterinary Comparative Anatomy and Veterinary Histology to undergraduate and a number of postgraduate students. Her research covers comparative macro-anatomy, histology and electron microscopy. She is a council member of the Anatomical Society of Southern Africa and an active member of the Microscopy Society of Southern Africa.
Dr Crole’s area of expertise is the upper digestive tract of commercially farmed ratites. She has published a number of key papers in this field, including the first definitive evidence of a sense of taste in ratites and the description of a novel anatomical mechanism that prevents these birds from choking. She has identified pharyngeal tonsils in the ostrich and emu, which are not present in other birds. In her PhD thesis, Dr Crole described the presence of a well-developed bill tip organ in the ostrich and emu and demonstrated the functions of certain unique features in the bill tip. This has helped to shed light on the presence and significance of this sensory organ in these two birds, which aids palaeontologists in understanding bony structures found in extinct therapods. Her master’s students are working on parts of the anatomy of threatened southern African wildlife such as Temminck’s ground pangolin and the southern white rhinoceros. Results from these studies aid veterinarians in interpreting structures seen in diagnostic imaging and can inform treatment protocols.
Dr Crole received a Y1 rating from the NRF in 2016. She has received academic honorary colours, awards at anatomical society conferences for Best Poster and Best Medical Education presentations and an award at the Microscopy Society conference for Best Life Sciences Paper Published in an International Journal. Other awards included Young Lecturer of the Year, Young Researcher of the Year and a Certificate for Education Innovation.
Dr Crole is ʼn veearts en senior dosent in die Departement Anatomie en Fisiologie in die Fakulteit Veeartsenykunde. Sy gee aan voorgraadse en ʼn aantal nagraadse studente klas in Vergelykende Veeartsenykundige Anatomie en Veeartsenykundige Histologie. Haar navorsing dek vergelykende makro-anatomie, histologie en elektronmikroskopie. Sy is ʼn raadslid van die Anatomiese Vereniging van Suider Afrika en ʼn aktiewe lid van die Mikroskopie Vereniging van Suidelike Afrika.
Dr Crole se spesialisarea is die boonste verteringskanaal van kommersieelgeteelde loopvoëls. Sy het ʼn aantal sleutelreferate op die gebied gepubliseer, insluitend die eerste onweerlegbare bewyse dat loopvoëls ʼn smaaksintuig het en die beskrywing van ʼn nuwe anatomiese meganisme wat keer dat hierdie voëls verstik. Dr Crole het faringeale mangels, wat nie in ander voëls voorkom nie, in die volstruis en emu geïdentifiseer. Op grond van haar PhD-tesis, het sy die teenwoordigheid van ʼn goed geplaasde snawelpunt-orgaan in die volstruis en emu beskryf en sekere unieke funksies van die snawelpunt gedemonstreer. Dit het gehelp om lig te werp op die teenwoordigheid en belangrikheid van dié sensoriese orgaan in die twee voëlspesies. Hierdie resultate help paleontoloë om die benerige strukture wat in uitgesterfde terapode gevind word, te verstaan. Haar meestersstudente werk op dele van die anatomie van bedreigde suider Afrikaanse wildlewe, soos Temminck se ietermago en die suidelike witrenoster. Resultate van hierdie studies help veeartse om die strukture wat in diagnostiese beelde gesien word, te interpreteer, en kan behandelingsprotokols bepaal.
Dr Crole het in 2016 ʼn Y1-gradering van die NNS ontvang. Sy het toekennings ontvang soos akademiese erekleure, Beste Plakkaat- en Beste Medieseonderrigaanbieding by anatomiekonferensies, asook ʼn toekenning van die Mikroskopie Vereniging vir die Beste Lewenswetenskappe Artikel Gepubliseer in ʼn Internasionale Tydskrif. Ander toekennings sluit in Jong Dosent van die Jaar, Jong Navorser van die Jaar en ʼn Sertifikaat vir Onderwysinnovering.
Ngaka Crole ke ngaka ya diphoofolo le mofahlošimogolo ka Kgorong ya Anatomi le Fisiolotši ka Lefapheng la Disaense tša Bongakadiruiwa. O ruta baithuta ba baithutelatikrii le ba mmalwa ba dialogadigolwane Anatomi ya Papetšo ya Diphoofolo le Histolotši ya Diphoofolo. Nyakišišo ya gagwe e akaretša papetšo ya maekro-anatomi, histolotši le maekroskopi wa elektrone. Ke leloko la khansele ya Lekgotla la Anatomi la Borwa bja Afrika le leloko le le šomago la Lekgotla la Maekroskopi la Borwa bja Afrika.
Karolo ya Ngaka Crole ya bokgoni ke tsela ya tšhilego ya dijo ya ka godimo ya dinonyana tše dikgolo tša temo ya kgwebo. O phatlaladitše dingwalwa tše mmalwa tša motheo ka karolong ye, go akaretša bohlatse bja nnete bja mathomo bja sekwi sa mohlodi ka dinonyaneng tše dikgolo le tlhalošo ya mokgwa wa anatomi ya go se tlwaelege yeo e thibelago dinonyana tše go kgama. O utollotše dithaka tša lešoba la mogolo mo go mpšhe le emu, tšeo di se bego gona go dinonyana tše dingwe. Go tšwa go PhD ya gagwe, Ngaka Crole o hlalošitše go ba gona ga ditho tša ka fase ga molomo mo go mpšhe le emu gomme a bontšha mošomo wa dibopego tša moswananoši tša ditho tša ka fase ga molomo. Se se thušitše go hlaloša ka go ba gona le bohlokwa bja setho se sa dikwi mo dinonyaneng tše tše pedi, tšeo di thušago ditsebi tša phaleontolotši go kwešiša dibopego tša marapo tše di hwetšwago mo go ditherapote tše di lahlilwego. Baithuti ba gagwe ba mastase ba šomana le dikarolo tša anatomi ya tšhošetšo ya dimedi le diphedi tša tlhago tša borwa bja Afrika go swana le kgaga le tšhukudu. Dipoelo go tšwa dinyakišišong tše di thušitše dingaka tša diphoofolo go hlatholla dibopego tše di bonwego seswantšhong sa phekolo gomme di ka bolela gore go latelwe magato afe a kalafo.
Ngaka Crole o amogetše tekanyetšo ya Y1 go tšwa go NRF ka 2016. O amogetše difoka tša mebala ya tlhompho ya thuto mo khonferenseng ya lekgotla la anatomi tša dikabo tša Seswantšho sa Bokgoni bja go feta ka moka le Thuto ya Kalafo ya Bokgoni bja go feta ka moka le sefoka khonferenseng ya lekgotla la Maekroskopi sa Sengwalwa se se Phatlaladitšwego sa Disaense tša Bophelo tša bokgoni bja go feta ka moka mo Jenaleng ya Ditšhabatšhaba. Difoka tše dingwe di akareditše Mofahloši wa Ngwaga yo Mofsa, Monyakišiši yo Mofsa wa Ngwaga le Setifikeiti sa Tšwelotšopele ya Thuto.

Dr Hurley is a senior lecturer in the Department of Zoology and Entomology in the Faculty of Natural and Agricultural Sciences, and a research leader of the Tree Protection Cooperative Programme (TPCP) and the DST Centre of Excellence in Tree Health Biotechnology (CTHB) at the Forestry and Agricultural Biotechnology Institute (FABI).
His current research interests include various biological control systems and other areas relevant to tree health, such as genetic diversity of pest populations, microbial–insect associations and pathway management of invasive species. His research has yielded insight into the factors that influence the global spread and management of forest insect pests. He is currently involved in initiating a project to increase the capacity for the biological control and general integrated pest management of forest insect pests in Africa.
Dr Hurley is very involved in postgraduate training; he has supervised or co-supervised six PhD, two MSc and two honours degrees, and is currently the primary advisor for two PhD and four MSc students. He is involved in undergraduate training at the University of Pretoria and has given guest lectures at other universities. He has reviewed papers for 17 scientific journals and is the assistant editor for the International Journal of Pest Management. He has published 35 papers in ISI rated journals, including the highest impact journal in his field, and authored six book chapters. Dr Hurley’s publications have elicited 774 citations. He was awarded a Y1 rating by the NRF in 2014.
He enjoys extensive international recognition and exposure for his research. He has presented at 19 international meetings (eight invited, one keynote), authored 42 international presentations, and organised five international congress sessions. He has been involved in organising various scientific meetings and workshops, participated in international research panels and collaborative projects, and consulted nationally and internationally on issues of tree health. Dr Hurley is deputy coordinator for the International Union of Forest Research Organizations (IUFRO) Working Unit on the Biological Control of Forest Insects and Pathogens and a member of the IUFRO Task Force for Biological Invasions in Forests.
Dr Hurley is ’n senior dosent in die Departement Dierkunde en Entomologie in die Fakulteit Natuur- en Landbouwetenskappe en ‘n navorsingsleier van die Samewerkingsprogram vir Boombewaring (SPBB) en die DWT-sentrum vir Uitnemendheid in Boomgesondheidbiotegnologie in die Instituut vir Bosbou- en Landboutegnologie (FABI).
Sy huidige navorsingsbelangstellings sluit verskeie biologiese beheerstelsels in, asook ander terreine rakende boomgesondheid, soos genetiese diversiteit van plaagbevolkings, mikrobe–insek-assosiasies en roetebestuur van indringerspesies. Sy navorsing lewer insig in die faktore wat die wêreldwye verspreiding en bestuur van woudinsekplae beïnvloed. Hy is tans betrokke by die inisiëring van ’n projek om die kapasiteit vir die biologiese beheer en algemene geïntegreerde plaagbeheer van woudinsekplae in Afrika te vergroot.
Dr Hurley is baie betrokke by nagraadse opleiding; hy was studieleier of medestudieleier van ses PhD-, twee MSc- en twee honneursgraadstudente en is tans die primêre adviseur vir twee PhD- en vier MSc-studente. Hy is betrokke by voorgraadse opleiding aan die Universiteit van Pretoria en het gaslesings by ander universiteite gelewer. Hy het referate vir 17 wetenskaplike joernale geresenseer en is die assistentredakteur van die International Journal of Pest Management. Hy het 35 referate in ISI-gegradeerde joernale gepubliseer, insluitende die joernaal met die hoogste impak op sy gebied, en hy het ses boekhoofstukke geskryf. Dr Hurley se publikasies het tot 774 sitasies gelei. Hy het in 2014 ’n Y1-gradering van die NNS ontvang.
Hy geniet uitgebreide internasionale erkenning en blootstelling vir sy navorsing. Hy het referate gelewer op 19 internasionale byeenkomste (agt genooi, een geleentheidsrede), 42 internasionale aanbiedings geskryf en vyf internasionale kongressessies georganiseer. Hy was betrokke by die organisasie van verskeie wetenskaplike byeenkomste en werksessies, het aan internasionale navorsingspanele en samewerkingsprojekte deelgeneem en nasionaal en internasionaal gekonsulteer oor kwessies rakende boomgesondheid. Dr Hurley is adjunkkoördineerder vir die International Union of Forest Research Organizations (IUFRO) se Werkeenheid oor die Biologiese Beheer van Woudinsekte en Patogene en is lid van die IUFRO-taakspan vir Biologiese Indringing in Woude.
Ngaka Hurley ke mofahlošimogolo ka Kgorong ya Thutadiphoofolo le Entomolotši ka Lefapheng la Disaense tša Tlhago le Temo, le moetapele wa dinyakišišo wa Lenaneo la Tirišano la Tšhireletšo ya Mehlare (TPCP) le Senthara ya Bokgoni ya DST ka Payotheknolotši ya Maphelo (CTHB) mo Instituting ya Payotheknolotši ya Temo le Kagodikgwa (FABI).
Dikgahlego tša gagwe tša gonabjale tša nyakišišo di akaretša mekgwa ya go fapana ya go laola tlhago le dikarolo tše dingwe tšeo di lebanego le maphelo a mehlare, go swana le phapano ya leabela la disenyi, dikamano tša dikhunkhwane tša go fetetša le ditsela tša go laola dihlopha tša go tshwenya. Nyakišišo ya gagwe e tšweleditše temošo ka dilo tšeo di huetšago phatlalatšo ya lefase le taolo ya dikhunkhwane tša go senya tša dikgwa. Gonabjale o swaragane le go thoma protšeke go oketša bokgoni bja go laola tlhago le taolo ya disenyi tše di kopantšwego ka kakaretšo ya dikhunkhwane tša disenyi tša mehlare ka Afrika.
Ngaka Hurley o swaragane kudu le tlhahlo ya dialogadigolwane; o hlahlile le go hlahla mmogo ditikrii tše tshela tša PhD, tše pedi tša MSc le tše pedi tša honase, gomme gonabjale ke moeletšimogolo wa baithuti ba babedi ba PhD le ba bane ba MSc. O swaragane le tlhahlo ya baithutelatikrii mo Yunibesithing ya Pretoria gomme o file dithutophahlošo tša moeti mo diyunibesithing tše dingwe. O sekasekile dingwalwa tša dijenale tša saense tše 17 gomme ke mothuši wa morulaganyi wa International Journal of Pest Management. O phatlaladitše dingwalwa tše 35 ka dijenaleng tše di lekanyeditšwego tša ISI, go akaretša jenale ye e nago le khuetšo ya godimo mo karolong ya gagwe, gomme o ngwadile dikgaolo tša dipuku tše tshela. Diphatlalatšo tša Ngaka Hurley di tšweleditše ditsopolwa tše 774. O abetšwe tekanyetšo ya Y1 ke NRF ka 2014.
O ipshina ka temogo ye kgolo ya ditšhabatšhaba le go tsebega ga nyakišišo ya gagwe. O boletše dikopanong tša ditšhabatšhaba (tše seswai tšeo a laleditšwego, le ye tee yeo e bego e le seboledisegolo), o ngwadile dikabo tše 42 tša ditšhabatšhaba gomme a beakanya dikopano tša khonkrese ya ditšhabatšhaba. O dutše a swaragane le go beakanya dikopano tše mmalwa tša saense le ditlhahlo, o kgathile tema diphaneleng tša dinyakišišo tša ditšhabatšhaba le diprotšeke tša tirišano, gomme o kgokagane ka ditaba tša maphelo a mehlare mo gae le ditšhabatšhabeng. Ngaka Hurley ke motlatšamokgokaganyi wa Kopano ya Ditšhabatšhaba ya Mekgatlo ya Dinyakišišo tša Mehlare (IUFRO) ya Lekala la Go šoma ka Taolo ya Tlhago ya Dikhunkhwane tša Mehlare le Diphatotšene le leloko la Lekalatšhomo la Dihlaselo tša Tlhago ka Mehlareng.

Professor Malekian is an associate professor in the Department of Electrical, Electronic and Computer Engineering in the Faculty of Engineering, Built Environment and Information Technology. Before joining the University of Pretoria he was with the University of St Paul the Apostle in Macedonia.
Having 12 years’ experience in teaching and research in both the university and the industry sectors, he has maintained an active research programme and provided supervision and mentorship to several master’s and doctoral students, as well as postdoctoral fellows, under industry and government funding. Professor Malekian’s research focuses on the Internet of Things (IoT), sensors and smart cities. He is particularly interested in design and development of industrial applications using wireless sensors networks in the area of eHealth, intelligent transportation systems, mine safety, water management and agriculture. He has published more than 75 scholarly articles, conference papers, and book chapters with a significant number of the published work being journal articles. Two of his articles, ‘Modelling of nonlinear system based on deep learning framework’ and ‘An efficient authentication and access control scheme for perception layer of Internet of Things’, are highly cited on the Web of Science and rank among the top 1% based on the highly cited threshold for the academic field. Over the past two years Professor Malekian has been a visiting or guest professor at international universities such as the University of Porto (Portugal), the Vrije Universiteit Brussel (Belgium), the University of Maribor (Slovenia), Vilnius University (Lithuania) and the University of St Paul the Apostle (Macedonia).
He is registered as a chartered engineer with the Engineering Council of the UK, a senior member of the IEEE, a professional member of the British Computer Society , a member of ACM, and an NRF-rated researcher. He serves as an editor or associate editor for the IEEE Internet of Things Journal, IEEE Internet Initiative newsletter, IET Networks, IEEE Access, Journal of Internet Technology, KSII Transactions on Internet and Information Systems, and International Journal of Sensor Networks. He is also a guest editor for the IEEE Transactions on Intelligent Transportation Systems and has served on the technical programme committees of numerous IEEE Conferences. From 2013 to 2016 Professor Malekian was a management committee member of Autonomous Control for a Reliable Internet of Services (ACROSS) of the European Cooperation in Science and Technology (COST).
Professor Malekian is ʼn medeprofessor in die Departement Elektriese, Elektroniese en Rekenaar-Ingenieurswese in die Fakulteit Ingenieurswese, Bou-Omgewing en Inligtingstegnologie. Voordat hy by die Universiteit van Pretoria aangesluit het, was hy verbonde aan die Universiteit van St Paulus die Apostel in Masedonië.
Met 12 jaar se ondervinding in onderrig en navorsing in sowel die universiteit- as die industriesektor, handhaaf hy ʼn aktiewe navorsingsprogram en gee (studie)leiding aan verskeie meesters- en doktorale student, sowel as nadoktorale medewerkers, wat deel vorm van industrieen regeringsbefondsings. Professor Malekian se navorsing fokus op die ‘Internet van Goed’ (Internet of Things − IoT), sensors en slimstede. Hy stel veral belang in die ontwerp en ontwikkeling van industriële toepassings wat gebruik maak van koordlose sensor netwerke in die veld van eGesondheid, intelligente vervoerstelsels, mynveiligheid, waterbestuur en landbou. Hy het meer as 75 akademiese artikels, referate en hoofstukke in boeke gepubliseer, met tydskrifartikels wat ʼn aansienlike gedeelte van die gepubliseerde werk uitmaak. Twee van sy artikels, ‘Modelling of nonlinear system based on deep learning framework’ en ‘An efficient authentication and access control scheme for perception layer of Internet of Things’, is hoogs aangehaal op die Web of Science en tel onder die top 1% gebaseer op die hoogs aangehaalde drumpel vir die akademiese veld. Oor die afgelope twee jaar was professor Malekian ʼn besoekende of gasprofessor by internasionale universiteite soos die Universiteit van Porto (Portugal), die Vrije Universiteit Brussel (België), die Universiteit van Maribor (Slovenië), Vilnius Universiteit (Litoue) en die Universiteit van St Paulus die Apostel (Masedonië).
Hy is ʼn geregistreerde geoktrooieerde ingenieur by die Ingenieursraad van die VK, ʼn lid van die Instituut van Elektriese en Elektroniese Ingenieurs (IEEE), ʼn professionele lid van die Britse Rekenaarvereniging, ʼn lid van die Vereniging vir Rekenaarmasjiene (Association for Computing Machinery – ACM), en ʼn NNS-gegradeerde navorser. Hy dien as ‘n redakteur of subredakteur vir die IEEE Internet of Things Journal, die IEEE Internet Initiative-nuusbrief, IET Networks, IEEE Access, die Journal of Internet Technology, KSSII Transactions on Internet and Information Systems, en die International Journal of Sensor Networks. Hy is ook ʼn gasredakteur vir die IEEE Transactions on Intelligent Transportation Systems en het op die tegnieseprogramkomitees van verskeie IEEE-konferensies gedien. Van 2013 tot 2016 was professor Malekian ʼn lid van die bestuurskomitee van Outonome Beheer vir ʼn Betroubare Internet van Dienste (Autonomous Control for a Reliable Internet of Services –ACROSS) van die Europese Koöperasie in Wetenskap en Tegnologie (COST).
Profesa Malekian ke mothuša profesa ka Kgorong ya Boentšenere bja Khomphutha, Mohlagase le Elektroniki ka Lefapheng la Boentšenere, Tikologo ya Kago le Theknolotši ya Tshedimošo. Pele a šomela Yunibesithi ya Pretoria o be a šomela Yunibesithi ya St Paul the Apostle ka Macedonia.
Profesa Malekian o na le maitemogelo a mengwaga ye 12 mo go ruteng le dinyakišišong mo makaleng a bobedi yunibesithi le intasteri. O thekga lenaneo le le šomago la dinyakišišo gomme o hlahla baithuti ba mmalwa ba mastase le ba bongaka, gammogo le badirišani ba ka morago ga bongaka, mo mananeong a ao a thekgwago ka ditšhelete ke mmušo le intasteri. Nepo ya nyakišišo ya Profesa Malekian e mo go Internet of Things (IoT), disensara le smart cities. O na le kgahlego ye e itšego ya moakanyetšo le tšwelotšopele ya ditirišo ka karolo ya Maphelo a elektroniki, mekgwa ya dinamelwa ya bokgoni, tšhireletšo ya meepo, taolo ya meetse le temo.O phatlaladitše diathekele tša thuto tša go feta 75, dingwalwa tša dikhonferense, le dikgaolo tša dipuku ka palo ye kgolo ya mošomo wo o phatlaladitšwego e le diathekele tša dijenale. Tše pedi tša diathekele tša gagwe, ‘Modelling of nonlinear system based on deep learning framework’ le ‘An efficient authentication and access control scheme for perception layer of Internet of Things’ di tsopotšwe kudu mo Web of Science gomme di lekanyeditšwe go tše di beilwego godimo go 1% go tše di tsopotšwego kudu go fihla magomong mo karolong.
Mo mengwageng ye mebedi ya go feta Profesa Malekian e bile profesa ya moeti mo diyunibesithing tša ditšhabatšaba go swana le Yunibesithi ya Porto (Portugal), le Vrije Univeriteit Brussel (Belgium), Yunibesithi ya Maribor (Slovenia), Yunibesithi ya Vilnius (Lithuania) le Yunibesithi ya St Paul the Apostle (Macedonia). O ngwadišitše bjalo ka moentšenere wa sebalamatlotlo le Khansele ya Boentšenere ya UK, leloko la profešene la Lekgotla la Khomphutha la Britain, leloko la IEEE le Mokgatlo wa Khomphutha ya Metšhene (ACM), le monyakišiši yo a lekanyeditšwego ke NRF. O thuša botong ya go rulaganya goba ke mothuši wa morulaganyi wa IEEE Internet of Things Journal, kuranta ya IEEE Internet Initiative, IET Networks, IEEE Access, Journal of Internet Technology, KSSI Transactions on Internet and Information Sciences, le International Journal of Sensor Networks. Ke gape morulaganyi wa ketapele wa moeti wa IEEE Transactions on Intelligent Transportation Systems gape o thušitše dikomiting tša lenaneo la thekniki la dikhonferense tše mmalwa tša IEEE. Go tloga ka 2013 go fihla ka 2016 Profesa Malekian e be e le leloko la komiti ya taolo ya Taolo ya go Ikema ya Ditirelo tša Inthanete tša Go tshepega (ACROSS) ya Tirišano ya Yuropa ka Saense le Theknolotši (COST).

Dr Phulukdaree is a lecturer in the Department of Physiology in the Faculty of Health Sciences. Her research evaluates the molecular mechanisms involved in chronic inflammatory diseases such as heart disease, diabetes mellitus, and Parkinson’s and Alzheimer’s disease.
These diseases are major contributors to the high mortality rate associated with non-communicable diseases in South Africa. Noncommunicable chronic diseases are those that are not caused by infection and cannot be transmitted from one individual to another. They are predominantly the result of sedentary lifestyles. As part of her professional experience Dr Phulukdaree spent a month as visiting academic at the University of Manchester in November 2015. In 2016 she was a speaker at the leading epidemiology conference, EPICOH, in Barcelona, Spain. Over the past two years she became a member of the South African Young Academy of Science and was nominated to the Tuks Young Research Leader Programme and the Dean’s Young Research Leader Programme. In addition, Dr Phulukdaree received a Y rating from the NRF.
Dr Phulukdaree is ʼn dosent in die Departement Fisiologie van die Fakulteit Gesondheidswetenskappe. Haar navorsing evalueer die molekulêre meganismes wat by chroniese inflammatoriese siektes soos hartsiektes, diabetes mellitus, en Parkinson en Alzheimer se siekte betrokke is.
Hierdie siektes is van die grootste bydraende faktore tot die hoë sterftesyfer wat met nie-oordraagbare siektes in Suid-Afrika verbind word. Nie-oordraagbare chroniese siektes word nie veroorsaak deur infeksie nie en kan nie van een individu na ʼn ander oorgedra word nie. Hierdie siektes word grotendeels veroorsaak deur ʼn sittende leefstyl. As deel van haar professionele ervaring het dr Phulukdaree in November 2015 ʼn maand as besoekende akademikus by die Universiteit van Manchester deurgebring. In 2016 was sy ʼn spreker by die toonaangewende epidemiologiekonferensie, EPICOH, in Barcelona, Spanje. Oor die afgelope twee jaar het sy ʼn lid van die South African Young Academy of Science geword, en is sy vir die Tuks Jong Navorsingsleiersprogram en die Dekaan se Jong Navorsingsleiersprogram genomineer. Dr Phulukdaree ʼn Y-gradering van die NNS ontvang.
Ngaka Phulukdaree ke mofahloši ka Kgorong ya Fisiolotši ka Lefapheng la Disaense tša Maphelo. Nyakišišo ya gagwe e lekanya mekgwa ya molekhula ye e amegago ka malwetšing a go keka a go se fole go swana le bolwetši bja pelo, taepitisi, le malwetši a Parkinson le Alzheimer. Malwetši a ke wona a hlolago mahu a mantši ao a amanago le malwetši a go se fole ka Afrika Borwa. Malwetši a go se fole ke ao a sa hlolwego ke phetelo gomme a ka se fetetšwe go tloga go motho yo mongwe go ya go yo mongwe. Gantši ke dipoelo tša mekgwa ya go phela yeo batho ba fetšago nako ye ntši ba dutše fase. Bjalo ka karolo ya maitemogelo a gagwe a profešene Ngaka Phulukdaree o feditše kgwedi bjalo ka serutegi sa moeng Yunibesithing ya Manchester ka Dibatsela 2015. Ka 2016 e bile seboledi khonferenseng ya ketapele ya epidemolotši, EPICOH, ka Barcelona, Spain. Mo mengwageng ye mebedi ya go feta e bile leloko la Akademi ya Bafsa ya Saense ya Afrika Borwa gomme o kgethilwe go Lenaneo la Baetapele ba Dinyakišišo ba Bafsa la Tuks le Lenaneo la Baetapele ba Dinyakišišo ba Bafsa la Hlogo ya Lefapha. Go tlaleletša, Ngaka Phulukdaree o amogetše tekanyetšo ya Y go tšwa go NRF.

This award recognises the contribution of members of our academic staff who excel as supervisors of postgraduate research students. The award is made on the grounds of exceptional performance measured in terms of the students’ academic achievement. Evidence of excellent mentorship and guidance provided to young researchers and academic scholars are also taken into consideration.
Hierdie toekenning gee erkenning aan die bydrae van ons akademiese personeel wat uitblink as toesighouers van nagraadse navorsingstudente. Die toekenning word gedoen op grond van besondere prestasie gemeet aan die studente se akademiese prestasie. Bewyse van uitstekende mentorskap en leiding aan jong navorsers en akademiese vakkundiges word ook in ag geneem.
Difoka tše di lemoga tema yeo e kgathilwego ke maloko a badirišani ba thuto bao ba šomilego gabotse bjalo ka balekodi ba baithuti ba nyakišišo ya dialogadigolwane. Difoka di dirwa ka mabaka a phethagatšo ya go ikgetha yeo e lekanywago go ya ka diphihlelelo tša thuto tša baithuti. Bohlatse bja tlhahlo ye botsebotse le tlhahlo ye e filwego banyakišiši ba bafsa le baithuti ba thuto le bona ba lebeledišišwa.


Vice-Chancellor’s Award for Excellent Supervision
Visekanselier se Toekenning vir Uitnemende Studieleiding
Sefoka sa Batlatšabakhanseliri sa Bokgoni bja Bolekodi
The 2016 Excellent Postgraduate Supervisor’s Award is awarded to Professor Nigel Bennett.
Citation:
Professor Bennett is a professor of Zoology at the University of Pretoria and he is also the incumbent of the South African Research Chairs Initiative (SARChI) Chair in Mammalian Behavioural Ecology and Physiology and the Austin Roberts Chair of African Mammology.
Professor Bennett’s research is focused on ecology, animal physiology, and animal behaviour. He and his co-workers and students study the socio-biology of African rodent moles and the various factors that have led to the development of sociality and reproduction control in this remarkable endemic African family.
After completing his PhD at the University of Cape Town, Professor Bennett pursued a highly successful research career spanning some three decades. He now holds an A rating from the NRF and has authored or co-authored more than 300 research publications. He has supervised the completion of higher degrees by 25 master’s students, (of whom 20 received their degrees cum laude), and 13 PhDs, and he has mentored 25 postdoctoral and research fellows. Of these students, 75% have been from previously disadvantaged groups. His students speak of him as a dedicated and meticulous, but caring supervisor who inspires his students and, in particular, supports them in publishing excellent work and in building their own research careers.
Die 2016 Toekenning vir Uitnemende Toesighouer word toegeken aan professor Nigel Bennett.
Sitaat:
Professor Nigel Bennett is ʼn professor in Dierkunde aan die Universiteit van Pretoria en hy beklee ook die South African Research Chairs Initiative (SARChI)-leerstoel in Soogdiergedragsekologie en -fisiologie en die Austin Roberts-leerstoel in Afrikasoogdierkunde.
Professor Bennett se navorsing fokus op ekologie, dierefisiologie en dieregedrag. Hy en sy medewerkers en studente bestudeer die sosiobiologie van Afrika knaagdiermolle en die verskeie faktore wat gelei het tot die ontwikkeling van sosialiteit en reproduksiebeheer in hierdie merkwaardige inheemse Afrika-familie.
Nadat hy sy PhD aan die Universiteit van Kaapstad voltooi het, het professor Bennett vir ongeveer drie dekades ʼn hoogs suksesvolle beroep as navorser gevolg. Hy het nou ʼn A-gradering van die NNS en is outeur of mede-outeur van meer as 300 navorsingspublikasies. Hy was studieleier vir die voltooiing van hoër grade vir 25 meestersstudente (van wie 20 hul grade met lof verwerf het) en 13 PhDs, en hy het 25 postdoktorale genote gementor. Van hierdie studente was 75% uit voorheen benadeelde groepe afkomstig. Sy studente beskryf hom as ʼn toegewyde en noukeurige, dog sorgsame, studieleier wat sy studente inspireer en, in besonder, ondersteun om uitstekende werk te publiseer en hulle eie navorsingsloopbane te bou.
Sefoka sa Molekodi wa Dialogadigolwane yo A šomilego gabotse ka 2016 se abetšwe Profesa Nigel Bennett.
Temana:
Profesa Nigel Bennett ke Profesa ya Thutadiphoofolo mo Yunibesithing ya Pretoria gomme gape ke mong wa Setulo sa Lenaneo la Ditulo tša Dinyakišišo tša Afrika Borwa (SARChI) ka ga Ekolotši ya Maitshwaro a Diamuši le Fisiolotši le Setulo sa Austin Roberts sa Diamuši tša Afrika. Nyakišišo ya Profesa Bennet e nepiša ekolotši, fisiolotši ya diphoofolo, le maitshwaro a diphoofolo. Yena le bašomimmogo le baithuti ba ithuta payolotši ya leago ya diamuši tše dinyenyane le mabaka a go fapana ao a dirilego gore go be le tšwelotšopele ya leago le taolo ya tswalo go lapa le la Afrika la tlhago ya go makatša.
Ka morago ga go phetha PhD ya gagwe Yunibesithing ya Cape Town, Profesa Bennett o latetše mošomo wa dinyakišišo tše di atlegilego kudu a akaretša dipaka tše dingwe tše 3. Gonabjale o na le tekanyetšo ya A go tšwa go NRF gomme o ngwadile le go ngwala mmogo diphatlalatšo tša dinyakišišo tša go feta 300. O lekotše go phethwa ga ditikrii tša godimo ke baithuti ba mastase ba 25, (moo ba 20 ba bona ba amogetšego ditikrii tša bona ka dihlora), le diPhD tše 13, gomme o eleditše badirišani ba ka morago ga bongaka le ba dinyakišišo. Go baithuti ba, 75% ke ba go tšwa dihlopheng tšeo di bego di sa hlokomelwe pele. Baithuti ba bolela gore ke molekodi wa go ikgafa gape wa go nepagala, eupša wa tlhokomelo yoo a hlohleletšago baithuti ba gagwe le, kudu, go ba thekga ka go phatlalatša mošomo wo mobotse le go aga mešomo ya bona ya dinyakišišo.

The Laureates are awarded to nominated projects that display teaching practices with clear purpose and intent, with strong alignment between the different elements in the broader context, that address identified needs or gaps with the aim of innovation to optimise teaching and learning. These nominations show significant evidence of impact on student learning, are sustainable and can be replicated in other contexts. These projects contribute to best practice in teaching and display significant evidence of innovation that addresses the identified challenges.
Die Laureaattoekennings word gemaak aan genomineerde projekte wat bewys lewer van onderrigpraktyke met duidelike doelwitte en goeie belyning tussen die verskillende elemente in die breër konteks, wat spesifieke behoeftes of gapings aanspreek en innovasie ten doel het om onderrig en leer te optimaliseer. Hierdie nominasies lewer betekenisvolle bewys van impak op studente-leer, is volhoubaar en kan in ander kontekste herhaal word. Die projekte dra by tot beste praktyk in onderrig en toon innovasie wat geïdentifiseerde uitdagings aanspreek.
Ba Laureates ba abetšwe go kgetho ya diprotšeke tšeo di bontšhago ditirišo tša go ruta ka maikemišetšo ao a bonagalago le go ikemišetša, ka peakanyo ya go tia gare ga dikokwane tša go fapana ditikologong ka bophara, tšeo di šoganago le dinyakwa tše di lemogilwego goba dikgoba ka maikemišetšo a botšo a go kaonafatša go ruta le go ithuta. Dikgetho tše di bontšha bohlatse bjo bohlokwa bja khuetšo mo go ithuteng ga baithuti, e a thekgwa gomme e ka dirišwa ditikologong tše dingwe. Protšeke tše di kgatha tema go tirišo ye botse ya go ruta gomme di bontšha bohlatsebjo bohlokwa go botšo bjo šoganago le ditlhotlo tše di lemogilwego.



Teaching Excellence Laureate Awards 2017
Laureaattoekennings vir Uitnemendheid in Onderrig 2017
Difoka tša Laureate tša Bokgoni bja Go ruta tša 2017
Professor Wolff has been a student for a long time. During the last 13 years his studies consisted of lecturing and researching in the Department of Philosophy in the Faculty of Humanities. In doing so, he became professor of philosophy.
His background is in phenomenology and hermeneutics, broadly construed, but over the last decade, he has also consciously expanded his scholarly competence to include aspects of the Frankfurt School, African philosophy and social theory. The heart of his work consists of studying the complexities of the meaning of human interaction. This is done both in research and in teaching.
On the teaching side, this major concern is pursued by keeping human interaction central to the teaching. Learning is a human action and can be enhanced by human interaction, as in student-student and student-lecturer interactions in appropriately supportive environments. Since students have to study in a shifting social, political, pedagogical and academic context, Professor Wolff engages with teaching through responsible experimentation with curriculum design, teaching strategies and lecturer-student interactions.
On the research side, Professor Wolff is working on an integrated theory of the technicity of action or, what could also be called, a critical social theory of the technical dimension of human action. This theory is conceived as a hermeneutic anthropology of human capabilities and incapabilities. The thesis underlying this project is that the largest part of human action is characterised (to varying degrees) by a “technical” aspect. This theory will be “integrated” by pursuing the theme of the technicity of action through all dimensions of human action (individual, interpersonal, organised, institutionalised), and in all spheres of human action (work, communication, recreation, politics, etc). The general aim of the project is to clarify the diverse, complementary and conflicting ways in which human cultures provide people with a second nature, that is, the acquired ways and means by which we act and interact under the current contingent regimes of modernities. At the same time this project engages with the ethico-political question of how to orientate oneself in a world constructed by heterogeneously socialized people.
A former Fellow of the Kulturwissenschaftliches Institut (Esssen) and currently a research associate of the École des Hautes Études en Sciences Sociales (Paris), Professor Wolff is an NRF B rated researcher and an alumnus of the Alexander von Humboldt Stiftung.
Professor Wolff is lank reeds ʼn student. Oor die afgelope 13 jaar het sy studie bestaan uit klasgee en navorsing in die Departement Filosofie in die Fakulteit Geesteswetenskappe. In die proses het hy professor van filosofie geword.
Sy agtergrond is fenomenologie en hermeneutiek in die breë, maar oor die afgelope dekade het hy sy wetenskaplike vermoëns doelbewus uitgebrei om aspekte van die Frankfurt Skool, Afrika filosofie en sosiale teorie in te sluit Die hart van sy werk is die studie van die kompleksiteite van die betekenis van menslike interaksie. Dit word gedoen in sowel navorsing as onderrig.
Aan die onderrigkant word hierdie doelwit nagestreef deur menslike interaksie sentraal tot onderrig te hou. Om te leer is ʼn menslike aksie en dit kan deur menslike interaksie, soos student-student en student-dosent interaksies in toepaslik ondersteunende omgewings, versterk word. Aangesien studente in ʼn veranderende sosiale, politieke, opvoedkundige en akademiese konteks moet studeer, benader professor Wolff onderrig deur middel van verantwoordelike eksperimentering met kurrikulumontwikkeling, onderrigstrategieë en dosent-student wisselwerking.
Aan die navorsingskant werk professor Wolff aan ʼn geïntegreerde teorie van die tegnisiteit van handeling, of, soos dit ook genoem kan word, ʼn kritiese sosiale teorie van die tegniese dimensie van menslike handeling. Hierdie teorie word gekonsipieer as ʼn hermeneutiese antropologie van menslike vermoëns en onvermoëns. Die tese wat onderliggend aan die projek is, is dat die grootste deel van menslike handeling (in wisselende grade) gekenmerk word deur ʼn “tegniese” aspek. Hierdie teorie is “geïntegreer” in die sin dat die tema van tegnisiteit van handeling deur alle dimensies van menslike interaksie (individueel, interpersoonlik, georganiseerd, geïnstitusionaliseer) en in alle sfere van menslike handeling (werk, kommunikasie, ontspanning, politiek, ens) ondersoek word. Die algemene doel van die projek is om die diverse, komplementêre en konflikterende wyses waarop menslike kulture persone met ʼn tweede natuur toerus, (maw die aangeleerde maniere en middele waardeur ons onder die huidige bestel van moderniteite met mekaar in wisselwerking is), te verhelder. Terselfdertyd betrek die projek die eties-politieke vraag van hoe ʼn mens jouself in ʼn wêreld wat bestaan uit heterogeen gesosialiseerde mense, moet oriënteer.
Professor Wolff is ʼn voormalige Genoot van die Kulturwissenschaftliches Institut (Esssen) en huidige navorsingsmedewerker van die École des Hautes Études en Sciences Sociales (Parys). Hy het ʼn B-gradering van die NNS en is ʼn alumnus van die Alexander von Humboldt Stiftung.
Profesa Wolf ebile moithuti nako ye telele. Mo nakong ya mengwaga ye 13 ya go feta dithuto tša gagwe di akareditše go fahloša le go nyakišiša ka Kgorong ya Filosofi ka Lefapheng la Bomotho. Ka go dira bjalo, a ba profesa ya filosofi.
Botšo bja gagwe bo go Fenomenolotši le Mekgwa ya Tlhathollo, tšeo di hlathollwago ka bophara, eupša mo nakong ya go feta, o katološitše bokgoni bja gagwe bja dithuto go akaretša dikarolo tša Sekolo sa Frankfurt, filolosifi ya Seafrika le teori ya leago. Kgwekgwe ya mošomo wa gagwe e akaretša go ithuta ditharagano tša tlhalošo ya tsenelelano ya batho. Se se dirwa ka bobedi mo dinyakišišong le go ruteng.
Ka lehlakoreng la go ruta, bohlokwa bjo boglo bo latelwa ka go dira gore go be le tsenelelano ya batho mo gare ga go ruta. Go ithuta ke tiro ya batho gomme e ka kaonafatšwa ka tsenelelano ya batho, go swana le tsenelelano ya moithuti le moithuti le moithuti le mofahloši mo ditikologong tša thekgo ya maleba. Ka ge baithuti ba swanelwa ke go ithuta tikologong ya thuto, serutiši, dipolotiki le leago, Profesa Wolff o swaragane le go ruta ka boitekelo bja maikarabelo ka moakanyetšo wa lenaneothuto, mekgwa ya go ruta le ditsenelelano tša mofahloši le moithuti.
Ka lehlakoreng la dinyakišišo, Profesa Wolff o šoma ka teori ye e kopantšwego ya tiro ya thenkini goba, seo se ka bitšwago gape, teori ya leago ye bohlokwa ya karolo ya thekniki ya tiro ya motho. Teori ye e tšewa go ba antropolotši ya mokgwa wa tlhathollo wa mabokgoni le go se kgone ga motho. Kgopolo ye e hlohleletšago protšeke ye ke gore karolo ye kgolo go feta ka moka ya tiro ya motho e tlhalošwa (go magato a go fapana) ke karolo ya “thekniki”. Teori ye e tla “kopanywa” ka go latela sererwa sa thekniki ya tiro mo dikarolong ka moka tša tiro ya motho (mošomo, kgokagano, boitapološo, dipolotiki, bjalobjalo). Maikemišetšomagolo a protšeke ke go tlhaloša mekgwa ya go fapana, ya go tlaleletša gape ya go thulana yeo ditšo tša batho di abelago batho tlhago ya bobedi, seo se ra gore, mekgwa le ditiro tšeo re ithutilego tšeo re di dirago le go tsenelelana ka fase ga mekgwa ya nakwana ya gonabjale ya sebjalebjale. Gape protšeke ye e šogana le potšišo ya maitshwaro a dipolotiki ya gore re ka tlwaetšana bjang mo lefaseng leo le agilwego ke batho bao ba kopanego ba go fapana.
Modirišani wa maloba wa Kulturwissenschaftliches Institut (Esssen) gomme gonabjele ke modirišani wa dinyakišišo wa École des Hautes Études en Sciences Sociales (Paris), Profesa Wolff ke monyakišiši yo a lekanyeditšwego go B ke NRF le moithuti wa maloba wa Alexander von Humboldt Stiftung.

Professor Ernst Wolff
Individual winner | Individuele wenner | Mofenyi yo mote
Mses Joynt and Cloete are lecturers in the Department of Accounting in the Faculty of Economic and Management Sciences. In their quest to become specialists in first-year accounting education, they have implemented a range of innovative, evidence-based teaching practices, using ClickUP as a mechanism to incorporate hybrid teaching and learning.
Driven by their passion for world-class education and inspiring the next generation to be responsible global citizens and their aspiration to become thought-leaders in accounting education, they have succeeded in aligning their own teaching philosophy with the UP framework for teaching and learning through the hybrid teaching model.
The implementation of hybrid teaching methods resulted in more learning opportunities for students and over the past three years the online participation rate of students in the modules Financial Accounting 111, 121 and 122 has increased to such an extent that the module was used as a case study at the Southern African Association for Institutional Research. Mses Joynt and Cloete are also members of the South African Comprehensive Assessment Institute task team, with a focus on developing learning opportunities for school learners using hybrid methods. The assessment model applied during the 2015 and 2016 academic years, paved the way for a summative assessment that was conducted as a fully on-line examination during the off-campus period in 2016 — the first assessment of its kind in this Faculty.
During 2016, an online glossary containing the translations of terms and definitions of more than 350 commonly used accounting concepts was made available in isiZulu, isiXhosa, Afrikaans and isiNdebele. This initiative demonstrated Mses Joynt and Cloete commitment to inclusivity and respect for diversity. These initiatives resulted in a significant improvement of pass rates and retention rates of students enrolled in Financial Accounting 111, 121 and 122, measured over a three year period. These two lecturers are co-authors of three accounting textbooks and are actively pursuing their terminal qualifications in the field, while providing supervision for MCom students. Their journey on the road to teaching excellence is far from over and they are excited about the future developments of higher education in South Africa in which they hope to play a significant role.
Mee Joynt en Cloete is dosente in die Departement Rekeningkunde in die Fakulteit Ekonomiese en Bestuurswetenskappe. In hulle strewe daarna om spesialiste in die onderrig van eerstejaar rekeningkunde te word, het hulle ʼn wye reeks innoverende, bewysgebaseerde onderrigpraktyke geïmplementeer deur van ClickUP gebruik te maak as ʼn meganisme om gemengde onderrig en leer deel van die kursus te maak.
Hulle passie vir wêreldklasonderrig en om die volgende geslag te inspireer om verantwoordelike wêreldburgers te wees, asook hulle strewe daarna om denkleiers op die gebied van rekeningkundeonderrig te wees, het dit vir hulle moontlik gemaak om hulle eie onderrigfilosofie met die UP-raamwerk vir onderrig en leer deur middel van die gemengdeonderrigmodel te belyn.
Die implementering van gemengdeleermetodes het daartoe gelei dat studente oor die afgelope drie jaar meer leergeleenthede gehad het en dat die aanlyndeelnamekoers van studente in die Finansiële Rekeningkunde 111, 121 en 122-modules tot so ʼn mate toegeneem het, dat die module as ʼn gevallestudie gebruik is by die Suider-Afrikaanse vereniging vir Institusionele Navorsing. Mee Joynt en Cloete is ook lede van die Suid-Afrikaanse Komprehensiewe Assesseringsinstituut-taakspan, wat fokus op die ontwikkeling van leergeleenthede vir skoolleerders deur die gebruik van gemengde metodes. Die assesseringsmodel wat gedurende die 2015 en 2016 akademiese jare toegepas is, het die weg gebaan vir ʼn summatiewe assessering wat vir die eerste keer volledig aanlyn en van die kampus af was vir die 2016-tydperk — die eerste assessering van sy soort in die Fakulteit.
Gedurende 2016 is ʼn aanlynglossarium met die vertalings van terme en definisies van meer as 350 algemeen gebruikte rekeningkundekonsepte in isiZulu, isiXhosa, Afrikaans en isiNdebele bekend gestel. Hierdie inisiatief is ʼn aanduiding van die hoë premie wat mee Joynt en Cloete op inklusiwiteit en respek vir diversiteit plaas. Hierdie inisiatiewe het tot ʼn aansienlike verbetering in die slaag- en retensiesyfers van studente wat ingeskryf is vir Finansiële Rekeningkunde 111, 121 en 122 gelei, soos gemeet oor ʼn driejaarperiode. Die twee dosente is mede-outeurs van drie rekeningkundehandboeke en hulle is hard aan die werk aan hulle terminale kwalifikasies in die veld, terwyl hulle studieleiding vir MCom-studente bied.
Hulle reis op die pad van uitnemendheid in onderrig is nog lank nie verby nie, en hulle is opgewonde oor die toekomstige ontwikkeling van hoër onderrig in Suid-Afrika waarin hulle hoop om eendag ʼn belangrike rol te speel.
Bommarena Joynt le Cloete ke bafahloši ka Kgorong ya Sešupatlotlo ka Lefapheng la Disaense tša Ekonomi le Taolo. Mo maikemišetšong a bona a go ba ditsebi ka thuto ya sešupatlotlo ya ngwaga wa mathomo, ba dirišitše mohlwaela wa kaonafatšo, ditirišo tša go ruta mo go theilwego go bohlatse, ba šomiša ClickUP bjalo ka sedirišwa sa go kopanya go ruta le go ithuta mo go kopanego.
Ba hlohleleditšwe ke phišego ya bona ya thuto ya maemo a godimo le go hlohleletša moloko wo o tlago go ba badudi ba lefase ba maikarabelo le maikemišetšo go ba baetapele bao ba lemogwago ka thuto ya sešupatlotlo, ba atlegile go thekga filosofi ya bona ya go ruta le tlhako ya UP ya go ruta le go ithuta ka mmotlolo wa go ruta mo go kopanego.
Tirišo ya mekgwa ya go ruta mo go kopanego e dirile gore go be le dibaka tše ntši tša go ithuta tša baithuti gomme mo mengwageng ye meraro ya go feta tekanyo ya go kgatha tema mo onlaeneng ya baithuti ka thutwana ya Financial Accounting 111, 121 le 122 e oketšegile moo e lego gore thutwana e šomišitšwe bjalo ka tshepetšo ya dinyakišišo mo Mokgatlong wa Borwa bja Afrika wa Institušene ya Dinyakišišo. Bommarena Joynt le Cloete le bona ke maloko a sehlophatšhomo sa Institute ya Kelo ye e Feletšego ya Afrika Borwa, ka nepo ya go godiša dibaka tša go ithuta tša barutwana ba sekolo bao ba šomišago mekgwa ya kopanyo. Mmotlolo wa kelo wo o dirišitšwego mo mengwageng ya dithuto ya 2015 le 2016, e bula tsela ya kelo ya mafelelo yeo e dirilwego bjalo ka tlhahlobo ya go felela ya onlaene nakong ya ge baithuti ba se ka khamphaseng ka 2016 — kelo ya mathomo ya mohuta wa yona ka Lefapheng le.
Ka 2016, klosari ye e nago le diphetolelo le ditlhalošo tša mantšu tša go feta 350 tša dikgopolo tša sešupatlotlo tšeo di šomišwago gantši e bile gona ka isiZulu, isiXhosa, Seafrikanse le isiNdebele. Lenaneo le le bontšhitše boikgafo bja Bommarena Joynt le Cloete mo kakaretšong le tlhomphong ya phapano. Mananeo a a bile le dipoelo tše di kaonafetšego tše bohlokwa tša ditekanyo tša go tšwelela le ditekanyo tša tshwaro tša baithuti bao ba ngwadišitšwego ka go Financial Accounting 111, 121 le 122, tšeo di lekantšwego mo nakong ya mengwaga ye meraro. Bafahloši ba ba babedi ke bangwadimmogo ba dipuku tša kgakollo tše tharo tša tšhupatlotlo gomme ba swaragane le dithuto tša bona tša mafelelo ka karolong ye, mola ba lekola baithuti ba MCom. Leeto la bona mo tseleng ya go ruta ga bokgoni bo sa le kgole le go fela gomme ba thabetše diphetogo tša nako ye e tlago tša thuto ya godimo ka Afrika Borwa tšeo ba tshepago gore ba tla kgatha tema ye bohlokwa mo go tšona.

The Community Engagement Award was instituted in 2015 and is awarded annually to one individual to recognise community engagement as a long-standing and valued tradition in higher education and an extensive, high-impact practice in teaching at the University of Pretoria. The criteria for the award are aligned to those for the MacJannet Award, which is administered by the international Talloires Network. The Vice-Chancellor and Principal, Professor Cheryl de la Rey, is vice-chairperson of the Talloires Network executive committee.
Die Toekenning vir Gemeenskapsbetrokkenheid, wat jaarliks aan een persoon toegeken word, is in 2015 ingestel om erkenning te gee aan gemeenskapsbetrokkenheid as ’n ou en gewaardeerde tradisie in hoër onderwys en ’n uitgebreide, hoë-impakpraktyk in onderrig by die Universiteit van Pretoria. Die kriteria vir die toekenning is in lyn met dié vir die MacJannet-toekenning, wat deur die internasionale Talloires-netwerk geadministreer word. Die Visekanselier en Rektor, professor Cheryl de la Rey, is ondervoorsitter van die uitvoerende komitee van dié netwerk.
Sefoka sa Tlemagano ya Setšhaba se thomilwe ka 2015 gomme se tla abelwa motho o motee ngwaga ka ngwaga go leboga tlemagano ya setšhaba bjalo ka setlwaedi sa lebaka le letelele le seo se nago le mohola ka thutong ya godimo le mokgwa wa khuetšo ya godimo, ye e nabilego ka ga go ruta Yunibesithi ya Pretoria. Mabaka a sefoka a amantšhwa le a Sefoka sa Jannet, seo se sepetšwago ke Talloires Network. Motlatšamokhanseliri le Hlogo, Profesa Cheryl de la Rey wa UP, ke leloko la komitiphethiši ya Talloires Network.



Community Engagement Award
Toekenning vir Gemeenskapsbetrokkenheid
Sefoka sa Tlemagano ya Setšhaba
Mr Van Dijk is a lecturer in the Department of Civil Engineering in the Faculty of Engineering, Built Environment and Information Technology. He is a principal researcher for Water Research Commission (WRC) research projects to, amongst others, investigate and demonstrate the potential of extracting the available energy from various water resources (water supply and distribution systems, dams, rivers, canals, weirs and treatment plants) to provide sustainable energy. Mr Van Dijk graduated from UP with a degree in Civil Engineering in 1996, completed his BEng (Hons) degree in 1998, after which he joined the Department of Civil Engineering. He obtained a master’s degree in Water Resource Engineering and is currently completing his PhD. His research interests are the development of hydropower in general. He has been actively involved in finding ways to get this environmentally friendly, renewable, sustainable energy accepted as an alternative reliable electricity supply in urban and rural areas, promoting the technology as well as the leading role that UP is playing in this field.
He has successfully brought UP closer to rural communities by liaising at workshops, public participation events, council meetings and one-on-one discussions with councillors and community leaders. His most recent research projects include development of hydropower schemes for rural electrification in South Africa, one being a run-of-river scheme and the other utilizing an existing irrigation canal to generate electricity for the municipality using low-head hydropower technologies. As leader of the Water Engineering Group, Marco provides opportunities for pre- and post-graduate civil engineering students to make a valuable contribution to society by building capacity for the implementation of small-scale hydropower development for rural electrification in South Africa. He has expanded the Department’s postgraduate student intake and has provided communities with innovative technology that improves their quality of life. Mr Van Dijk supervises students in the module WBK890, a research master’s degree in Water Resources Engineering with funding by the WRC, the City of Tshwane and the Department of Science and Technology. Students are given the freedom to excel and use their specific skills (construction supervision, community engagement, design, regulatory and policy application, etc) to successfully complete their research topics. One example of this is a project where a student oversees the construction of a hydropower plant, which will supply 54 households with electricity, in the Eastern Cape, with labour sourced from communities adjacent to the construction site. In 2015 Mr Van Dijk received the Knowledge Tree Award in the category New Products and Services for Economic Development by the WRC as ongoing recognition for his contribution in the water-energy nexus.
Mnr Van Dijk is ʼn dosent in die Departement Siviele Ingenieurswese in die Fakulteit Ingenieurswese, Bou-omgewing Inligtingstegnologie. Hy is ʼn hoofnavorser vir Waternavorsingskommissie (WNK) -projekte wat, onder andere, die moontlikheid om beskikbare energie uit verskeie waterbronne (watervoorsiening- en verspreidingstelsels, damme, riviere, kanale, keerwalle en suiweringsaanlegte) te onttrek ten einde volhoubare energie te verskaf, ondersoek en te demonstreer.Mnr Van Dijk het in 1996 met ʼn graad in Siviele Ingenieurswese aan UP gegradueer, en sy BEng (Hons) in 1998 voltooi, waarna hy by die Departement Siviele Ingenieurswese aangesluit het. Hy het ʼn meestersgraad in Waterhulpbroningenieurswese en is tans besig om sy PhD te voltooi. Sy navorsingsbelangstellings is die ontwikkeling van hidroelektrisiteit in die breë. Hy was aktief betrokke om maniere te vind om hierdie omgewingsvriendelike, hernubare en volhoubare energie aanvaar te kry as ʼn alternatiewe, betroubare bron van elektrisiteit in stedelike en landelike gebiede deur die bekendstelling van hierdie tegnologieë en die rol wat UP in die gebied speel.
Hy het UP suksesvol nader aan landelike gemeenskappe gebring deur by werkswinkels, openbaredeelnameprosesse, raadsvergaderings en een-tot-een gesprekke met raadslede en gemeenskapsleiers as skakelpersoon op te tree. Sy mees onlangse navorsingprojekte sluit in die ontwikkeling van hidro-elektriese skemas vir landelike elektrifisering in Suid-Afrika, waarvan een ʼn rivierloopskema is en die ander gebruik maak van ʼn bestaande besproeiingskanaal om elektrisiteit op te wek vir die munisipaliteit deur die gebruik van laedruk hidroelektriese tegnologieë. As leier van die Wateringenieursgroep, bied mnr Van Dijk geleenthede aan voor- en nagraadse siviele ingenieurstudente om ʼn waardevolle bydrae tot die samelewing te maak deur kapasiteit te bou vir die implementering van kleinskaalse hidro-elektriese ontwikkeling vir plattelandse elektrifisering in Suid-Afrika. Hy het die Departement se inname van nagraadse studente uitgebrei en gemeenskappe van innoverende tegnologie voorsien wat die gehalte van hulle lewens verbeter het. Mnr Van Dijk is studieleier van die studente in die WBK890-module, ʼn navorsingsmeestersgraad in Waterhulpbroningenieurswese en wat deur die WNK, die Stad Tshwane en die Departement Wetenskap en Tegnologie befonds word. Studente word die vryheid gegun om uit te blink en hulle spesifieke vaardighede (konstruksietoesig, gemeenskapsbetrokkenheid, ontwerp, regulatoriese en beleidstoepassing, ens) aan te wend om hul navorsingsonderwerpe suksesvol te voltooi. Een voorbeeld van so ‘n projek is ʼn student wat toesig hou oor die bou van ʼn hidro-elektriese kragstasie wat 54 huishoudings in die Oos-Kaap van elektrisiteit sal voorsien, met arbeid wat voorsien word deur gemeenskappe wat in die omgewing van die bouterrein woon. In 2015 het mnr Van Dijk die Knowledge Tree Award in die kategorie Nuwe Produkte en Dienste vir Ekonomiese Ontwikkeling by die WNK ontvang ter erkenning van sy voortgesette bydrae tot die water-energie neksus.
Mna Van Dijk ke mofahloši ka Kgorong ya Boentšenere bja Segae ka Lefapheng la Boentšenere, Tikologo ya Kago le Theknolotši ya Tshedimošo. Ke monyakišišimogolo wa diprotšeke tša dinyakišišo tša Khomišene ya Dinyakišišo tša Meetse (WRC) go, gare ga tše dingwe, nyakišiša le go bontšha bokgoni bja go tloša enetši ye e lego gona go tšwa methopong ya go fapana ya meetse (kabo ya meetse le mekgwa ya kabo, matamo, dinoka, dikanale, megobe le tlhokomelo ya dimela) go aba enetši ye e swarelelago. Mna Van Dijk o maogetše tikrii ya Boentšenere bja Segae go tšwa UP ka 1996, gomme a phetha tikrii ya gagwe ya BEng (Hons) ka 1998, ka morago ga moo a šomela Kgoro ya Boentšenere bja Segae. O hweditše tikrii ya mastase ka Boentšenere bja Methopo ya Meetse gomme gonabjale o feleletša PhD ya gagwe Dikgahlego tša gagwe tša dinyakišišo ke tšwelotšopele ya mohlagase wa meetse ka kakaretšo. O dutše a tšea karolo ka mafololofolo go hwetša mekgwa ya go amogelega yeo e sa senyego tikologo, ya go mpshafatšega, ya enetši ya go swarelela bjalo ka ye mengwe yeo e ka abago mohlagase wa go tshepagala mo mafelong a metsesetoropo le a metsemagae, ya godiša theknolotši gammogo le tema ye kgolo ye UP e e kgathago mo karolong ye.
O batameditše UP kgauswi le ditšhaba tša magaeng ka go kgokagana mo ditlhahlong, ditiragalong tša go kgatha tema setšhabeng, dikopano tša khansele le dipoledišano tšeo batho ba kopanego le bakhanselara le baetapele ba setšhaba. Diprotšeke tša gagwe tša gonabjale di akaretša tšweletšopele ya setlamo sa mohlagase wa meetse sa go tsentšha mohlagase magaeng ka Afrika Borwa, ye nngwe e lego go setlamo sa semela seo se se nago bobolekelo bja meetse le kanale tše dingwe tša go šomiša nošetšo yeo e lego gona go hlola mohlagase wa mmasepala wo o šomišago ditheknolotši tša mohlagase wa meetse wa fase. Bjalo ka moetapele wa Sehlopha sa Boentšenere bja Meetse, Mna Van Dijk o aba dibaka tša baithuti ba dialogadigolwane le ba pele ga go aloga ba boentšenere bja segae go kgatha tema ye bohlokwa setšhabeng ka go aga bokgoni bja tirišo ya tšweletšopele ya mohlagase wa meetse wo o lekanyeditšwego wa magaeng ka Afrika Borwa. O katološitše kamogelo ya baithuti ba dialogadigolwane ka Kgorong gomme o abetše ditšhaba theknolotši ye e mpshafaditšwego yeo e kaonafatšago boleng bja bophelo. Mna Van Dijk o lekola baithuti ka thutwaneng ya WBK890, tikrii ya mastase ka Boentšenere bja Methopo ya Meetse yeo e thekgwago ka ditšhelete ke WRC, Toropokgolo ya Tshwane le Kgoro ya Saense le Theknolotši. Baithuti ba fiwa tokologo ya go bontšha bokgoni le go šomiša mabokgoni ao a itšego (tekolo ya tša kago, go tšea karolo setšhabeng, go akanyetša, tirišo ya taolo le dipholisi, bjalobjalo) go phetha direrwa tša dinyakišišo tša bona ka katlego. Mohlala wo mongwe wa protšeke yeo moithuti a laolago kago ya mohlagase wa meetse, yeo e tlo abelago malapa a 54 mohlagase, ka Kapa Bohlabela, moo go thwalwago bašomi setšhabeng go yo šoma lefelong la kago. Ka 2015 Mna Van Dijk o amogetše Sefoka sa Knowledge Tree ka legorong la Ditšweletšwa tše Difsa le Ditirelo tša Tšwelotšopele ya Ekonomi go tšwa go WRC bjalo ka temogo ye e tšwelago pele ka go kgatha tema ga gagwe mo go kopanyo ya enetši ya meetse.




2017 NRF-rated Researchers
2017 NNS-gegradeerde Navorsers
Banyakišiši ba 2017 bao ba lekaneditšwego ke Motheo wa Dinyakišišo wa Setšhaba

Professor Nkomo holds a strategic appointment as professor in the Department of Human Resource Management, Faculty of Economic and Management Sciences. Her internationally recognised research on gender and diversity in organisations has been published in numerous journals and books. She is listed in the international Who’s who in the management sciences and serves on the editorial boards of top journals in the field. In 2009, her research earned her the Academy of Management’s prestigious Gender and Diversity in Organizations Award for Scholarly Contributions.
Professor Nkomo received the Distinguished Women in Science: Social Sciences and Humanities Award from the South African Department of Science and Technology in 2010 and a lifetime special recognition award from the National Research Foundation in 2014 for capacity building among postgraduate students and young academics. Her most recent accolade has been the CEO Magazine SADC Lifetime Achievement Award for her contributions to the development and mentoring of young academics in higher education. She is a founding member and president of The Africa Academy of Management. She received an A2 rating from the NRF.

Professor Alfa is the South African Research Chair (SARChI) in Advanced Sensor Networks at the Department of Electrical, Electronic and Computer Engineering in the Faculty of Engineering, Built Environment and Information Technology.
His main area of research is the mathematical modelling of communication systems, with specific emphasis on wireless sensor networks, cognitive radio networks and the Internet of Things (IoT). His mathematical modelling strength is in queuing theory and optimisation.
In 2015 Springer published his Applied Discrete Time Queues. In the last three years he has also published more than 15 refereed journal papers and presented more than 15 refereed conference papers at international conferences. In 2014 Professor Alfa was invited to lecture at Tsinghua University, Beijing, People’s Republic of China (PRC). In the same year, he was also a visiting professor at Texas Southern University. In 2015 Professor Alfa was invited to lecture at Sichuan University of Science and Engineering, Zigong, PRC. He received a B2 rating from the NRF.

Professor Cornelius is professor and Head of the Department of Private Law, Director of the Centre for Intellectual Property Law, Co-director of the Centre for Sports and Entertainment Law and Chair of the Faculty of Law Research Committee.
The main focus of his research is sports law and the concept of fair play in sport. His research aims to identify various problem areas in sport related to corruption, commercial exploitation, player welfare and dispute resolution.
He is the author of three books, co-author of one book, author of 15 chapters in books and co-editor of six books. These include Principles of the interpretation of contracts in South Africa, The right to participate and other legal issues in sport, Introduction to sports contracts in South Africa and Introduction to sports law in South Africa. He has published more than 70 peer-reviewed articles and commentaries on sports law and the law of contract in notable South African and international law journals.
Professor Cornelius is a member of the Independent Doping Hearing Panel of the South African Institute for Drug-free Sport and a member of a task team reviewing the legislative framework of the South African Institute for Drug-free Sport. He received a B2 rating from the NRF.
Professor Evans is a part-time extraordinary professor in the Department of Taxation in the Faculty of Economic and Management Sciences (EMS). He also holds a part-time position as professor in the School of Taxation and Business Law at the University of New South Wales (UNSW), Sydney, and visiting positions at Oxford, Exeter and Monash universities.
His principal areas of research are tax administration, tax legislative analysis and tax policy/reform. These three connected strands enable him to work on the design and development of tax systems throughout the world that can operate efficiently, equitably and simply in their key task of raising revenue for the provision of appropriate services and – in the context of developing countries – can contribute to the critical tax of state and capacity building.
In the period from 2013 to 2016 Professor Evans received a major research grant from the Australian Research Council, which enabled him to lead and conduct a research project titled, ‘Assessing and addressing tax system complexity’. The project has led to numerous articles in international refereed journals and the publication of a major book on tax simplification (2015). He recently completed projects on the relationship between tax and corruption, the burden of tax compliance, and the impact of corporate tax aggressiveness on firm value. He has published separate books on capital gains taxation (2016) and Australian Taxation Law (2017) and is working on a book on comparative taxation scheduled for publication later this year. He received a B1 rating from the NRF.

Professor Fombad is based at the Institute for International and Comparative Law in Africa (ICLA) in the Faculty of Law. He holds a doctorate from the University of London and has taught in Cameroon, Botswana and South Africa.
He specialises in comparative African constitutional law, comparative law, legal pluralism and media law. He is a member of the editorial boards of several national and international journals, as well as several national and international professional associations. Among others, he is a vice-president of the International Association of Constitutional Law (IACL) and co-convener of one of its research groups.
Professor Fombad has published papers and book chapters and won prizes for some of his publications. He is the organiser of the Stellenbosch Annual Seminar on Constitutionalism and in that capacity started the new series, Stellenbosch Handbooks in African Constitutional Law, which is published by Oxford University Press. He is the co-editor of African Reports for Oxford Constitutions of the Countries of the World Online. He has acted as external examiner at universities in Australia, Kenya, Ghana, Namibia and Nigeria. He was a consultant for the Max Planck Foundation for International Law and Rule of Law programmes in Sudan and South Sudan, and projects in Africa of the International Institute for Democracy and Electoral Assistance (International IDEA). He has acted as consultant to the Africa Union and the Department of Political Affairs’ programme on Constitutionalism and the Rule of Law. Professor Fombad is a member of the Academy of Science of South Africa. He received a B1 rating from the NRF.

Professor Fosgate received his BS (Animal Science) degree and his veterinary qualifications (DVM) from Cornell University in Ithaca, New York, USA. He spent two years in private veterinary practice working predominantly with dairy cattle and other production animals.
He subsequently obtained his PhD in Epidemiology from the University of California, Davis, USA, and qualified as a diplomate of the American College of Veterinary Preventive Medicine. Professor Fosgate is currently a professor in the Department of Production Animal Studies and an associate editor of the journal Preventive Veterinary Medicine He received the Bayer Researcher of the Year Award for the Faculty of Veterinary Science in 2015. He is an analytical epidemiologist with research interests that include foot-andmouth disease and other transboundary animal diseases. His expertise is the validation of diagnostic tests for the surveillance and control of infectious diseases of cattle. Professor Fosgate received a B3 rating from the NRF.


Professor Fosu is an extraordinary professor in the African Tax Institute and the Department of Economics in the Faculty of Economic and Management Sciences.
His present areas of interest include the growth, inequality and poverty nexus; institutions, growth and development; and economic implications of external debt constraints. He holds an honorary appointment as research associate of the Centre for the Study of African Economies (CSAE), University of Oxford, UK. He is a member of the International Panel on Social Progress (IPSP).
Professor Fosu is a managing editor of the Journal of African Economies (Oxford), and editor-in-chief of the Journal of African Trade (Elsevier). His further service on editorial boards, currently or recently, involves many other journals, including Journal of Development Studies, Oxford Development Studies, World Bank Economic Review and World Development. He has published widely, and is listed among the 7% ‘top authors’ globally and the top 1% in Africa. Professor Fosu received a B2 rating from the NRF.

Professor Ganswindt (PhD, University of Münster, Germany) joined UP as a postdoctoral fellow in 2006 and is an associate professor and Acting Head of the Department of Anatomy and Physiology in the Faculty of Veterinary Science.
He is a behavioural endocrinologist by training and the founder of the Endocrine Research Laboratory at UP, which specialises primarily in establishing and applying non-invasive techniques to monitor gonadal and adrenocortical function in wildlife. His research focuses on regulative endocrine mechanisms in various species of mammals, reptiles, and birds, and their link to, especially, male reproductive strategies and factors determining fertility and reproductive success. In addition, he attempts to identify intrinsic and extrinsic factors that influence the social and reproductive behaviour of animals and determine their potential as physiological stressor.
He has successfully supervised/co-supervised two MMedVet, eight MSc, and three PhD students, and has published 55 scientific papers and three book chapters. He is an associated editor of the Journal of African Zoology and was vice-chair of the International Society for Wildlife Endocrinology between 2012 and 2015. He received a B2 rating from the NRF.

Professor Heyns is professor of Human Rights Law in the Faculty of Law and Director of the Institute for International and Comparative Law in Africa. His field of study is human rights, with a focus on the United Nations and the African human rights systems and in particular the right to life.
Professor Heyns also teaches human rights law at Oxford University and the Washington College of Law of the American University in Washington DC. He was a visiting professor at the University of Geneva in 2016.
He is a member of the UN Human Rights Committee. He served as the United Nations Special Rapporteur on Summary, Arbitrary and Extrajudicial Executions from 2010 to 2016 and as the Chairperson of the UN Independent Investigation on Burundi in 2016. He received a B1 rating from the NRF.
Professor Heyns is professor and Director of the Centre for Asset Integrity Management (C-AIM) in the Department of Mechanical and Aeronautical Engineering.
C-AIM focuses on the structural integrity of critical physical assets. The activities of C-AIM encompass most of the asset life cycle, with emphasis on design verification and validation, sensing and data acquisitioning, condition monitoring, diagnostics, prognostics and the use of the aforementioned to improve maintenance management decisions. C-AIM is actively supported by industry through rolling five-year collaboration programmes funded by industry partners Eskom, Exxaro, Weir Minerals and Rand Water. Professor Heyns’s personal research focuses on machine and structural health monitoring using vibration measurement and analysis, and the use of machine learning and statistical analysis techniques. Current work includes online structural integrity monitoring in turbomachinery and optical measurement techniques for integrity assessment.
Professor Heyns is a registered professional engineer in South Africa, as well as a fellow of the South African Academy of Engineering, an honorary Fellow of the South African Institution of Mechanical Engineers, a Fellow and past president of the Southern African Acoustics Institute, a Fellow of the International Society of Engineering Asset Management and a Fellow of the Royal Aeronautical Society. He received a B3 rating from the NRF.

Professor Horak is an emeritus professor in the Department of Veterinary Tropical Diseases in the Faculty of Veterinary Science.
His field of study is the taxonomy, distribution, host–parasite relationships and seasonal abundance of ticks, and the role ticks play in the transmission of tick-borne diseases to animals and humans.
In 2017, at the age of 82, his NRF rating was upgraded from B3 to B2. In June 2016 the Suid-Afrikaanse Akademie vir Wetenskap en Kuns (the South African Academy of Science and Arts) awarded him the MT Steyn medal and prize in recognition of his lifelong contribution to the natural sciences. He published his 300th peer-reviewed article in 2015.

Professor Kistner is professor in the Department of Philosophy in the Faculty of Humanities. Her research is primarily in the fields of political philosophy and psychoanalytic theory.
In 2016 Prof Kistner, in collaboration with two colleagues from the Netherlands, published a translation with accompanying articles on the first edition of Freud’s Three Essays on the Theory of Sexuality (1905). The translation shows important tracks laid early on, but pursued only much later, in re-thinking the notions of ‘perversion’ and ‘pathology’. In the other track of her research, that of political philosophy, Professor Kistner has expanded her earlier focus on the concept of the political at its limits, to investigate the geopolitical underpinnings of law and constitutionalism. Running through her work are fundamental methodological questions related to philosophical critique. These questions also pertain to a reflexive understanding of the role of academic institutions and academics, with an acute awareness of the precarity of the academic project and the educational mandate, under conditions of ratings and rankings, and performance management based on quantitative criteria. She received a B3 rating from the NRF.

Professor Maree of the Department of Educational Psychology in the Faculty of Education has three doctorates and is internationally recognised for his work in career counselling. He received the Stals Prize in June 2014 for his exceptional research and contributions to education, and in September of that year he received the Psychological Society of South Africa’s Award for Excellence in Science during the 20th South African Psychology Congress. Furthermore, in October 2014 he received an honorary membership of the Golden Key International Honour Society. The University awarded him the Chancellor’s Medal for Teaching and Learning in 2010, and he has been successfully nominated as an Exceptional Academic Achiever on four consecutive occasions (2003–2016). He has a B1 rating from the NRF.
Since 2008, Professor Maree has authored or coauthored more than 100 peer reviewed articles and more than 70 books or book chapters on career counselling and related topics. In the same period, he read keynote papers at more than 40 international and national conferences, including one at the International Congress of Applied Psychology in Paris, France, in July 2014, at which he also received a fellowship of the International Association of Analytical Psychology. He has been invited to present numerous workshops at conferences across the world on integrating qualitative and quantitative approaches in career counselling, and the art and science of writing scholarly articles. Over the past five years, he has spent time as a visiting professor at various universities where he has presented workshops on, among other things, contemporary developments in career counselling, article writing, and research methodology.

Dr McCluskey is an extraordinary professor in the African Tax Institute at the University of Pretoria. His main professional and academic interests are in the fields of real estate valuation, property tax systems, computer-assisted mass appraisal modelling and geographic information systems.
Dr McCluskey joined the Valuation and Lands Agency (Northern Ireland) in 1980, then the University of Ulster in 1985 as a lecturer in valuations, where he remained until 2014. He served as Professor of Property Studies at Lincoln University, Christchurch, New Zealand from 2001 to 2002. He was appointed visiting professor to the University of Lodz in Poland and the University of Technology in Malaysia. He is a technical adviser on property tax issues with the International Monetary Fund, the World Bank and the Food and Agriculture Organisation of the United Nations. He has been involved in a number of expert missions advising on ad valorem tax issues to Albania, Bermuda, Botswana, China, The Gambia, Georgia, Indonesia, Jamaica, Kazakhstan, Kenya, Kosovo, Lesotho, Northern Ireland, Pakistan, the Philippines, Poland, Mauritius, the Republic of Ireland, Slovenia, South Africa, Tanzania and Uganda. Dr McCluskey is a Fellow of the Royal Institution of Chartered Surveyors and has a B1 rating from the NRF.

Professor Michel is a professor in the Department of Veterinary Tropical Diseases in the Faculty of Veterinary Science.
Her research focuses on bovine tuberculosis, a disease that affects both domestic and wild animals and is a threat to livestock production, wildlife conservation and human health. Although the disease occurs widely, South Africa and the entire African region face many unique challenges as a result of its biodiversity and multi-facetted interfaces where contact between humans, wild and domestic animals provide ample opportunities for the transmission of disease.
Professor Michel and her team of postgraduate students have studied and addressed a range of challenges posed by bovine tuberculosis by elucidating the disease epidemiology, improving diagnostics of the disease and exploring new control measures. A special One Health approach to close the knowledge gap in respect of the role of bovine tuberculosis in human health is being implemented with the aim of linking medical and veterinary surveillance activities for added value in disease control and ultimately for the benefit of human livelihood.
Professor Michel has ranked among the top ten researchers of the Faculty of Veterinary Science for the past five years. She received a B2 rating from the NRF.
Professor Ngwena, LLB (Wales), LLM (Wales), LLD (Free State), Barrister-at-Law, is a professor in the Centre for Human Rights. His research is in three main fields, namely sexual and reproductive health and rights, disability rights, and the construction of race with a particular focus on the making of African identity. He is the convening editor of the African Disability Rights Yearbook and section editor of Developing World Bioethics (for law and bioethics).
He serves on the editorial boards of Medical Law International and the Journal of African Law. He is co-editor of Employment equity law (with JL Pretorius & E Klink), first published in 2001 by Butterworth Publishers and updated annually. With Rebecca Cook, he is co-editor of Health and human rights. Professor Ngwena co-edited Strengthening sexual and reproductive rights in the African region through human rights with Ebenezer Durojaye, and he has a forthcoming book – What is Africanness (to me)? Contesting nativism in race, culture and sexualities. The book draws on the work of antifoundational theorists to argue that when thinking about Africanness, Cartesian and dichotomous foundational categories and, for that matter, any identity category, do not serve us well. He is currently working on a book on the construction of women as juridical subjects in Zimbabwe during the colonial period. Professor Ngwena received a B3 rating from the NRF.

Professor Pretorius is professor emeritus in the Department of Historical and Heritage Studies. He retired in June 2014, but is still involved as supervisor of master’s and PhD students and as researcher in the department.
He is regarded as a world authority on the South African War (1899-1902) and has supervised seven doctorates on this war – the most of all supervisors anywhere. He has written or edited eight books on the war, most of which were published in both English and Afrikaans. His book, Kommandolewe tydens die Anglo-Boereoorlog, received three awards, while the English edition, Life on Commando during the Anglo-Boer War was the runner-up for The Sunday Times Alan Paton Award. His latest book on the war, A to Z of the Anglo-Boer War, was published in the USA, and has been lauded as a major contribution to our understanding of this war. He is the editor of A History of South Africa: From the Distant Past to the Present Day. Professor Pretorius received the Stals Prize for his academic contributions and is the chairperson of the History Commission of the Suid-Afrikaanse Akademie vir Wetenskap en Kuns. He received a B1 rating from the NRF.

Professor Reddy is professor and Dean in the Faculty of Humanities. His research focus is in human and social development, particularly identity marker issues (genders, sexualities, HIV, AIDS, social justice and diversity) as well as humanities questions that address policy dimensions.
He taught at the University of KwaZulu-Natal and worked as a researcher at the Human Sciences Research Council where he later headed the Human and Social Development research programme as Executive Director. Over and above articles in leading journals representing his research focus, his book-length publications are From Social Silence to Social Science: Gender, Same-Sex Sexuality and HIV/AIDS in South Africa (2009, lead co-editor), The Country We Want to Live In: Hate Crimes and Homophobia in the Lives of Black Lesbian South Africans (2010, co-author), Women as Champions of Change: A Civil Society Programme of Action for Change for the African Women’s Decade (2014, co-author), Care in Context: Transnational Gender Perspectives (2014, lead co-editor), Boldly Queer: African Perspectives on Same-Sex Sexuality and Gender Diversity (2015, co-editor) and The Socioeconomics of Livestock Keeping in Two South African Communities – A Black Man’s Bank (2016, lead coauthor). He received a B3 rating from the NRF.


Professor Theron, DEd (Guidance and Counselling), is registered with the Health Professions Council of South Africa (HPCSA) as an educational psychologist. She holds a professorship in the Department of Educational Psychology, Faculty of Education, and an extraordinary professorship in Optentia Research Entity, North-West University.
Her research explores the reasons why South African youth adjust well to chronic adversity and how sociocultural contexts shape processes of resilience.
In 2013, she received a research medal from the Education Association of South Africa for her significant contribution to understanding and promoting resilience among South African youth. Dr Michael Ungar (Resilience Research Centre, Canada) and Professor Theron were the principal co-investigators of the five-country Pathways to Resilience Study (2009–2015). The Pathways study is being followed up with a five-year resilience study, funded by the Canadian Institutes of Health Research (CIHR) (2017–2021).
Professor Theron is a principal academic/researcher and co-applicant in this study, together with Drs Michael Ungar, Robin Cox (ResilienceByDesign Research Lab, Royal Roads University, Canada) and Allyson Quinlan (Senior Research Fellow, the Resilience Alliance). She is the lead editor of Youth Resilience and Culture: Complexities and Commonalities (published by Springer, 2015) and an associate editor of the journal, Child Abuse & Neglect and School Psychology International. She received a B3 rating from the NRF.

Joe Amadi-Echendu is a professor of Engineering and Technology Management. He holds baccalaureus and master’s degrees in Electrical and Electronic Engineering from the University of Wyoming, USA, and a DPhil in Control Engineering from the University of Sussex, UK.
Professor Amadi-Echendu’s teaching and research activities focus on engineering asset management and technology commercialisation. He has published more than 150 articles in journals and accredited international conference proceedings. His involvement in community development, as well as his professional and scholarly activities, has been recognised through various local, national and international awards for best paper, distinguished service, excellence, and leadership.
Professor Amadi-Echendu has more than 12 years’ industry work experience, primarily in implementing operational readiness in the petrochemical and mining sectors. He is a registered professional engineer in the United Kingdom and South Africa. Professor Amadi-Echendu is editor in chief of Springer’s Engineering Asset Management Review Series and Founding Fellow, Director and chairperson of the board of the International Society of Engineering Asset Management (ISEAM). He is a member of the board of directors of the International Association for the Management of Technology (IAMOT). He serves as member of technical panels for long standing international conferences such as Condition Monitoring and Diagnostic Engineering Management (COMADEM), IAMOT, the Portland International Center for Management of Engineering and Technology (PICMET), and the World Congress on Engineering Asset Management (WCEAM). Professor Amadi-Echendu is an ‘Experienced Researcher’ for the European Union grant funded H2020-MSCA-RISE Sustain Owner Project 645733. He received a C2 rating from the NRF.

Professor Arashi is an extraordinary professor in the Department of Statistics in the Faculty of Natural and Agricultural Sciences. He is also an associate professor of Statistics at Shahrood University of Technology in Iran.
Prof Arashi works in areas of statistical inference and applied statistics. His focus subjects include Multivariate Analysis, Shrinkage Estimation, Penalized Linear Models, Highdimensional Analysis and Big Data.
In 2016 Professor Arashi received the Professor Behboodian and Professor Bozorgnia Awards from the Iranian Statistical Institute. On numerous occasions he has been awarded for research excellence by Shahrood University of Technology, most recently in 2014 and 2015. The same institution also awarded him for teaching excellence in 2012 and 2013.
Prof Arashi has published more than 80 papers in accredited journals and co-authored Statistical Inference for Models with Multivariate t-Distributed Errors, published by John Wiley in 2014. He received a C2 rating from the NRF.
Professor Bezuidenhout is an associate professor in the Department of Social Work and Criminology. He teaches psychocriminology, criminal justice and contemporary criminology at undergraduate and postgraduate levels.
His research foci include psychocriminology, policing and youth misbehaviour. He recently completed a cross-cultural study with an American colleague. The focus of the study is on the legal and policing dilemmas of human trafficking. He has published numerous scientific articles in peer-reviewed journals and book chapters. Professor Bezuidenhout has also acted as editor in chief for various scholarly books. He is the programme coordinator of the Criminology Honours Degree programme and has supervised several postgraduate studies (MA and DPhil). He has participated in national and international conferences and has been actively involved in various community projects focusing on crime prevention. He assisted the South African Government in the development of different crime prevention initiatives.
Professor Bezuidenhout undertakes court work as an expert witness. He is currently the president of the Criminological and Victimological Society of South Africa (CRIMSA). He holds the following degrees: BA (Criminology), BA Honours (Criminology), MA (Criminology), DPhil (Criminology) and an MSc in Criminology and Criminal Justice from the University of Oxford. He received a C3 rating from the NRF.

Professor Bloomer is a professor in and the Head of the Department of Genetics in the Faculty of Natural and Agricultural Sciences. She is associated with the Mammal Research Institute at the University of Pretoria and with the DST/NRF Centre of Excellence in Birds as Keys to Biodiversity Conservation at the Percy FitzPatrick Institute at the University of Cape Town.
Her research focuses on vertebrate phylogeography through which a better understanding of animal diversity and distributions is gained. She is passionate about the conservation of Southern Africa’s rich biodiversity, within the context of the maintenance of functioning ecosystems and long-term sustainable use of natural resources.
She serves on several advisory committees within and outside the University of Pretoria. She is an author of 62 papers, two conference proceedings and 16 technical reports. Since joining the University in 1999 she has been a supervisor/co-supervisor of 26 MSc and 20 PhD students and hosted ten postdoctoral researchers. She received a C2 rating from the NRF.

Dr Breed is a senior lecturer in the Department of Architecture in the Faculty of Engineering, Built Environment and Information Technology (EBIT).
Her research is concerned with open space design and how it relates to natural and cultural contextual issues and identity. Her research demonstrates the importance of the landscape design as part of green infrastructure, urban ecology and social-ecological resilience. Dr Breed’s PhD research focused on group-based assigned values and relates these to ecosystem services and ethical values. Through qualitative research methods, she explores existing biases in the urban built environment and how this differs from existing literature. The findings of her research are relevant to national health issues concerning people and the environment and indicate the importance of quality public open space criteria in the developing world.
Dr Breed is the current president of the Institute for Landscape Architecture in South Africa (ILASA). She has read papers at international conferences and published in international accredited journals such as the Journal of Urban Planning and Development. She received a UP Vice-Chancellor’s grant that enabled the completion of her PhD research in two years. Dr Breed is one of only two landscape architects in South Africa with a NRF rating and received a C3 rating.


Professor Brown is professor and Head of the English Department. She began her research career by working in the field of early modern Romance, but gradually became more interested in how Romance tropes continue to manifest themselves in contemporary fantasy literature for both adult and child readers.
A major focus of her work is on the developmental role of childhood reading, particularly in postcolonial societies in which indigenous fantasy conventions may exist in an uneasy symbiosis with ones imported from Western Europe and the USA. She is Vice President (International) of the Tales after Tolkien Society, which promotes the academic study of medievalism in popular culture. Professor Brown also heads a faculty research theme on children and stories at the University of Pretoria. She has successfully supervised more than 20 postgraduate research students.
Her current research involves considering how South African fantasy for young readers produced since 1994 reveals telling lacunae and fissures that serve to undermine the national narrative of reconciliation. She collaborates with Professor Helen Yitah of the University of Ghana to promote the academic study of children’s literature in Africa. She received a C3 rating from the NRF.

Professor Chirwa is professor and since 2014 the holder of the Sedibeng Water Chair in Water Utilisation Engineering in the Department of Chemical Engineering. During his tenure as professor at the University of Pretoria, he has delivered ten PhD and 25 MSc/MEng graduates.
Prof Chirwa has established a multidisciplinary research group focusing on biological remediation of toxic organic and inorganic pollutants in water, nutrient removal processes, remediation of radioactive elements from the environment, and rural water resources development. His most recent work on the characterisation of biosurfactants produced by polycyclic aromatic hydrocarbons (PAH)-degrading bacteria produced 12 articles in high-impact journals in 2016. He recently completed projects on the removal of nitrogen from wastewater using anaerobic ammonium oxidizing (anammox) bacteria and photocatalytic degradation of toxic aromatic compounds using copper-doped titanium dioxide as the photocatalyst. The crowning achievement of Professor Chirwa’s work was the derivation of the diffusion-reaction model for the removal of Cr(VI) and toxic heavy metals in biofilms and groundwater aquifer media. Through his research, he has attracted substantial external funding amounting to R32 million by 2016, published 141 research articles in peer-reviewed research journals and book chapters, and presented his work as a keynote speaker at several international conferences. By the end of 2016, his work had been cited 687 times in peer-reviewed ISI-accredited journals. Professor Chirwa endeavours to build capacity for advanced research in water with the aim of transforming the impeding water crisis in Southern Africa into a business and industrial opportunity by developing technologies and business activity to remedy the impacts of water shortage and to create ‘new water’. He received a C2 rating from the NRF.

Professor Chirwa is Director of the SAFCOL Forestry Research Chair in the Faculty of Natural and Agricultural Sciences. He is a forest scientist and specialises in socio-ecological systems in forests; agroforestry; and social or community forestry.
His research group works on a range of projects in remote regions of South Africa, in the miombo forest ecosystem that covers most of the dry forest and woodlands of southern Africa, and in the Sudanian and Sahelian regions of West Africa. The research aims to understand the link between people and natural resource governance, the use of resources, and interventions that will successfully promote sustainable forest management. This includes a focus on the drivers of change in land cover and the modelling of carbon dynamics in natural woodland systems and forest plantations. Professor Chirwa received a research fellowship from the African Forest Forum in 2014 and two doctoral research funding awards in 2015 and 2016 for postgraduate students in his research group. He has published widely and recently acted as guest editor for three special issues of forestry journals, namely the International Forestry Review, Agroforestry Systems and Southern Forest: A Journal of Forest Science. He received a C2 rating from the NRF.
Professor Chitiga-Mabugu joined the University of Pretoria as Director and Head of the School of Public Management and Administration in September 2014. She was the Executive Director of Economic Performance and Development at the Human Sciences Research Council prior to rejoining the University. She had previously been professor in the Department of Economics at the University of Pretoria, where she taught microeconomics, public sector economics, development economics, economic modelling and mathematics for economists.
Prof Chitiga-Mabugu obtained her PhD in Economics at the University of Gothenburg in Sweden with the research focus on the economy-wide impacts of public policies on income distribution. Her research interests are the tracing and analysis of the effects of government policies on households and the broader economy. She has applied various modelling approaches to answering questions on, among others, environmental, trade and socio-economic policies and has conducted research on a wide variety of development issues.
Professor Chitiga-Mabugu has published both locally and internationally, and has also co-authored more than 20 client research reports. In addition, she has supervised more than a dozen PhD and master’s students. She received a C1 rating from the NRF.

Professor Cukrowski is an emeritus professor in the Department of Chemistry in the Faculty of Natural and Agricultural Sciences.
Professor Cukrowski and his research team focus on theoretical and computational chemistry. This includes the development of new theories and methodologies aimed at a better understanding of classical as well as unusual chemical bonding and interactions (intra- and intermolecular), as well as explaining the relative stability of molecular systems. They developed a protocol for explaining and predicting the most likely reaction pathways. All their approaches are based on the fundamental properties of atoms, functional groups (molecular fragments) and molecules derived from the electron density distribution throughout a molecule (molecular system). Their research has been and continues to be sponsored by the NRF.
Professor Cukrowski delivered a plenary lecture at the Modelling and Design of Molecular Materials conference in Trzebnica, Poland, in June 2016. He received a C2 rating from the NRF.

Professor De Villiers is professor and Head of the Department of Informatics in the School of Information Technology in the Faculty of Engineering, Built Environment and Information Technology.
Her main research area is the teaching of Information Systems (IS), particularly the use of different theories in pure IS research that can be applied in research on the teaching of IS. This has resulted in a number of publications and conference papers. Her second area of research is information and communications technology (ICT) for development. Since 2008 Professor De Villiers has participated in workshops of the Association for Information Systems (AIS) Special Interest Group for Global Development, of which she was the co-chair for Africa.
A highlight in her career is the second successful application in 2013 for international accreditation for the BCom (Informatics) programme by the Accreditation Board for Engineering and Technology (ABET) in the USA. UP’s IS programme is the only one in Africa that is internationally accredited by ABET.
Professor De Villiers serves on several editorial boards, including two of the top IS journals, namely IT for Development and Information Systems Research. She is actively involved in AIS and in the South African Institute for Computer Scientists and Information Technologists (SAICSIT). She has been an NRF rated researcher since 2000, and received her third re-rating, C2, in 2016.


Dr Du Rand is a senior lecturer in the Department of Consumer Science in the Faculty of Natural and Agricultural Sciences, and Head of the Food and Nutrition Division of the Department of Consumer Science.
She has earned academic recognition at both national and international level for her research and expertise in the field of food- and hospitality-related consumer behaviour. Her special area of interest is food tourism and the use of local foods in culinary mapping. Dr Du Rand’s research experience comprises food-related consumer behaviour in the culinary field and consumer-related food product development. Her current extensive involvement with postgraduate students focuses on topics ranging from consumer food practices and behaviour, culinary practices, and innovative culinary product development to food tourism. She is involved in various research projects, such as the Centre of Excellence project on consumer aspects of food safety of fresh produce, food waste management, and a project on the food security of students at the University of Pretoria. In 2009 she received the Dux Docens award for best lecturer at the University of Pretoria, and in 2010 and 2015 she won best paper awards at international conferences. Dr Du Rand received a C2 rating from the NRF.

Professor Du Toit is an associate professor in the Department of Plant and Soil Sciences of the Faculty of Natural and Agricultural Sciences.
She teaches Nursery Management: Principles and Practices at third year level, Ornamental Horticulture at fourth year level and Plant Production: Horticulture at postgraduate level. Professor Du Toit’s research focuses on innovative propagation and cultivation technologies for ornamentals, cut-flowers and undomesticated medicinal and multipurpose crops for the production of food, medicine and feedstock for biofuels.
Over the past three years her research has specifically focused on reproductive biology, vegetative/micro-propagation, grafting compatibility, seed/fruit development and sustainable production of plant bioactive compounds. To date, she has supervised 31 postgraduate students and postdoctoral researchers. Professor Du Toit has published 54 peer-reviewed research articles in respected international scientific journals in the fields of horticulture, agriculture, plant sciences and agroforestry. She has contributed chapters to six books and completed 11 self-initiated third stream funded research projects. Professor Du Toit has compiled 15 comprehensive technical reports for several government departments, including Gauteng Province and the Water Research Commission. She received a C2 rating from the NRF.

Professor Engelbrecht is a professor in mathematics education, who, before retirement, was Deputy Dean of the Faculty of Natural and Agricultural Sciences and acted as Vice-Principal of the University.
He was a founder and executive director of the SA Mathematics Foundation (SAMF) that facilitates contact among mathematicians from all over the country, as well as government and industry.
His international involvement in the research field of mathematics education at tertiary level includes research papers and keynote presentations, membership of scientific committees for international conferences, and joint research projects with colleagues in many countries. He represented South Africa on the International Programme Committee for the International Conference on Mathematical Education (ICME) 2012 in Seoul and was a member of a survey team on blended learning at ICME 2016 in Hamburg.
He is a founder of the international Delta movement and received several awards, including that of the Claude Harris Leon Award Championship in Mathematics Teaching and the South African Mathematical Society Award for the Advancement of Mathematics. Professor Engelbrecht received a C1 rating from the NRF.
Professor Garbers-Craig is a professor in the Department of Materials Science and Metallurgical Engineering, and holds the Anglo American Chair in Pyrometallurgy.
Her research covers the fields of pyrometallurgy, refractory materials and iron ore agglomeration, where she focuses on industry-related questions and process developments. Over the past six years her research has concentrated on platinum group metal (PGM) processing, refractories used in PGM processing, as well as the agglomeration and pelletising of iron ore. The formation of Cr(VI) in high temperature processes and refractory materials, and the subsequent stabilisation thereof, have been ongoing themes in her research.
She is a member of the editorial board of the Journal of Mineral Processing and Extractive Metallurgy and the NRF Engineering Specialist Committee for rating applications. She is a Fellow of the South African Academy of Engineering, the Southern African Institute of Mining and Metallurgy (SAIMM) and a member of the Association for Iron and Steel Technology (AIST) and the American Ceramic Society (ACerS). Professor Garbers-Craig was the SAIMM President for 2008-9. She received a C1 rating from the NRF.

Dr Gouse is a researcher in the Department of Agricultural Economics, Extension and Rural Development in the Faculty of Natural and Agricultural Sciences and a research associate at the Bureau for Food and Agricultural Policy (BFAP).
In collaboration with and supported by various national and international research institutions and development agencies, Dr Gouse has spent most of his research life studying the actual and potential socio-economic and farm-level impacts of genetically modified (GM) crops, with special focus on resource-poor farmers. Dr Gouse has been invited to various international conferences and seminars to present his research findings and experience. He has contributed to a number of edited and peer-reviewed books on agricultural biotechnology, its impacts and applications and has authored and co-authored various journal articles. Dr Gouse completed his PhD in the Department of Agricultural Economics, Extension and Rural Development in 2012, before participating in a Bill and Melinda Gates Foundation postdoctoral fellowship in the same department and subsequently joining BFAP. BFAP is an independent research unit collaborating with various universities, the private sector and government, and conducts independent research-based policy and market analyses with the purpose of informing decision-making in the agro-food, fibre and beverage complex in South and Southern Africa. He received a C2 rating from the NRF.

Professor Harding is a professor in the Department of Mathematics and Applied Mathematics.
Her field of research is tertiary mathematics education, focusing specifically on the challenges associated with the teaching and learning of mathematics at undergraduate level. Her research contributes to understanding and alleviating the current education crisis in the field of science in South Africa, especially in addressing the under-preparedness of school leavers for the transition to university mathematics, as well as harnessing technology for teaching and learning. Research in undergraduate mathematics education is a relatively young field worldwide. Professor Harding has been instrumental in establishing this research field at the University of Pretoria. She also has a passion for the ally and internationally. She received a C2 rating from the NRF.


Professor Herman is an associate professor in the Department of Education Management and Policy Studies in the Faculty of Education.
Her main research focus is higher education policy with specific focus on doctoral education. Professor Herman is an internationally recognised researcher with more than 20 peer-reviewed publications. She has worked with a number of international and national agencies providing evidence-based advice for policy-making, mainly on developing research capacity in South Africa and Africa. She was re-awarded a C2 rating by the NRF.

Professor Howie is the Director of the Centre for Evaluation and Assessment in Education in the Faculty of Education. The Centre has in the past undertaken research, evaluations and training for the National Department of Education, the Michael and Susan Dell Foundation, UNICEF, the World Bank, the Shuttleworth Foundation and the Nuffield Foundation amongst others. In addition, it has been the national coordinating research centre for the Progress in International Reading Literacy Study (PIRLS) since 2005.
Professor Howie’s scientific field of interest and areas of work include monitoring, evaluation, assessment and international comparative research focussing on learner achievement. In 2015 she delivered the keynote address at the sixth International Research Conference of the International Association for the Evaluation of Educational Achievements (IEA) and in 2016 at the 42nd Conference of the International Assessment and Evaluation Association (IAEA). She has published widely and serves on the editorial boards of three international journals. She works/has worked as a consultant for Education and Testing Services, Princeton, USA, the Organisation for Economic and Cooperation Development (OECD), UNESCO and the World Bank, amongst others. She is the co-coordinator of the Student Assessment Network for the European Educational Research Association. Professor Howie has a high degree of involvement with the design and development of international assessment studies. She serves as a member of two OECD expert groups (Programme for International Student Assessment, PISA 2018, and TALIS 2018), as well as the IEA PIRLS 2016 Questionnaire Development Group. She was a member of the Learning Metrics Task Force for post-primary from the UNESCO Institute for Statistics (UIS)/Center for Universal Education (CUE) at the Brookings Institution in preparation of the global monitoring report, Education for All 2015
Nationally she is the deputy-chair of the board of SAQA, and member of the Umalusi Assessment and Standards Committee, the USAf Admissions Committee and the Academy of Science for South Africa.

Dr Human is a statistician and quantitative analyst at Nedbank Ltd who works part-time at the University of Pretoria as senior and extraordinary lecturer in the Department of Statistics in the Faculty of Natural and Agricultural Sciences. Dr Human completed all his degrees up to PhD in Mathematical Statistics cum laude at the University of Pretoria.
His research focuses on parametric and nonparametric statistical process control techniques and distribution theory. Over the last few years he has authored and co-authored 20 articles that were published in various international peer-reviewed journals. He has published four peer-reviewed conference proceedings and five technical reports. He has presented his research on more than 45 occasions at local and international conferences as well as departmental seminars. Among his research outputs are two invited contributions to the Encyclopaedia of Statistics in Quality and Reliability and methods and Methods and Applications of Statistics: Engineering, Quality Control and Physical Sciences. He was an invited speaker at the Joint Meeting of y-BIS and jPSE in Lisbon, Portugal, in 2012. Dr Human has acted as reviewer for approximately 15 local and international journals. He received a C3 rating from the NRF.
Dr Ismail is a joint appointee in the Department of Medical Microbiology in the Faculty of Health Sciences He is Head of the Centre for Tuberculosis at the National Institute for Communicable Diseases (NICD). He has been active in TB services and research in South Africa for many years. His initial focus was on the microbiology of TB with special emphasis on molecular biology – diagnostics and genotyping. This has now been expanded to include epidemiological surveillance as a core function of the Centre for Tuberculosis.
Dr Ismail is a councillor of the Colleges of Medicine Pathology Board. He is a member of numerous associations such as the American Society of Microbiologists, the International Union Against Tuberculosis and Lung Disease, the Critical Path to TB Drug Regimens (CPTR Initiative).
He acts as advisor to many committees and boards, including the National Health Laboratory Service (NHLS) TB Expert Committee and the Microbiology Advisory Committee. He serves on the Antimicrobial Resistance working group of the NDoH and is an expert/technical advisor to the World Health Organisation. He is also a member of Global Laboratory Initiative for Africa. Dr Ismail received a C2 rating from the NRF.

Professor Jordaan is a professor in the Department of Economics, Faculty of Economic and Management Sciences.
His main research interests are international trade and export promotion. His research includes the impact of trade facilitation and trade barriers as constraining factors for intra-African trade. His most significant research contribution of late is a research study on the Continental Free Trade Area (CFTA) and Technical Barriers to Trade (TBT), to be used in the current round of negotiations on the envisaged CFTA in Africa. This research was done in co-operation with the Physikalisch-Technische Bundesanstalt, Braunschweig und Berlin (Nationales Metrologieinstitut) which is involved in setting trade standards for the European Union. Professor Jordaan also developed an international trade gravity model for South Africa and 147 trading partners in 33 economic sectors. This model is used for trade policy analysis by the Department of Trade and Industry. He completed a post-doctoral fellowship at the Free University in Amsterdam and has lectured at universities in the USA, Germany, Australia and Chile. He is a member of the United Nations Conference on Trade and Development (UNCTAD) with 134 associated university members, as well as the Comparative Economic Development Studies network of universities for emerging market economies including Argentina, Brazil, China, India, Mauritius and Germany. This network, amongst other, focuses on exposing graduate students to research collaboration and research exchange. He received a C3 rating from the NRF.

Professor Joubert is an associate professor heading the Optimisation Group in the Department of Industrial and Systems Engineering and is also affiliated with the Centre for Transport Development in the Faculty of Engineering, Built Environment and Information Technology (EBIT).
His research focuses on the development of models that support government and industry decision-making under uncertainty, especially related to inequality of access and spending on transport infrastructure. Of particular interest to him are multi-agent simulation models in the freight transport domain.
His research has appeared in a number of the leading international transport journals, including Transportation, Journal of Transport Geography, Transportation Research and Cities.
Professor Joubert is a former fellow of the Mobility Cultures in Mega-cities programme sponsored by the Institute for Mobility Research (ifmo), a research facility of the BMW Group. He is a director of the international Institute for City Logistics and is registered as a professional engineer with the Engineering Council of South Africa (ECSA). In 2007 he was acknowledged by the Southern African Institute for Industrial and Systems Engineering (SAIIE), which awarded him the President’s Award. He received a C2 rating from the NRF.




Professor Krüger is an associate professor in the Deparment of Zoology and Entomology in the Faculty of Natural and Agricultural Sciences and an associate of the UP Institute for Food, Nutrition and Well-being (IFNuW).
The focus of Professor Krüger’s research is applied entomology, specifically crop protection. Her research involves the interactions between plants, herbivorous insects and their natural enemies, and plant disease-insect vector relationships. The emphasis in both is on insect pests of crops to improve sustainable food production through the development of safe and environmentally friendly pest management strategies. Her current research involves the development of biological and integrated control of insect vectors of plant diseases, as well as studies on the transmission biology of plant diseases by insect vectors.
She serves as a member of several national and international bodies including the African Regional Postgraduate Programme in Insect Science (ARPPIS) and has been an invited speaker at national and international meetings. She received a C2 rating from the NRF.
Dr Legesse is an extraordinary lecturer at the Forestry and Agricultural Biotechnology Institute (FABI) in the Faculty of Natural and Agricultural Sciences.
He is currently working for the World Vegetable Center (West and Central Africa) based in Bamako, Mali. His research interest is the population genetics, ecology, reproduction, genomics, diagnosis and protection of plant pathogenic fungi. Dr Legesse received a C3 rating from the NRF.
Professor Le Roux is an emeritus professor who specialises in the Old Testament and has devoted his life to a historical understanding of these books of the Bible. He obtained his doctoral degrees in Church History and the Old Testament at the Universty of South Africa (UNISA) and started his academic career as a lecturer at UNISA in 1971. He joined the Faculty of Theology and the Department of Old Testament Studies at the University of Pretoria in 1987. Since 2009, when he became an emiritus professor, he has been involved in projects devoted to the Old Testament. He is general editor of the Faculty’s website (teo.co.za) and lectures to postgraduate students on an ad hoc basis.
Since 2000 Professor Le Roux has been the organiser of an annual scholarly seminar, Pro Pent, which was initiated as a co-project with Ludwig-Maximilians-Universität (LMU), München, Germany, and has become a hub where international scholars meet to focus on the first five books of the Hebrew Bible (Pentateuch). Pro Pent attempts to uncover the message of the Pentateuch by means of the latest and most refined Pentateuch theories. Pro Pent is in its 17th year and has forged closer ties between UP and the LMU. Professor Le Roux received a C2 rating from the NRF
Professor Louwagie is adjunct professor in Public Health Medicine (PHM) at the School of Health Systems and Public Health at the University of Pretoria (UP). She obtained her medical degree (cum laude) in Leuven, Belgium, followed by a diploma in Tropical Medicine. After a period of general practice in Belgium, she gained extensive clinical and managerial experience in the South African public sector and completed a diploma in Health Care Management (cum laude). She then entered academia and obtained her MMed degree in PHM (cum laude), was awarded a fellowship by the College of PHM and completed her PhD in Epidemiology at the University of Pretoria.
Her research focuses on health systems issues related to HIV, tuberculosis and substance abuse, in particular smoking. She was principal investigator and grant holder for a major randomised controlled trial on tobacco cessation in tuberculosis patients. The use of motivational interviewing for tobacco cessation in TB patients with high HIV co-infection rates was a first in the world. She collaborates widely with national and international researchers and has been awarded several research grants. She was one of the main applicants for a prestigious UK Medical Research Council–Newton Foundation grant to research TB control in collaboration with national and international universities and has since been awarded the grant. In this study researchers will test a complex behavioural intervention, the PROLIFE model, which focuses on the smoking of tobacco, drinking of alcohol and adherence to TB treatment programmes. Prof Louwagie received a C2 rating from the NRF.

Dr Lutermann is a lecturer in the Department of Zoology and Entomology in the Faculty of Natural and Agricultural Sciences. She holds a doctorate in Biology from Hannover University in Germany and joined the University of Pretoria as a postdoctoral researcher in 2003.
As a behavioural ecologist, Dr Lutermann’s interest lies in the evolution of social and mating systems as well as parasite ecology. Her research focuses on identifying and understanding the drivers of spatiotemporal patterns in the distribution of parasites across endemic small mammals. She follows an interdisciplinary approach in her research to evaluate how climate factors, host behaviour and physiology affect the parasite burden in small mammal hosts that may sustain vectors and pathogens of medical and veterinary importance.
Dr Lutermann serves as editor for two international ISI-rated journals, PloS One and Journal of Zoology, and regularly acts as reviewer for journals such as Proceedings of the Royal Society B: Biological Sciences, Biology Letters, Functional Ecology, Behavioural Ecology, Animal Behaviour and Parasitology. She has published more than 40 peer-reviewed articles in international journals and has co-authored one book chapter. Dr Lutermann received a C2 rating from the NRF.

Professor Malherbe joined the University of Pretoria in 1981, and was Dean of Engineering from 1989 to 1999. He was Executive Director (Projects) from 2000 to 2001 and Vice-Principal from 2001 to 2003, when he was appointed Institute Professor. Since his retirement in 2005 as Emeritus Vice-Principal, he has been professor in the Department of Electrical, Electronic and Computer Engineering.
Professor Malherbe received the degrees BSc and BEng from the University of Stellenbosch in 1962. In 1974 he was awarded a PhD by the same institution, and in 1987 a DEng from the University of Pretoria. After a period in industry, he lectured at the University of Stellenbosch, and held research positions at the universities of Illinois and Stanford. In the 1990s he was consultant to and later managing director of the Laboratory for Advanced Engineering, as well as part-time director of Industrial Programmes for the Foundation for Research Development. He is a Life Fellow of IEEE, member of the Academy of Science of SA, Fellow of the SA Academy of Engineering, Fellow of the South African Institute of Electrical Engineers, Fellow of the Electromagnetics Academy of MIT and a Registered Professional Engineer with the Engineering Council of South Africa.
He received the Havenga-prize for Engineering in 1995, the IEEE Third Millennium Medal in 2000, and the Bill Venter Award Pro Libri Excellenti (co-author). He is also a recipient of the University of Pretoria Commemorative Research Medal as one of the Leading Minds 1908-2008. Professor Malherbe received a C3 rating from the NRF.




Professor Manyala is a professor of Physics and incumbent of the South African Research Chair Initiative (SARChI) in Carbon Technology and Materials at the University of Pretoria. Professor Manyala obtained his PhD from Louisiana State University working on low temperature transport and the magnetic properties of strongly correlated materials. He published two papers in this field in Nature and one in Nature Materials while at Louisiana State University.
Professor Manyala’s recent research interest is on graphene-based materials and their applications in sensing and energy storage as supercapacitors and batteries. He has published more than 50 papers on this subject. Professor Manyala is a member of the International Society of Electrochemistry, the South African Microscopy Society and the South African Institute of Physics. He received a C2 rating from the NRF.
Professor Maree is professor in the Department of Psychology. From 1987 to 1995 he was a researcher at the Human Sciences Research Council (HSRC) where he was appointed head of traffic research in 1995 and became director of the unit for test development in 1997.
In 1999 he joined the University of Pretoria as a full professor in the Department of Psychology. His duties included the lecturing of research methodology, cognitive psychology and statistics to graduate students. He coordinated the MA Research Psychology degree from 2000 to 2012. He is currently involved in several research projects, committees and workgroups within and outside the University. Professor Maree is a registered research psychologist, and a member of the Association of Psychological Science (APS). He acted as head of the Department of Philosophy from 2010 to 2011 and was head of the Department of Psychology from 2013 to 2016. He was president of the Psychological Society of South Africa (PsySSA) from 2013 to 2014. At present he is Chair of the psychometrics committee of the Psychology Board at the Health Professions Council for South Africa (HPCSA). He received a C3 rating from the NRF.
Professor Mokomane is an associate professor in the Department of Sociology. Her primary area of research is family demography, with a particular focus on the work-family interface and social policy analysis. She is particularly interested in the development and implementation of policies that address the potential conflict that parents face in meeting the demands of paid work and attending to family members in need of care. Her research is largely undertaken within the African and Global South perspective to strengthen and amplify African voices in the global work-family discourse. Professor Mokomane formed the African Research Network on Work and Family in 2015.
Through this Network she aims to bring together postgraduate students, researchers, and policy-makers to undertake and disseminate collaborative research on a range of African-specific work-family topics. Professor Mokomane has been a member of several United Nations expert groups that prepared for the 20th Anniversary of the International Year of the Family in 2014. In 2015 she was appointed for a five-year term to the International Advisory Board of the India-based Service and Research Institute on Family and Children (SERFAC) which functions as a Global Research Centre on Family and Child Policy. She received a C2 rating from the NRF.
Professor Mostert is a professor in the Department of Marketing Management in the Faculty of Economic and Management Sciences. His research focuses on services marketing, relationship marketing and relationship intention. Research on organisation–customer relationships established that organisations want to build long-term relationships with customers because it leads to higher profits, a better competitive position, and a greater chance of success. Professor Mostert’s research contributes to the current debate by considering organisation–customer relationships from the customer’s perspective. Specifically, his research found that it is possible to identify groups of customers who want to reciprocate the relationship-building efforts of organisations by displaying higher levels of relationship intention. Based on these findings, his research also considered the influence of customer relationship intention on their relationships with organisations following service failures in the service delivery process as well as following organisations’ service recovery efforts to restore customer satisfaction.
Professor Mostert’s current research focuses on a new field in relationship marketing, namely service brand avoidance. His future research will include determining the influence of organisations’ service recovery efforts following service failures on customers’ brand avoidance behaviour. He received a C3 rating from the NRF.

Professor Oosthuizen is a professor in the Department of Veterinary Tropical Diseases, Faculty of Veterinary Science. She specialises in tick-borne pathogen discovery, notably the molecular characterisation of novel tick-borne blood parasites (Theileria, Babesia, Ehrlichia and Anaplasma species) of domestic and wild animals, including those that threaten endangered and rare wildlife species, as well as the development of molecular diagnostic assays for detecting haemoparasites of veterinary importance.
Some highlights of her research include identification of novel Babesia and Theileria species as possible causes of mortality in various wildlife species, including sable, roan, rhino, cheetah and giraffe. She also has a special interest in the role of rodents as a reservoir host of infection for humans and domestic animals and the genetic diversity that exists within these rodent-borne zoonoses.
Professor Oosthuizen has served as the secretary of the Parasitological Society of Southern Africa (PARSA) for the past six years, and is currently secretary of the International Society for Tropical Veterinary Medicine (STVM). She received a C2 rating from the NRF.

Professor Rheeder is a professor in the Department of Internal Medicine, Steve Biko Academic Hospital.
His main area of research is in non-communicable diseases (diabetes and hypertension), with the focus on improvement of patient outcomes through better diagnosis, treatment and health systems improvement. The research is not only hospital-based but also involves communities as disparate as urban settlements and under-resourced rural communities. He received a C2 rating from the NRF.


Professor Sandwith is associate professor in the Department of English. She authored World of Letters: Reading Communities and Cultural Debates in Early Apartheid South Africa (2014) and Africa South: Viewpoints, 1958-1961 co-edited with MJ Daymond (2011).
Her research interests include the history of reading and cultural debates in early apartheid South Africa with a particular focus on dissident print cultures. The work retrieves an important but largely forgotten history of public discussion about culture, books and reading in South Africa. What emerges is a rich tradition of public engagement and a host of readers and critics whose lively interventions played a significant part in South Africa’s literary-cultural heritage. Her latest book reclaims this history and argues for its constitutive role in the South African literary archive. In 2016, World of Letters was awarded the UP Vice-Chancellor Book Prize and was runner up in the National Institute for the Humanities and Social Sciences (NHISS) book awards for an academic monograph. Current research by Professor Sandwith includes a book-length project which offers a reading of early twentieth-century African literature through the lens of the popular African press. Newspapers are examined in relation to the particular reading communities they constellate and read as important sites for African literary production, which often takes an unexpected form and appears in surprising spaces. She received a C2 rating from the NRF.

Professor Schoeman-Malan is a professor in the Department of Private Law at the Faculty of Law.
She is an advocate of the High Court and lectures at under- and postgraduate level on law of succession, administration of estates and law of persons. She is the co-author of the text books Law of Succession and Deceased Estates currently in their fifth and tenth editions respectively. She has published more than 40 peer reviewed research articles on the broader field of law of succession and administration of estates.
In recent research, she focuses on comparative aspects of law of succession in civil and common law jurisdictions and also on aspects of social justice and interrelated issues between the law of persons and law of succession. She annually delivers papers at national and international conferences. Professor Schoeman-Malan received the Teaching Excellence and Innovation Faculty of Law Award in 2014. She previously held a C3 NRF rating and now has a C2 rating

Professor Sharifpur is an associate professor in the Department of Mechanical and Aeronautical Engineering in the Faculty of Engineering, Built Environment and Information Technology.
His research area includes thermal fluid behaviour and the stability of nanofluids, improvement of heat transfer by nanofluids, convective multiphase flow, and computational fluid dynamics. He established the Nanofluid Research Laboratory in 2010, which is the most active and productive nanofluids laboratory in Africa. He is an innovative thinker and in 2016 received funds from the Technology Innovation Agency of South Africa (TIA) to construct an emergency cooling design. In the same year, he published a journal article which offered a new correlation for the density of nanofluids. His research refuted almost all of the previous articles in this field.
Professor Sharifpur has authored or co-authored more than 70 peer-reviewed articles published in accredited journals, as well as international conference papers. At UP, he has acted as supervisor for two post-doctoral researchers, three PhD students, and eight master’s students, all of which have completed their research. In addition, he guided more than 100 undergraduate design and project students.
Professor Sharifpur acts as a reviewer for notable accredited journals and prestigious international conferences. He is registered with the Engineering Council of South Africa as a professional engineer and received a C2 rating from the NRF.
Professor Stegmann is an associate professor of Anaesthesiology in the Department of Companion Animal Clinical Studies, Faculty of Veterinary Science. He is registered as a specialist anaesthetist with the South African Veterinary Board and is a Diplomate of the European College of Veterinary Anaesthetists.
His research interest is veterinary anaesthesia, specifically wildlife immobilisation and anaesthesia. He received a C3 rating from the NRF.

Professor Stevens is an associate professor in criminal law and statutory crimes within the Department of Public Law in the Faculty of Law.
His research focus falls primarily on the conceptual interface between criminal law and mental health law with reference to the defence of criminal incapacity within South African criminal law. Professor Stevens has authored more than 30 peer reviewed articles which appear in either the International Bibliography of the Social Sciences (IBSS), the Web of Science or the Department of Higher Education and Training (DHET) list. Most of these articles are directly linked to his field of research, while some also deal with criminal law as subject field. These research articles have established him as a specialist researcher on law at the interface of criminal law and mental health law. He is currently the editor of the De Jure law journal. He has presented papers at numerous international conferences on topics related to his fields of research. He received the C2 rating from the NRF.

After spending most of his professional career at the South African Nuclear Energy Corporation (Necsa), ending up as its Chief Executive Officer from 1990 to 2001, Professor Stumpf joined his alma mater as Professor of Physical Metallurgy in the Department of Materials Science and Metallurgical Engineering of the Faculty of Engineering, Built Environment and Information Technology at the University of Pretoria. He has spent the 16 years since his appointment pursuing his passion for postgraduate teaching and research on the microstructural development and phase changes in hot working and heat treatments of carbon steels, low-alloy steels and stainless steels, and how these relate to their physical and mechanical properties. During this time, he has also produced 44 ISI-accredited publications and given 41 refereed conference presentations, as well as supervising six master’s and nine PhD students to successful completion of their studies. Professor Stumpf holds a C2 rating from the National Research Foundation.




Professor Sumner is professor in and Head of the Department of Geography, Geoinformatics and Meteorology in the Faculty of Natural and Agricultural Sciences.
As a geomorphologist, Professor Sumner’s research focuses on theoretical aspects of rock weathering and the processes contributing to soil erosion. In particular, his research interrogates the physical aspects of rainfall erosivity and its application to the mountainous areas of both southern Africa and on the island of Mauritius. Such findings enhance the accuracy of erosion models and permit more accurate erosion risk assessments under conditions of changing climate and changing land use. He received a C1 rating from the NRF.
Dr Taylor is a research officer in the Department of Food Science in the Faculty of Natural and Agricultural Sciences.
She undertakes research and development work into the functional properties of plant proteins with specific interest in the prolamin proteins of sorghum and maize. Her research is aimed at increasing the use of these well-adapted locally cultivated grains in foods and food ingredients, thereby improving regional food security and developing local industries. Her areas of expertise are sorghum and maize protein extraction, bioplastics and biomaterials and the development of potential applications and uses for these materials, including their use in encapsulation and gluten-free dough systems. A patent arising from her work was registered in ten countries, two of which are registered in the US. Dr Taylor received a C2 rating from the NRF.
Professor Van den Berg is an associate professor in the Department of Microbiology and Plant Pathology, Faculty of Natural and Agricultural Sciences. She is the principal investigator of the Avocado Research Programme funded by the Hans Merensky Foundation.
Her research is aimed at dissecting the intricate avocado Phytophthora cinnamomi interaction by using next generation sequencing technologies and functional biology. Highlights of her research include publishing the first stress-associated avocado transcriptome in PLosOne, followed by developing an Avocado Microarray Slide containing defence genes. This array was used to investigate the avocado response to P. cinnamomi and to Rosellinia necatrix, a collaborative project with researchers in Spain. Avocado genome data revealed the presence of five NPR1 transcripts and the work was published in Frontiers in Plant Science. Research on P. cinnamomi identified genes associated with virulence, including oomycete specific RxLR effectors.
Professor Van den Berg has published a number of papers in international journals and presented her research at the Plant and Animal Genomics Conference and the World Avocado Conference. She is a member of the Southern African Society of Plant Pathology, South African Association of Botany and the South African Genetics Society. Her research has been supported by the Thuthuka Women in Science and Technology and NRF Human Resources for Industry Programme (THRIP) grants. She received a C2 rating from the NRF.
Professor Van der Waals is an associate professor in the Department of Plant Production and Soil Science. She is the founder and manager of the Potato Pathology Programme @ UP. The primary focus areas of her research group are the detection and monitoring of potato pathogens in South Africa, drafting integrated management strategies and establishing the effects of climate change on diseases. The three diseases they focus on are blackleg, powdery scab and Rhizoctonia. Their research will further the understanding of the biology, epidemiology and spread of the respective pathogens, while providing South African and international growers with advice on sustainable potato production.
At the annual Potatoes South Africa research symposium in July 2015, Professor Van der Waals received the award for Best Researcher Presentation. Early in 2016 she was nominated by Focus on Potato, a web-based resource of the Plant Management Network of the American Phytopathology Society’s editorial committee to record a webcast on blemish diseases in table potatoes. She was an invited keynote speaker at the European Association for Potato Research (EAPR) Pathology and Pests Section Meeting in August 2016 in Scotland. At the Southern African Society for Plant Pathology Congress in January 2017 she received the Applied Plant Pathology Award. She received a C2 rating from the NRF.

Professor Van Heerden is a professor in the Department of Mercantile Law and the current incumbent of the Barclays Africa Chair in Banking Law in Africa.
Her main areas of interest are banking law, consumer credit and general consumer protection law, law of civil procedure and insolvency law. She also has a keen interest in competition law. Her fields of research and expertise are credit law and banking law.
After practising as an attorney for a number of years, Professor Van Heerden was appointed at the former Rand Afrikaans University (now the University of Johannesburg) as lecturer in Law of Civil Procedure in 1995. In 1998 she was promoted to senior lecturer and in 2007 to associate professor. She joined the Department of Mercantile Law at the University of Pretoria as associate professor in January 2009 and was promoted to professor in 2015.
She has presented papers at numerous national conferences and in 2015 presented a paper at the International Association of Consumer Law Conference in Amsterdam, the Netherlands, titled ‘Offering hope in the context of responsible lending: lessons from South Africa regarding best practices’. Professor Van Heerden received a C1 rating from the NRF.

Dr Van Heerden is a senior lecturer in the Department of Veterinary Tropical Diseases in the Faculty of Veterinary Science.
She is a member of research projects in zoonoses, focusing primarily on anthrax and brucellosis. Her research aims to improve the understanding, detection and control of anthrax and brucellosis in wildlife and livestock. This includes the bacteriology, immunology and molecular biology characterisation of brucellosis and anthrax, as well as the epidemiology and the development of vaccines. Future research will also include investigating lytic bacteriophages in the control of pathogens. She received a Thermo Fisher Scientific 2016 Invitrogen Science Hero award in the category Platinum PI. Dr van Heerden received the C3 rating from the NRF.



Professor Van Heerden is professor and Head of the Department of Oral Pathology and Oral Biology in the Faculty of Health Sciences.
His areas of research include the oral manifestations of HIV/AIDS, especially HIV/AIDSassociated malignancies of the head and neck, potentially malignant lesions and oral cancer, high-resolution DNA flow cytometry of solid tumours and diagnostic histopathology of the head and neck.
Professor Van Heerden is a member of the Academy of Science of South Africa, was named one of the University of Pretoria’s 100 leading minds of the 20th century and is a former president of the International Association of Oral Pathologists. He received a C2 rating from the NRF.
Professor Wöcke is a professor at the Gordon Institute of Business Science (GIBS). He teaches in the areas of international business, human resource strategy and strategy.
His research focus is management in emerging markets generally, and in Africa in particular. The business environment in developed economies has changed significantly since the great recession in 2008 and in emerging markets since 2011. In South Africa the business environment has been characterised by tough labour relations, an unstable regulatory environment and social unrest impacting on business operations. This evolving environment is Professor Wöcke’s main area of interest. He published journal articles on the use of social movement methods and perceptions of injustice in union rivalry in the platinum mining industry shortly after the Marikana shootings in 2012. He also analysed the respective corporate political strategies of multinational corporations for dealing with local firms in the South African health and pharmaceutical industries. He recently published a case study on MTN and its fine from the Nigerian government. This case study was co-authored with Professor Paul Beamish of the University of Western Ontario and is included in the top-selling international business textbook.
In 2015 and 2016 Professor Wöcke presented papers at the Academy of International Business (AIB) on the role of language in managing the relations between multinational corporations and government/business after a financial crisis. He will present a paper on multinational corporates (MNCs) and local firms at the annual AIB conference in Dubai in June 2017. Professor Wöcke has a C2 rating from the NRF.

Dr Babalola received the UP Vice-Chancellor Postdoctoral Fellowship at the Centre for Environmental Economics and Policy in Africa (CEEPA) in the Faculty of Natural and Agricultural Sciences from 2012 to 2014. On completion of the fellowship, he became an extraordinary lecturer with the Forest Science postgraduate programme in the same Faculty. Since then, he has been involved in collaborative research, teaching, and supervision of masters and doctoral students. He is also a senior lecturer at the University of Ilorin, Nigeria.
Dr Babalola is a professional forester with specialisation in the socio-economic aspect of forestry. He wrote a book, Nigerian Forestry and National Development, and his research has been published in reputable journals in his field. Dr Babalola has won a number of research grants, among others the Rufford Small Grant, the Tropical Biology Association (TBA) Small Grant, and the British Ecological Society (BES) Outreach Grant. He received a Y2 rating from the NRF.
Dr Badenhorst is a senior lecturer in the Department of Chemical Engineering in the Faculty of EBIT.
His work focuses on developing novel materials for energy applications. This includes the development of high thermal conductivity graphite nanoplatelets and aerogels. These materials allow rapid energy storage and retrieval from phase change materials which hold promise for continuous energy supply from solar resources. His research group is developing carbon black nanospheres for the capture of solar radiation. This technology has recently been applied to the creation of a solar flash-based seawater desalination system. The approach won third place in the 2015 Gauteng Accelerator Program hosted by the Innovation Hub. Apart from renewables, the group also focuses on developing nuclear energy materials. This work builds on a strategic knowledge of synthetic graphite which is used as a moderator and structural component in next generation, passively safe nuclear reactors. The key focus is on understanding the extremely complex material microstructure and relating this to precursor properties. In July 2016 this work was presented as a keynote address at the World Conference on Carbon (Carbon 2016) at Penn State University in the USA. Dr Badenhorst was awarded the prestigious accolade of the Royal Society of South Africa, the Meiring Naudé Medal for 2017. He received a Y2 rating from the NRF.

Dr Duong is a research fellow in the Department of Genetics, Faculty of Natural and Agricultural Sciences. He is a team member of the DST-NRF Centre of Excellence in Tree Health Biotechnology (CTHB) and the Tree Protection Co-operative Programme (TPCP) in the Forestry and Agricultural Biotechnology Institute (FABI).
His research is focused on taxonomy, phylogeny, genetics and genomics of fungi, particularly those residing in Ophiostomatales and Microascales. Dr Duong has published over 30 research papers in peer-reviewed journals and frequently acts as reviewer for a number of international journals. He received a Y1 rating from the NRF.

Dr Grobler is a senior lecturer in the Department of Industrial and Systems Engineering. Her main fields of expertise are multi-method optimisation algorithms, multi-objective and supply chain optimisation, swarm intelligence, and scheduling. She completed her PhD in multi-method algorithms through the Computational Intelligence Research Group at the University of Pretoria and was recently awarded the 2015 JD Roberts Emerging Researcher Award for her contribution to the development of mathematical models and optimisation algorithms.
She regularly reviews papers for leading international journals such as IEEE Transactions on Evolutionary Computation, Swarm Intelligence and the Journal of Scheduling. She acted as the registration co-chair for the Institute of Electrical and Electronics Engineers (IEEE) 2015 Symposium Series in Computational Intelligence and is a member of the IEEE Women in Computational Intelligence sub-committee. Dr Grobler has presented various invited lectures, for example, a tutorial at the 7th International Conference on Swarm Intelligence in Bali, Indonesia (June 2016), and lectures at the Symposium Series on Computational Intelligence in Orlando, USA (December 2014), and the Workshop on Nature-inspired Techniques in Computer Networking at the University of Cyprus (November 2010). She received a Y2 rating from the NRF.


Professor Inglesi-Lotz is an associate professor in the Department of Economics in the Faculty of Economic and Management Sciences.
Her research interests focus on the broader relationship between economics and the energy and the natural environments. She investigates energy topics from a macroeconomic perspective to establish robust theoretical frameworks for energy-related questions while adopting rigorous econometric techniques used in various economic fields but which she brings to bear on energy- and environment-focused questions.
In recognition of her research output, the University of Pretoria awarded her the Exceptional Young Researcher award in 2014. The Department of Economics acknowledged her as Junior Researcher of the Year in 2011, 2013 and 2014. She received a Y1 rating from the NRF.

Dr Kikianty is a lecturer in the Department of Mathematics and Applied Mathematics in the Faculty of Natural and Agricultural Sciences. She completed her PhD at Victoria University in Australia and received the university medal for best doctoral dissertation.
Prior to her appointment at UP, she completed postdoctoral fellowships at Australia’s Information Communications Technology (ICT) Research Centre of Excellence (the National ICT Australia) Victoria Research Lab, Melbourne, the University of the Witwatersrand, and the University of Johannesburg where she was awarded a Claude Leon Postdoctoral Fellowship. Her research areas are in semi-inner product spaces and mathematical inequalities, and focuses on extending geometrical notions defined by the inner product structure to spaces without such a structure, using the machinery of semi-inner products. She is also interested in mathematical inequalities for approximating integrals. Dr Kikianty received a Y2 rating from the NRF.

Dr Krüger is a senior lecturer in the Department of Physics in the Faculty of Natural and Agricultural Sciences.
His research is in molecular biophysics, specifically to resolve, manipulate and control energy and structural dynamics in natural and artificial light-harvesting materials. He uses advanced, unique, home-built experimental setups to perform femtosecond spectroscopy and single-molecule spectroscopy. Niche subjects that are addressed involve quantum biology and bio-solar cells.
In 2014, after one year at UP, he established a new research group that has grown to 11 postgraduate students in 2016 – two postdoctoral, six PhD and three MSc students. Apart from a substantial grant from the prestigious National Equipment Programme in 2014, he managed to obtain 12 additional grants in the last three years with a total value of R4,3 million. In the last three years he has published peer-reviewed research articles with collaborators from 15 different research groups across the world. He received a fellowship from the Freiburg Institute for Advanced Studies. He is chair of the Biophysics Initiative of the South African Institute of Physics and served as a 2016 Tuks Young Research Leader. Dr Krüger received a Y1 rating from the NRF.
Dr Le Roux is a senior lecturer in the Department of Mechanical and Aeronautical Engineering in the Faculty of Engineering, Built Environment and Information Technology.
His research focuses on solar energy conversion where the subjects of thermodynamics and thermal engineering are mostly applied. His main interest is solar dish collector systems, specifically the solar Brayton cycle, where a solar dish is applied to run a turbine in a power generation cycle.
Dr Le Roux completed his PhD in Mechanical Engineering at the University of Pretoria in 2015. He is registered with the Engineering Council of South Africa as a Professional Engineer. He has received outstanding paper awards at the International Green Energy Conference, the International Conference on Heat Transfer, Fluid Mechanics and Thermodynamics as well as the Southern African Solar Energy Conference. He received a Y2 rating from the NRF.

Dr Marais was appointed as lecturer in the Department of Mathematics and Applied Mathematics in the Faculty of Natural and Agricultural Sciences in 2014.
She completed her doctorate at Stellenbosch University under the supervision of Professor L van Wyk in the field of classical algebra. Her involvement with computer algebra and singularity theory started in 2011 when she was appointed as postdoctoral fellow at the African Institute of Mathematical Sciences (AIMS). Since then she has established a close collaboration with the working group ‘Algebra, Geometry and Computer Algebra’ at the University of Kaiserslautern, Germany. This group hosts the main development of Singular, one of the leading computer algebra systems. This collaboration has resulted in various projects involving both theoretical research and the development of software. She received a Y2 rating from the NRF.

Dr Ndlovu is a senior lecturer in Archaeology in the Department of Anthropology and Archaeology in the Faculty of Humanities.
His research focuses mainly on southern African rock art, heritage resources management, and transformation in archaeology. Dr Ndlovu’s research on rock art is focussed on establishing variation in southern African rock art to provide possible alternative interpretations to the art as opposed to the current dominant approach based on shamanism. This research project is in the second year of its three year funding (2016-2018) by the NRF under the African Origins Platform. He has published widely on the management of heritage resources in South Africa, challenging the largely physical paradigm that informs the current management approach. On transforming archaeology, Dr Ndlovu has argued that there is much to be gained by the discipline if archaeologists were to engage in meaningful discussions and projects to transform the science, a discipline largely, and correctly so, still defined as a white subject. Dr Ndlovu was elected Secretary General of the World Archaeological Congress (WAC) during a congress held in Kyoto (Japan) in September 2016, and he will be serving on the WAC Executive for the next three years. He received a Y2 rating from the NRF.


Dr Razafimandimby is a lecturer in the Department of Mathematics and Applied Mathematics in the Faculty of Natural and Agricultural Sciences.
His work concerns the theory of stochastic (partial) differential equations (SPDEs) and is motivated by the need for sound mathematical analysis in order to understand complex phenomena in physics and applied science (such as turbulence) and the stochastic noise effects on complex dynamical systems (for example, the noise effect in the dynamics of liquid crystal). Among his contributions to this research area are systematic studies of parabolic and non-parabolic SPDEs in turbulent fluids, development of the theory of SPDEs driven by Levy noise and SPDEs with Wiener noise in the setting of Banach spaces, and the effect of noise on the approximation of mathematical models of turbulence. From 2013 to 2015 Dr Razafimandimby was the principal investigator of a project on the mathematical study of models of turbulence perturbed by Levy noise, which was funded by the Austrian Science Fund (Fonds zur Förderung der wissenschaftlichen Forschung, FWF) through the prestigious FWF Lise Meitner fellowship. Since 2015 he has been a co-investigator in an FWF stand-alone project that aims to understand the dynamics of nematic liquid crystal with Weiner noise. He received a Y1 rating from the NRF.

Dr Wielenga is a senior researcher at the Centre for the Study of Governance Innovation in the Department of Political Sciences, Faculty of Humanities.
Her research interest is the intersection of formal and informal justice systems during transitions on the African continent. Dr Wielenga has conducted in-depth research on gacaca courts in Rwanda, the Truth and Reconciliation Commission in South Africa, and comparative projects on the informal justice systems in Burundi, Zimbabwe, Mozambique and Namibia. Working collaboratively with teams of postdoctoral fellows and postgraduate students both locally and internationally, Dr Wielenga intends to challenge current policy and practice in the area of transitional justice after mass violence as they fail to reflect the reality on the ground. Through the collection of large scale, comparative, empirical data at community level, Dr Wielenga intends to propose more effective ways of meeting justice needs during transitions. She has been a grant holder, and is a member, of various African networks including the African Peacebuilding Network, the Council for the Development of Social Sciences in Africa and the American Political Science Association Africa programme. She received a Y2 rating from the NRF.

Dr Yusuf is a research fellow at the Social Insects Research Group in the Department of Zoology and Entomology, Faculty of Natural and Agricultural Sciences. He is also a principal investigator with the DST/NRF SARChI Chair in Mathematical Models and Methods in Bioengineering and Biosciences.
A chemical ecologist, he is interested in the behaviour and chemical ecology of social insects (ants, bees and termites). His current research focuses on understanding the physiological, behavioural and genetic basis of pheromone communication and reproductive dominance in honeybees, as well as their population dynamics, colony health and conservation.
In 2015, Dr Yusuf received a Georg Foster Experienced Research Fellowship from the Alexander von Humboldt Foundation to conduct research in honeybee genetics at the Molecular Ecology Research Group, Martin Luther University, Halle-Wittenberg, Germany. Dr Yusuf is a member of the International Society of Chemical Ecology, the Association of African Insect Scientists and the Entomological Society of Southern Africa. He also sits on the Executive Committee of the African Union’s Apiculture Platform (AAP) on Honey Production, Bee Health and Pollination Services. Dr Yusuf received a Y2 rating from the NRF.
The evaluation and rating of individuals is based primarily on the quality of the research outputs of the past eight years (2009-2016) and is undertaken by national and international peers/reviewers.

Portraits in this publication are by Eyescape Studios.
Other photographs were supplied by Professor Rudi van Aarde and Lucinda du Toit Photographic D’Art.
The UP Language Unit is acknowledged for sub-editing and translation services rendered.
Design and layout: Liana Schröder, Department of University Relations
Portrette in hierdie publikasie is geneem deur Eyescape Studios.
Ander foto’s is verskaf deur professor Rudi van Aarde en Lucinda du Toit Photographic D’Art.
Die UP Taaleenheid se redigering en vertalingsdienste word graag erken.
Ontwerp en bladuitleg: Liana Schröder, Departement van Universiteitsbetrekkinge
Diswantšho tše di lego ka phatlalatšong ye ka Phapošikgašo ya Eyescape.
Diswantšho tše dingwe di abilwe ke profesa Rudi van Aardele Lucinda du Toit Photographic D’Art.
Lekala la Dipolelo la UP le amogelwa ka go aba ditirelo tša thulaganyo le phetolelo.
Moakanyetšo le thalo: Liana Schröder, Kgoro ya Dikamo tša Yunibesithi
